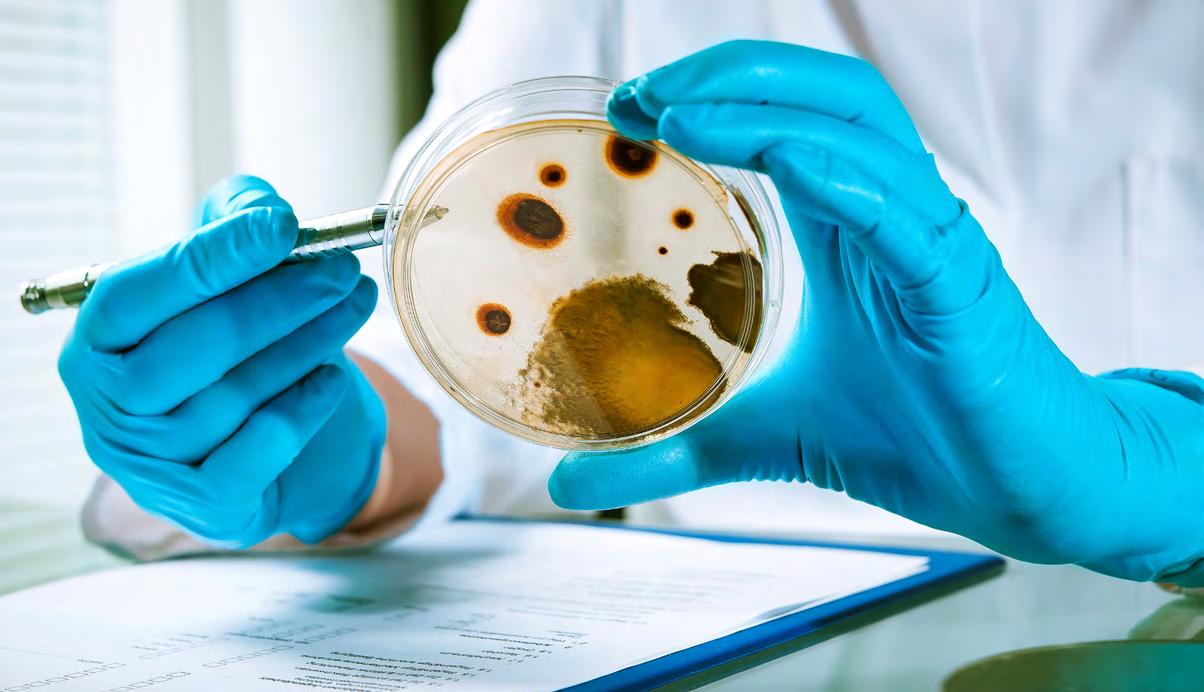

The health sector has been in constant motion this year. One of the most important changes has been the move toward a patient-centric view that all providers are adopting. Healthcare is moving away from its traditionally parental role, empowering patients to take the lead in their health journey. Patient-centricity is also being positioned at the core of solution design and development of products and novel care models.
A patient-centric model is especially valuable for Mexico as one of the country’s largest health burdens is the prevalence of chronic diseases, which could worsen if care gaps are not bridged. To address this, care providers are betting on tech and education, while also developing new financing and reach-out models to enhance health access. As the country faces an 8.6 percent inflation rate, financing and valuebased care access models are becoming fundamental to ensure healthcare access.
Digitalization is embedded in every part of this transformation process. From creating electronic medical records to integrating a health ecosystem, providers are advancing tech developments that enhance continuous access to healthcare and boost care provision. At the same time, entrepreneurs are working toward standardizing innovation and opening up the market to novel solutions that aim to positively impact patients and providers.
Providers are also targeting diagnostic capabilities to prevent diseases from advancing. This focus on prevention, timely detection and intervention is leading hospitals to reconfigure their facilities and services to focus on ambulatory and home-care options that also integrate primary healthcare services.
Mexico Health Review 2022 dives into the transformation process underway at the different providers that make up the healthcare chain, walking alongside them as they rediscover their value proposition.
As the health sector evolves, providers must collaborate to develop a responsive environment that tends to patients’ needs. Public-private collaboration was a key priority during the COVID-19 pandemic but efforts to standardize this practice appear to be fading away.
While providers from both sectors are working toward the same goals, collaboration remains a challenge. Nevertheless, the solutions brought to the table are innovative and demonstrate that everyone is clear on the final goal: the patient.
This chapter will explore the changes introduced by the federal government on the journey toward universal healthcare and the results of these efforts. It will also expose the current initiatives of the sector to digitalize the system and to accelerate access to innovation in Mexico, along with work to strengthen the needed regulation.
Financing also remains a major subject for care providers in Mexico. The country’s expenditure is almost equally divided between out-ofpocket spending and the public budget, with Mexico having the highest private expenditure of all OECD members.



The administration of President Andrés Manuel López Obrador has been marked by a plethora of changes in health processes and regulations. Experts have questioned the clarity and sufficiency of some of these measures to meet the government’s ambitious and transformational goals for the sector.
Among the main projects set by the federal administration was the reform of the Federal Acquisition Law for medicine and medical supplies. All acquisitions of health supplies in Mexico are now handled directly with manufacturers, either through bidding processes or direct sales. The acquisition process was broken down into two parts, with some products acquired directly from manufacturers and others acquired through a contract with the UN Office for Project Services (UNOPS).
UNOPS coordinates a bidding process to boost the number of participants by reaching out to companies that were not operating in Mexico but could offer their products to the Mexican government. In retrospect, diversification was not achieved, says Juan Luis Serrano Leets, Partner of Life Sciences at Sanchez Devanny. “Over 90 percent of the products acquired were bought from the same Mexican companies that have had operations or plants in Mexico for several years,” he explains.
Distribution of medicines has also been a challenge. By July 2022, INSABI, the body in charge of handling this process, had only distributed 40.8 percent of the medicines requested. Performance has been poor since 2019. According to findings from Nosotrxs collective Cero Desabasto, before López Obrador’s administration, the year with the largest number of unfilled prescriptions was 2017, with about 3.5 million. However, unfilled prescriptions started to accumulate after the Acquisition Law was changed. In 2019, unfilled prescriptions climbed to 7.5 million and in 2020 to 18.3 million. 2021 was the worst year so far, with Cero Desabasto reporting 24 million prescriptions went unfulfilled at public health institutions.
“We can see that the results (of the changes to the Acquisition Law) have been frankly bad. The processes carried out by UNOPS have not been positive. Lack of planning has led to these shortages,” says Rafael Gual, Director General of CANIFARMA. “We have an enviable industry in Mexico, with the capacity to supply the entire market,” he adds.
A second large change came with the termination of Seguro Popular as a universal care provider. In its place, INSABI was created to play a similar role. “The decision to eliminate Seguro Popular led to significant changes. Seguro Popular was an insurer that funded health services at all public institutions of the National Health Systems. INSABI, on the other hand, uses a model that is similar to IMSS but its rules are also not very clear,” explains Serrano Leets.
By definition, the purpose of INSABI is to provide and guarantee the free provision of health services, medicines and other
State of the
supplies associated with those who have no social security, as well as to promote, in coordination with the Ministry of Health in its capacity as governing body, actions aimed at achieving an adequate integration and articulation of the public institutions of the National Health System. Earlier this year, the duty of providing universal healthcare was given to IMSS-Bienestar. The latter is a federal government program that is aimed at those who seek free access to medicines and medical care but who do not have social security.
“IMSS-Bienestar is an attractive alternative from a universal health perspective because its functionality is better established than INSABI’s,” says Andrés Castañeda, Health and Wellness Coordinator for Nosotrxs. “But the mechanisms for its services to reach people are still unclear, as is the way its funds will be divided in the provision of healthcare. The future of IMSS-Bienestar’s regular funds, its own projects and its power to redirect patients to other institutions are also in question.”
Through a transparency request to IMSS, Animal Político found that the transition of responsibilities between INSABI and IMSS-Bienestar were applied without a predesigned strategy or evaluation with indicators, deadlines or times. “States were even chosen where governors volunteered to go through this process and were asked to follow a list of steps. However, it is neither necessary to follow these steps in order nor to apply them all,” shares the news outlet.
A third change and current priority for the Mexican health system is resuming care for essential non-related COVID-19 ailments. A study by BMJ Global Health used health data from January 2019 to December 2020 from IMSS to determine the disruption in essential health services in Mexico during COVID-19. Results of the study found that across nine health services, an estimated 8.74 million patient visits were lost in Mexico. This included breast and cervical cancer screenings (79 percent and 68 percent, respectively) and over half of diabetes, hypertension and prenatal care consultations. In terms of patient outcomes, the proportion of patients with diabetes and hypertension with controlled conditions declined by 22 percent and 17 percent, respectively.
To close the care gap brought on by the pandemic, IMSS implemented National Days of Recovery of Ordinary Medical Services, which recently concluded an 11th round and exceeded its service goal, reaching 129 percent. A total of 1.69 million services have been provided, of which 244,117 were specialty consultations, 31,125 were surgeries, 610,120 detections, 749,054 family medicine consultations, 53,509 diagnosis and treatment auxiliary studies and 218 transplants.
Lastly, regulation has also been under the spotlight in 2022. Regarding tech, both among public and private providers, the interest in digitizing the health sector is vast and efforts are starting to permeate the industry. The sector has recently introduced a Digital Health Law initiative to the Chamber of Deputies that “would provide certainty and support the development of digital health solutions in the country,” explains Héctor Valle, Executive President of Funsalud. This law would set the tone for COFEPRIS to quickly respond with regulatory frameworks for this type of innovation in
Q: How does the recently created Council for the Promotion of New Technologies support your commitment to improve the health sector?
A: Funsalud is divided into several promoter councils, each of them with independent strategies that help close access gaps in healthcare. Our councils include Health Attention Quality, Health Universality and Competitiveness, Food and Healthy Habits and Mental Health and Wellness. The Promotion of New Technologies Council aims to analyze existing technologies in healthcare to support their implementation in Mexico and promote health access. The council has identified 10 different technologies reshaping the global health sector and is working to implement them in Mexico. These technologies are digital health, telemedicine, artificial intelligence, virtual reality, augmented reality, blockchain, robotics, drones, 3D printing and genomics.
The council is supporting the Digital Health Law, which is being discussed by the Chamber of Deputies. Its implementation would provide certainty and support the development of digital health solutions in the country.
Q: How does Funsalud measure the penetration of tech in the healthcare sector?
A: Funsalud is working on the “Digital Doctor” project to evaluate how doctors coexist with digitalization and adapt it into their practices, from the apps they use to provide care to the websites they search for guidance. We wish to see the doctor’s perspective to understand how digital health is permeating the sector and whether they are adapting it into their medical practice. This way, we can provide them with the best tools according to their needs.
Funsalud is performing a national study of 15 medical specializations to observe the specific conditions health professionals face in different geographies. The council is also proactively working with the public sector. For example, we are working with the National Cardiology Institute and the government of Chiapas to support telemedicine adoption to effectively and quickly provide attention to patients in need. Similarly, we have a project with the government of Veracruz to use text messages to remind diabetic patients when it is time to take their treatments. The goal is to improve treatment adherence. A similar project was implemented with the Ministry of Health and the Inter-American Development Bank. After its positive results in treatment adherence, we expanded the project to Veracruz and hope to take it to other states in the near future.

Q: For its universal health project, the government is hiring doctors for Mexico’s rural zones. How can this effort fix Mexico’s historic lack of professionals?
A: We need to keep in mind that just like any other professional, doctors are looking for personal and professional development and opportunities in cities align better with those desires. Unfortunately, not many states in Mexico offer these opportunities. Furthermore, about 80 percent of a doctor’s income is acquired through private practice. Nevertheless, it is possible to democratize healthcare and get specialists closer to patients in need through technology, which can connect patients from all parts of the country without the need for extensive transportation.
Héctor Valle ExecutiveQ: What are SMSP’s actions, strategies and plans to strengthen public health in Mexico?
A: One of our most significant tasks has been to fight misinformation during the ongoing COVID-19 pandemic. We have kept in constant communication with media outlets to provide expert opinions and data to inform the public of the pandemic’s ongoing status and epidemiological course.
We also work alongside the Communications Council to spread the word on the value of vaccination and other public health matters regarding diagnosis, preventive care, and healthcare in general. One of our goals is to provide easyto-understand information, limiting the number of scientific terms so that people are less intimidated and less likely to turn to unreliable sources.

Q: How does the SMSP perceive the change from Seguro Popular to INSABI?
A: Planning should be the basis of all change, especially in the health sector. Seguro Popular had a clear operating framework, goals and targets. INSABI on the other hand was developing these targets and frameworks as the change was taking place. This situation does not generate trust in the population and among experts.
Seguro Popular was a financer similar to medical insurance. INSABI is supposed to work similarly but as its framework is unclear, it is still unknown what services it covers. What is clear is that its health services and supplies are lacking.
Another barrier, and not just for INSABI, is the inability of public institutes to communicate with each other. This duplicates expenses for the government as individuals can be beneficiaries of two institutes at once.
Q : What are your efforts on collaborative research projects and what other projects is SMSP working on?
A: We translate clinical research results and scientific evidence into public policy initiatives. We ally with actors from the public and private sector that are seeking to promote the same health agenda.
Read
More
At this moment we are working on different projects, some of them, training for dengue care, a consortium of coagulopathies together with other associations and the social determinants of health for chronic diseases, among others. The latter are research projects to identify the latent needs of the population. Finally, we help states or groups address their needs. For example, we developed a quality certification in Nayarit in conjunction with state officials to retrain and retrain professionals in hospital quality after identifying a skills gap. Also, together with the nurses, we developed a public health certification course to keep them updated. These certifications are competitively priced, making them accessible to more people. We also support campaigns to prevent teenage pregnancy by translating the material into indigenous languages to reach this segment of the population, these are examples of the activities that we develop in the Society.
Sonia López Executive Director | SMSPQ: What are the main results to date of SEDESA’s telemedicine project with the Inter-American Development Bank (IADB)?
A: This project began 1.5 years ago to diagnose the maturity of 115 units among first and second-care level institutions to later implement telemedicine services. The project also lays the groundwork for generating smart hospitals within our network. One of the main objectives of the project is to strengthen the use of the electronic clinical record (ECR), which is the basis for a good telemedicine practice. Without the ECR, the information exchange would be poor for telemedicine. The ECR will later allow us to use new platforms and many other projects.
The project is focusing on remote hospitals, such as the Topilejo Hospital, located in the south of Mexico City. In this hospital, we have limited resources for every specialty, so using telemedicine patients can have teleassistance with our network of specialists. So patients do not move from one hospital to another. To do so, we will train a certain number of specialists; the goal is not to have all specialties available at once but to begin with the most urgent ones. To begin the integration, we carried out an intensive study of the hospital’s areas of opportunity. One was the ECR, which we are improving so it can connect with the telemedicine project.
We use the statistics generated by each hospital to identify necessary improvements. To determine a project’s success, we made a survey of each area of the hospital to analyze the staff’s perception and adoption of tech. Through these means, we found that some hospitals were already using certain telemedicine platforms and even had processes for each specialty.
Q: How does the coordination determine what projects are adequate to the population’s needs?
A: We are an attractive institution due to the size of Mexico City’s population. For that reason, academic institutions and companies often reach out to us to collaborate. We will soon begin a project with a pharmaceutical company to detect lung cancer and another to diagnose cardio-renal diseases in hypertensive and diabetic patients. We also have another project to monitor patients with asthma or chronic obstructive pulmonary disease (EPOC). This project uses IA tech to detect patterns and allow for a more accurate diagnosis of those patients.
We are also inviting and integrating academia into existing or new projects. As a newly created coordination, this is an area yet to be explored but we have some projects already in mind. For example, in La Pastora Hospital, we would like to introduce virtual surgery rooms for students and other activities with medical simulators that would allow the hospital to provide continuous education to medical professionals. This hospital is still fully focused on COVID-19, which has delayed this project.
Q: What collaborations do you have with the federal Ministry of Health?
A: We had one project with the INCMNSZ where we studied the effects of Remdesivir in patients with COVID-19, in which we found it had positive results regarding hospital stay and oxygen consumption. Other national institutes participated in this study, allowing us to also study the effectiveness of Baricitinib.
 Diego Pelz
Coordinator of Liaison and Academic Projects | SEDESA
Diego Pelz
Coordinator of Liaison and Academic Projects | SEDESA
The COVID-19 pandemic highlighted the importance of the pharmaceutical industry. The disruption of supply chains, particularly those related to chemical intermediates, active principle ingredients (APIs) and medicines, generated acute crises in many countries.
The crisis nevertheless emphasized the need to strengthen the pharma sector so as to reduce dependency on foreign sources. Thus, a number of developmental policies and even protectionist measures were adopted. For example, in the US, our most important commerce and trade partner, President Joe Biden issued a declaration to boost the development of the USMCA (formerly NAFTA) regional industry, both in the supply of medicines as well as of active principles and medical devices. Along the same line, considering the consequential complexities that global logistics operations faced from the container crisis, nearshoring was identified as a strategic policy.
Mexico’s pharmaceutical industry plays a relevant social role as a supplier of critical products that improve and maintain the health of the population, as well as a prominent economic role because of its interdependence with several other industries —chemical, packaging, glass — and the enormous technological spillover it produces. In fact, in September 2018, the pharmaceutical industry in our country was declared “strategic and a priority” by both the Ministry of Health and the Ministry of Economy.

The shortage of health supplies experienced since 2019 is not imputable to the industry but to the lack of planning, coordination, and timely execution of procurement processes on the part of the government. Even so, the pharmaceutical industry has duly attended the call for bids issued by UNOPS for the 2021 and 2022 supply. Even though these have been open international processes, which is contrary to the Law of Acquisitions, Leases and Services of the Public Sector (LAASSP), the percentage allocated to companies established in Mexico exceeds 93 percent. As for the private sector, the industry maintained the supply of medicines without interruption during the pandemic, despite facing an increase in demand that had not been observed for a decade.
In terms of economic importance, according to figures from the III Statistical Compendium published by CANIFARMA in 2018, the pharmaceutical industry in Mexico generates 100,000 direct and close to 600,000 indirect jobs, with an approximate market value of close to US$14 billion. The industry is related to 161 out of 259 industrial sectors, which makes it a major economic driver. The estimated annual investment in our country surpasses MX$40 billion (US$2 billion) and is destined to plant modernization, technological upgrading and clinical research. The pharmaceutical industry in Mexico is the most important in Latin America in terms of manufacturing facilities, increasing its exports every year to Central and South American countries, with an approximate value of US$2 billion, thanks to its quality and competitiveness.
The Mexican pharmaceutical industry is strategic, a priority and a preeminent asset for the country. Still, the country appears to prefer to look abroad for the solution to the problems of supply, so far without success. Mexico has a highly competitive, capable, and committed pharmaceutical industry that can guarantee sufficient and timely availability of quality medicines and health supplies to cover the domestic demand, without having to depend on foreign suppliers.
Innovation only makes sense when it reaches people. That is why, I mean that the years of research and development, financial resources, and sleepless nights of hundreds of people who dedicate their lives to science and clinical research are only rewarded if we can offer solutions to meet the unmet healthcare needs of the Mexican population. Our industry directly affects people’s lives by changing the landscape of multiple diseases and achieving cures for many others. The products that AMIIF members research and develop change lives, just as our economic and social contributions have the power to change a nation.
To highlight the crucial role of innovation in medical progress and its contributions to society, we held the Seventh Annual AMIIF Innovation Week Edition on April 26-28, 2022. The event, Transformation of the healthcare sector: Pharmaceutical Industry Contributions, gathered leaders and representatives of the pharma world, decision-makers related to public health policies, and leading medical professionals.
During the three day-event, panels hosted discussions on matters of significant importance to public health in Mexico, including non-communicable diseases (NCDs) and gender, which served as the perfect setting for the National Institute of Public Health (INSP) to present its research project in collaboration with the George Institute of Australia, sponsored by AMIIF, on the Economic and health Impact of NCDs on Women in Mexico.
One of the most important objectives of this study, which will be conducted over the next 18 months, is to complete an in-depth analysis of the economic and health burden of NCDs from a gender perspective, as part of a strategy to mitigate health inequalities and, as its ultimate goal, contribute to designing public policy and gender-sensitive programs aimed at improving health conditions.
Regulatory proceedings are a key element to improve public health and it is precisely in this area that our country requires vast improvement in terms of the period required for the health authorities to approve medications. The approval of innovative pharmaceutical products takes 4.3 years from the moment an application is filed, which is two years more than in Brazil and four years more than in the US. That delay causes terrible pain for patients who could receive benefits from these medications in terms of improved health and quality of life.
International Harmonization and Regulatory Reliance, experts highlighted the recent accession of Mexico as a member country of the International Council for Harmonization of Technical Requirements for Pharmaceuticals for Human Use (ICH), since the guidelines under that international body call for collaborative participation between health authorities (such as COFEPRIS) and stakeholders. Panelists emphasized the value of recognizing the marketing authorizations granted by health authorities from other countries as evidence that a pharmaceutical product is safe and effective for Mexican patients. Measures in that sense would help for the early access of new medicines in the Mexican territory.
Intellectual property (IP) is another key issue to ensure Mexico’s progress in healthcare and in all other industries. IP is a key factor in creating an innovative healthcare environment to improve people’s well-being. The medical advances promoted through

intellectual property rights in the 20th century have indisputably improved life quality and expectancy.
In the panel addressing intellectual property as an influencing innovation factor, a group of global experts provided a precise overview of the value derived from the appropriate protection of intellectual property rights. An interesting fact reported by the International Federation of Pharmaceutical Manufacturers & Associations (IFPMA) was that, through the pandemic, intellectual property rights allowed for voluntary technology transfers and partnerships that resulted in the production of more than 13 billion doses of vaccines around the world.
There have also been 371 collaborations in the manufacturing of vaccines and 155 collaborative efforts for treatments as well as multiple announcements of partnerships to improve the geographic diversity of vaccine production.
Beyond the challenge posed by the pandemic, one of the sustainable development goals for 2030 is related to good health and well-being. Innovation in the pharmaceutical industry is crucial to achieving such a goal. That involves multiple fields of technology, ranging from software development to biotechnology and even artificial intelligence. The protection of these kinds of inventions ends up in the early access to pharmaceutical benefits for more people.
Intellectual property protection is not limited to pharmaceutical products and processes but covers any field of science and technology. As such, it demands a legal regime to ensure an appropriate and efficient patent system and provide certainty for the innovation ecosystem as a whole.
The major health benefits cannot be achieved without innovation and innovation does not exist without protection for intellectual property rights. According to the Mexican Institute of Industrial Property (IMPI), between 2018 and 2021, 25 percent of patent applications filed in Mexico were for inventions in health-related sectors, such as medical technology and pharmaceutical products. Furthermore, IMPI reported that 16 percent of the patents filed by Mexicans are related to health-related inventions. That percentage is higher than the general average, which is around 5 percent.
On the other hand, the adequate protection of innovation through intellectual property rights is essential to honor international obligations coming from free trade agreements, such as the USMCA and WTO commitments. In this sense, the Federal Intellectual Property Law, enacted in November 2021, implemented new legal concepts, improved certain proceedings, reinforced IMPI’s protection powers, and adopted alternative dispute resolution mechanisms.
Currently, IMPI is drafting the new secondary regulation of the Federal Intellectual Property Law, which introduces the possibility of adopting an intellectual property system with the highest international standards. An achievement like that would significantly improve the environment to foster investment in the pharmaceutical field for the benefit of the national economy and, especially, of public health. However, if the secondary regulation fails to implement Mexico’s obligations under USMCAand CPTPP, it could seriously damage the country’s image as an intellectual property leader in Latin America.
Access to healthcare in Mexico is often compromised by geographic, financial and accessibility barriers that jeopardize patient outcomes as well as their economies and that of the entire health system. While the current government’s focus is on health universality, expenditure and planning have been insufficient to achieve this goal.
Julio Frenk, Former Minister of Health and Founder, Seguro Popular, argues that IMSS-Bienestar might limit itself to ambulatory services and general hospitalization as its infrastructure is insufficient to meet the demand for other services. In 2020, infrastructure represented 3,622 beds and 80 second-level rural hospitals. IMSS-Bienestar has the lowest attention rate out of all health systems and it dropped even lower due to the pandemic, said the Center of Economic and Budget Education (CIEP).
Uncertainty has become a constant in the current health system that has permeated medicine acquisition processes, care provision through INSABI and financing of infrastructure projects that this sector would need to offer the universal quality service it promises. The health budget for 2022 is of US$38 billion, an over US$5 billion increase against 2021. Nonetheless, to make a palpable impact on the sector, this change would have to be permanent, according to Javier Marín, Senior Director of Healthcare Americas, LLYC.
Deficiencies in public health provision have led to an increase in the provision of private health services, out-of-pocket expenditure and novel financing options for different levels of care. According to the Ministry of Finance, out-of-pocket spending represented 42.1 percent of the total spending on health in 2019, while in 2020 it shot up to 49.4 percent. Out-of-pocket spending in Mexico more than doubled the average of the member countries of the OECD, which stands at 22.7 percent. This reflects Mexico’s performance in the OECD Health at a Glance report, where the population’s satisfaction regarding health services is among the lowest (48 percent) compared to other member countries.
There are many obstacles to universal health coverage and effective public/private health financing. An analysis by the European Observatory on Health Systems and Policies found that the fragmentation of coverage is due to an uncoordinated response with the private sector to increase the satisfaction and capacity of the public sector, coupled with an absence of a referral system based on primary care. Moreover, the analysis suggests that while interstate patient flows have been improving among the non-insured since 2000, labor rotation is high across the formal and informal sectors, erecting artificial barriers to health service access and leading to low levels of continuity of care.
Proposals to reverse the scenario are coming from both the private and public sectors. While criticism against IMSS-Bienestar has been vocal, efforts from IMSS to strengthen the program are already in place through a program dubbed the “Wellness Health Plan.” This encompasses medicine distribution, public tenders for medicine and medical device acquisition and recruitment of medical and nursing professionals.
Judith Méndez
Health and Public Finance Coordinator | CIEP
Sonia López Executive Director | SMSP

Javier Marín
Director Senior Healthcare Americas | LLYC
Andrés González-Silén
Executive Chairman and Co-Founder | Asistensi

Health and Wellness Coordinator | Nosotrxs
Health financing plays a fundamental role in the provision of health services and while it is not the only determinant factor, it is the first step in the universalization of care provision. However, public health models need to evolve to make the most out of public finances, industry experts say.
Financing in healthcare must consider the number of people active in the system and the services they have access to, explains Judith Méndez, Health and Public Finance Coordinator, CIEP. The sector has been suffering from evident inequality between subsystems for a long time due to its fragmentation. For example, PEMEX’s affiliates have access to health services valued at over MS$20,000 (US$991.4), including aesthetic and cosmetic surgeries, while those affiliated with IMSS-Bienestar have an average expenditure of MX$2,000 (US$99.1), explains Méndez.
IMSS-Bienestar has recently become the official provider of healthcare for those without social security. “IMSS-Bienestar is a primary care model for rural communities, which is very different from what PEMEX offers,” says Sonia López, Executive Director, SMSP. “However, individuals do not know what they have access to and how much they have to pay for services under this new scheme.” The Mexican health sector offers unequal coverage and services. “The current system treats Mexicans as first, second and third class, which is unacceptable,” says Andrés Castañeda, Health and Wellness Coordinator, Nosotrxs. “A good first step to improve equity is the recentralization of subsystems. This could put the quality, infrastructure and services on equal ground,” says Castañeda.
Another signal of the system’s inability to meet the population’s needs is the increased use of private services. Similarly, physicians are preferring to work in pharmacy-adjacent medical offices than in primary care clinics, says Castañeda. “The question here is how to create a better environment that offers dignified opportunities to medical professionals and that responds to the population’s actual needs,” he adds.
Read
“Pharmacy-adjacent medical offices are responding to the needs unmet by public services. However, more regulation is then necessary to guarantee their quality,” says Javier Marín, Senior Director of Healthcare Americas, LLYC. In the private sector, providers are increasingly relying on tech to increase access. “Tech has actually been an ally for the private sector to offer accessible, quality services for those in need,” says Andrés González-Silen, Executive President, Asistensi.
Q: What are the main shifts made by the federal administration regarding the acquisition of medicines in the public health sector?
A: This federal administration has implemented more substantial changes than any other administration in recent memory. These changes have focused on two main areas: the provision and acquisition of supplies and the provision of health services. The first change was the decision to no longer work with distributors. All acquisitions of health supplies in Mexico are now made directly with manufacturers, either through bidding processes or direct sales. Before the change, those who participated in tenders were usually distributors, which were in charge of supplying hospitals, warehouses or distribution centers, as well as of collecting payment from the public sector for these procurement contracts. Now, the pharmaceutical industry is no longer working directly with distributors.
The acquisition process was separated into two. Some products would be acquired directly from manufacturers, while others would be acquired through a contract with the UNOPS. This office coordinates a bidding process to boost the number of participants by reaching out to companies that were not operating in Mexico but could offer their products to the Mexican government. In retrospect, the goal was not achieved. Over 90 percent of the products acquired were bought from the same Mexican companies that have had operations or plants in Mexico for several years.

Q: How is medicine and supply distribution expected to change as INSABI assumes a new role in the system?
A: The reorganization has not been clear. The only way to achieve clarity is through regulations, laws or rules because it is the way our legal system provides transparency to the patient, letting them know which benefits they are entitled to. Each administrative reorganization causes changes and problems, generating delays in patient care on a daily basis.
Another problem involves patients filing lawsuits when denied medications that have either been approved by COFEPRIS or not been approved by the institution but have been approved by foreign regulators. In these cases, the judiciary has issued contradictory statements regarding the human right to health and the capacity of the state to provide any approved medicine to patients in the public health system.
Q: How has COFEPRIS adopted these recent changes?
A: The commission should ideally approve the drugs/devices that prove to be safe and effective in the most efficient and least bureaucratic way possible, undergoing the greatest controls allowed by law to correct any situation that may generate a health risk. In an ideal scenario, the authority would be efficient and fast on approvals, engaging in continuous communication with the industry, patient associations and other important players. However, there have been significant delays in drug approval processes in the country as a result of several administrative changes in the operation of the commission. Just this year, COFEPRIS has undergone several personnel changes. The delays have given rise to accusations of corruption within the agency, which further delays COFEPRIS’ operations, generating a bottleneck that only harms the population.
Juan Luis Serrano Partner Life Sciences | Sánchez DevannyQ: LLYC was recognized as the Best Communications Consultancy in Mexico in 2020 and 2019. How did its work with the health sector contribute to this achievement?
A: The agency is highly specialized in the health sector thanks to its team of experts who have worked in the local health system for years, acquiring in-depth knowledge and experience. This expertise allows us to offer the best solutions to our clients, whether they are pharmaceutical companies, in areas of research and data dissemination, launching a new product or vaccines, corporate positioning and also government relations, access and digital communications but in addition to pharma we have worked with medical devices and diagnostic companies and even hospitals and patient groups. Our integral communications solutions in this sector represented a growth of over 60 percent compared LLYC’s global growth in the healthcare practice in 2021. In the Latin American region, it represented over 40 percent.
Q: How is Mexico integrating emerging trends into its system to generate better health outcomes?
A: To fully integrate these trends, Mexico has to overcome the challenge posed by the low public expenditure on healthcare. The COVID-19 pandemic did increase the sector’s budget and put health in the spotlight of the public, private and even social agenda. The challenge now is to make this change permanent.
Mexico is facing a chronic disease emergency that requires the same level of attention and investment as the COVID-19 pandemic. The pandemic taught us that the sector has the capacity to adapt but it needs better health infrastructure and equipment and must adopt tech into its regular practices. It also introduced several changes, including an increase in the health sector’s budget, that led the number of hospital beds to grow seven times and the number of beds with ventilators to grow 6.5 times. Nonetheless, the system still needs to evolve from a curative system to a preventive system that cuts costs by reducing health emergencies.
The migration to a preventive model will likely be based on technology. Digitalization is another challenge that Mexico must address as soon as possible. Tech is not the future; tech is the present. It is the tool that is improving health provision and quality. Some efforts are being made to migrate and interconnect the system but they are limited.
Q: How ready is the Mexican health system to adopt digitalization?
A: Mexico needs to adopt technology based on interconnectivity but this is not happening. The country is not developing a general policy to create a healthtech ecosystem where public and private entities work together. Both sectors must actively want this collaboration for the sector to become sustainable but they are working separately.

Read
More
The WHO led a global initiative so member states could integrate new technologies and digitalize their data systems. The organization identified that remote consultations and monitoring are required to improve the sector and democratize access. The key to this initiative is data collection and its importance to developing better health solutions. In this regard, Mexico still has a great deal of room to grow because the country depends on political will and cultural acceptance to overcome the challenge.
Javier Marín Senior Director Healthcare Americas | LLYCQ: In its Health Care Sector Outlook 2022, Deloitte identified six global issues essential to designing resilient health systems. How is Mexico doing in regard to these global trends?
A: Health equity is one of the most urgent areas to address. It requires the right infrastructure for people to treat their illnesses, as well as digitalization. Both the public and the private sectors have initiatives to achieve health equity. For example, IMSS-Bienestar aims to provide universal healthcare through its infrastructure in each state.
To achieve health equity is to reimagine public health policy but these changes are already happening. For example, the public and private health sectors worked together in an unprecedented manner during the pandemic, enhancing their capacity to provide care by using the infrastructure available at private hospitals.
Two other initiatives supporting health equity are in the Chamber of Deputies. The first concerns electronic prescriptions to complement telemedicine. Electronic prescriptions could allow care providers to reach the patient, instead of the patient being the one seeking the service. The second initiative aims to solve the medicine shortage. This is a database in which providers would integrate their processes into a single platform that would automatically forecast demand and costs months in advance. This platform also aims to standardize payments for drug manufacturers and simplify the documentation process. The interconnected system would, ideally, simplify demand generation, budgets, use and delivery of resources and final payments. The initiatives are inviting healthcare players to join a united ecosystem based on digitalization. Actors in Mexico are already learning how they can ally and add to a united health system.
Q: What is the logical pathway for providers to move forward in an integrated health system?
A: The first step could be the implementation of an ECR, which would empower patients and lead providers to use common processes. Interoperability also offers benefits, such as complete visibility of a patient’s journey, health status and history, saving time and resources for the health system.
This is an enormous challenge because it involves the development of a platform that holds a large amount of data, is friendly to both user and doctor and foments engagement between the two. It also requires constant updates that would ideally come from healthcare providers.
Q: From the viewpoint of regulation, how is Mexico responding to new interoperability processes?
A: Mexico is aware of the importance and challenges of regulating these processes, making it essential to identify the correct pathway to integration. Uruguay, for example, successfully implemented interoperability in its health system but it took time. The country began with hospitals and then moved to other care providers until the entire ecosystem was fully integrated. Uruguay’s interconnected clinical record has saved resources for the system. Something similar is happening in Colombia, which is establishing interoperability as a core of its health system and forcing providers to begin transitioning. Private sector associations can also support the transition but they need a large user base.
 Alexandro Arias
Partner and Life Sciences and Healthcare Leader | Deloitte
Alexandro Arias
Partner and Life Sciences and Healthcare Leader | Deloitte
Q: How is Nosotrxs increasing awareness and helping address issues in the health sector?
A: To expose medicine shortages, Cero Desabasto created a Web App in which patients, doctors and medical professionals can report medicine and supply shortages at their medical centers. Our team validates this information and we then send it to the federal and local authorities.

The government’s role is to secure access to healthcare and we want to support them in this journey by providing this information. This data is also used to generate quarterly and yearly reports.
We also generate reports for every social security institution and we are working on an INSABI and IMSS-Bienestar report due to their role as universal health providers. We want to showcase budgets, responsibilities, capacities and other indicators that will allow society to have a clear picture of an organization.
Alongside the UN Development Program (UNDP), we generated three proposals for the public health sector, including the Mexican Observatory of Access to Medicines and Devices for Health. This proposal was created with the support of Universidad Nacional Autónoma de México (UNAM), Colegio de México (COLMEX), INSP and Universidad de Guadalajara (UDG). We are working with these institutions to generate a space for dialogue where all sectors can meet and discuss universal healthcare access.
Q: How will the change from INSABI to IMSS-Bienestar help alleviate the current medicine shortage?
A: Uncertainty in acquisition processes is at the root of medicine shortages. While the old medicine acquisition process did have flaws, it allowed more actors to participate and had clear procedures. These procedures often led to late payments to suppliers, a problem that the new process tried to avoid by modifying the Acquisitions Law to allow UNOPS to mediate tenders and pay suppliers. But this has not happened.
It is unclear how IMSS-Bienestar will manage demand and what role INSABI will play in the transfer of resources. However, IMSS-Bienestar is an attractive alternative from a universal health perspective because its functionality is better established than INSABI’s. But the mechanisms for its services to reach people are still unclear, as is the way its funds will be divided in the provision of healthcare. The future of IMSSBienestar’s regular funds, its own projects and its power to redirect patients to other institutions are also in question.
One of the most concerning problems is the neglect of public health programs in Mexico as good initiatives were paused to achieve the universal care project, which has been unsuccessful so far and caused medicine and supply shortages.
Unilateral decision-making has been dominating Mexican public health, leading to poor results and severe repercussions for patient health, which will cause long-term problems for the system.
Q: How has health grown to be one of CIEP’s core areas of focus?
A: We have been working in the health arena for a little over 10 years. It has always been one of our priority areas but since 2015, we started to develop much more in-depth research, mainly due to structure, demographic changes and, eventually, the COVID-19 pandemic. We have obtained amazing results since the beginning, especially considering the kind of budget that is allocated to the industry at the international level and within the company.
Q: How can CIEP’s research positively influence decision-making in the Mexican health sector?

A: We seek to reach two main audiences: decision-makers and the general population. We try to be included in public discussions to present our findings, like in Open Parliament. Thanks to our presence in these forums, we have also benefited from media coverage, which is key to disseminating this information among the general population. We also publish infographics or microsites for the latter group, designed to present clear and simple information in the form of images, infographics or videos.
Q: Mexico’s health system is systematically fragmented. How much does this influence the smart use of health resources?
A: A fragmented system is not necessarily a bad thing, as long as the different subsystems communicate with each other and work toward economies of scale. This is not the case, however, in Mexico. Inequality is rampant among the different systems and even the allocation of resources per capita is different. This leads to significant inefficiency. For example, PEMEX has a per capita expenditure of around MX$20,000 (US$987). IMSS-Bienestar has a 10th of that budget.
Q: What are the main differences between theoretical coverage and effective coverage established by CIEP?
A: Theoretical coverage is the concept of universal health coverage based on three dimensions: affiliated population, budget and services provided and physical and human capacity. In theory, the health system would give the entire population the services they require as well as the economic resources they need. However, this coverage model is Utopian. It is almost impossible to obtain due to the natural limitations of the system.
Health system coverage can be measured through the rate of care, which refers to the percentage of the population that received medical attention when they need it. From 2018 to 2020, it dropped from 40 percent to 30 percent, meaning that only three out of every 10 people affiliated to the public health system were able to receive care when they needed it.
Q: Mexico’s private expenditure in healthcare almost equals public expenditure. How does this issue affect the population?
A: By monitoring public expenditure we can understand how a reduction affects a household’s out-of-pocket spending. Private expenditure in healthcare increased by 40 percent due to the decrease of public services, which has a much greater impact on lower-income households. The decrease in public expenditure impacts out-of-pocket expenses and the health of citizens, putting their lives at risk when they do not have access to these resources.
Judith MéndezPharmaceutical Sector to Grow, Focus on Chronic Diseases 0 8/31/2022
Mexico’s Economy to Continue Growing in 2022, 2023 0 9/01/2022
IMSS-Bienestar Is Officially Constituted 0 9/01/2022
Cannabis: Reimagining Personalized Medicine Erick Ponce President | GPIC
Financial Crises 101 by a Dot-Com Bubble Survivor G uillermo Pepe CEO | Mamotest 15 Years That Changed My Life and an Entire Industry Raúl Elizalde Garza CEO | HempMeds
Opportunities Abound for Integral Medical Tourism in Mexico

G abriela Clavel CEO | Abeile Med
INSABI Spent 15 Percent Less Between January and May 2022 07/19/2022
CONACYT, INSP to Strengthen Research in Public Health 07/15/2022
A Look Into the Future of Healthcare in Mexico Alex Ruiz Bernal Health Global Head | Multiplica

The sector is exploring how leaders are making the most out of tech by developing novel direct-to-patient or direct-to-provider solutions that aim to create a cost-effective care provision model that empowers patients in their health journey.
In this chapter, tech developers and adopters explain the needs and importance of having a regulatory framework that allows competitiveness and guarantees patient safety. One of the most relevant steps in this regard is the Digital Health Law, which is being discussed in the Chamber of Deputies with high expectations for approval.
While this matter is being resolved, others are emerging.. With mass quantities of data being generated through devices and software, health-related big data is taking a prominent role, as is its ownership. Health is now part of a virtual universe that will soon be disputing data ownership between many different actors.

As populations around the world age and new diseases emerge, interoperability and data sharing are becoming increasingly critical for delivering effective healthcare. These tools are already promoting closer collaboration among industry stakeholders, while new companies promise to bring new technologies to the market.
The immediate benefits of interoperability include coordination, higher performance and better experiences for providers and patients, according to IBM. With access to data, clinicians have an easier time accessing a patient’s most important health information, leading to fewer repeat tests, preventing inadvertent treatment interactions and reducing miscommunications. “Interoperability makes it possible for organizations to study data trends, past performance and to make data-driven improvements in patient care and other areas,” says IBM.
As the primary goal is to integrate the entire health system, the benefits go beyond immediate patient outcomes. Interoperability, explained by IBM, aims to give visibility to health plans for better resource utilization, provide data to determine health trends, leverage robust data based on research and reduce the amount of redundant administrative work for a more satisfying experience both for employees and patients.
Health data has its own management guidelines to make the most of information, ensure data protection and avoid breaches when sorting the information. Health data, by nature, “has always been challenging to access and share securely. It is difficult to share because it is sensitive and requires a high level of privacy and security, yet the inability to access it when it is needed has the potential to cause significant harm,” explains IBM.
To date, the most common example of health data management systems and the first step to interoperability are Electronic Health Records (EHR), which compile data from multiple sources into one central hub for a comprehensive view of the patient’s history. EHRs provide patient documentation in a digital format, thus allowing providers to record and store patient information in a centralized location and securely share that information with other caregivers.
For data from EHR and other sources to be correctly utilized by providers and patients, Javier Jiménez, Vice President Latam and Government, Health Gorilla, says that regulations are needed. “We need to obtain the governance, data-usage agreements and trust of each participant in interconnectivity processes.” According to Jimenez, technology is not a big barrier as long as we are dealing with standards like Health Level Seven (HL7), an international standard for the transfer of clinical data. Penetration of such practices is still lacking, however. “While it is a standard, not every hospital or laboratory has the same internal resources and processes, so we need to determine where the data is and how to exchange it,” he says.
Monterrey Leader | Hacking Health


Jesús Hernández
Founder and CEO | WeeCompany
Víctor Medina President | HL7
Co-Founder | Orange Box
Interoperability uses technology to exchange information for the improvement of different sectors. In healthcare, it can transform the patient’s experience, provide continuity in medical care, reduce costs and integrate health systems. Although efforts have been made in Mexico to leverage interoperability, the lack of a solid legal framework and technological preparedness is hampering its adoption within the health sector.
“Interoperability can guarantee sectorial co-participation between the public and private sectors, which would guarantee the improvement of patient care and break segmentation paradigms. This would help improve the quality and safety of patient care throughout their life,” says Agustín López, Business Development Director, Dedalus.
This concept goes beyond legal and technology issues as interoperability in the health system does not have a technological objective; it mainly seeks to improve health services. “Establishing the technology is not enough; it requires will, budget, cooperation agreements, the establishment of networks and the provision of specific services,” says José Arriaga, Co-Founder, Orange Box.
Interoperability can also improve the continuity of attention within the Mexican health system. Due to the system’s fragmentation, patient data does not travel with the patient. The duplication of data across hospitals involves added costs and reduces efficiency.
Despite the multiple benefits that connectivity can provide the health sector, there are also risks. Being part of a connected world makes systems vulnerable to cyberattacks. “Before, cybersecurity was not thought of. But when attacks increased, this issue began to be taken more seriously,” says Victor Medina, President, HL7. “Health handles very sensitive data. Security has a cost because it entails constant updates as every week a new cybersecurity threat arises,” adds Jesús Hernández, Founder and CEO, WeeCompany.
The Mexican Official Standard NOM-024-SSA3-2010 establishes the functional objectives and functionalities that the Electronic Clinical Record Systems must observe to guarantee interoperability, processing, interpretation, confidentiality, security and use of information standards and catalogs of electronic health records. However, this norm has not been updated since 2010. “A standard must be defined for all systems in the country with a national digital health strategy. As long as we do not have a guideline that establishes obligations and has consequences, we will continue to have gaps in information security at any level but, above all, in health,” says Medina.
Agustín López Business Development Manager | Dedalus
Q: Why is insurtech the core business of WeeCompany’s health ecosystem?
A: WeeCompany responds to the many inefficiencies found in the traditional insurance and health sectors, some related to the use of paper and bureaucratic processes that produce a bad outcome for cost containment and user experience for the customers. In 2018, aside from facilitating processes for traditional insurers, we dabbled in the creation and development of a health ecosystem. We directly linked insurers with medicine distributors rather than through a traditional pharmacy chain, allowing insurers to reduce costs in the value chain. Most importantly, we are transforming traditional companies and connecting them to a hyperconnected digital health ecosystem that simplifies and automates collaboration, allowing a better user experience for the incumbents involved, especially the patients.
WeeCompany is the first digital health ecosystem that provides insured patients a unique electronic medical record (EMR) and portability for access to doctors, laboratories, pharmacies, and hospitals while automating the validation process with the insurer to easily determine the type of coverage the patient has. This model helped us create a new user experience in the industry, it provides intuitive self-service tools like directories, video consultations, appointments, claims, renewals and access to over 6,000 pharmacies, 1,100 laboratories and 105 hospitals.
We are now working towards a health network for the majority of the population in the region that lack insurance coverage and need to access health services through their budget. This out-of-pocket expenses solution involves a synergetic alliance with the largest pharmacy and laboratory chains in Mexico. Patients will be able to access several services and their electronic medical record (EMR) through their smartphones under a transactional business model.
Q: What are the main lessons WeeCompany learned as it digitized this broad range of services?
A: While digitizing these companies, we realized that not many providers were ready to take the next step. Problems included moving physical catalogs online and standardizing nomenclature for products and services. These gaps led us to get involved in the creation of the Mexican HealthTech Association (AHM), which aims to integrate and align companies to international HealthTech standards that will facilitate collaboration and the creation of an interconnected health ecosystem. The association is growing and has over 100 members.

We always encourage companies to have a head of digital transformation in their companies to facilitate the transition. Digitalization is a must investment that will keep their business competitive in the current market.
Q: What unique benefits does the WeeCompany ecosystem offer to joining partners?
A: Our main benefits are towards a better user experience for the patients, similar to other industries that were disrupted. Also, costs optimization through automation, cost containment tools and transparency. State governments are noticing these benefits. We are working with a state government to modernize its service and foment transparency of prices, care and access.
JesúsQ: How is DOC24 democratizing health access through tech?
A: Democratizing health access is the core of our business. In 2016, we observed a mindset change that led many to embrace healthier habits and approach their medical professionals for guidance. However, not everyone had equal access to health services and the possibility of accessing a quality health service was determined by a person’s place of residence and socioeconomic status. Tech has been breaking those barriers. DOC24 has developed an ecosystem of digital solutions that includes telemedicine, preventive practices and follow-up tools.
Health starts with prevention, so we developed the AI-based “Wellness Test” that measures respiratory and heart rate and blood pressure through a facial scan that then delivers an overview of the user’s overall physical health. This tool can easily reach a large audience, massify health trends and deliver tailored recommendations. Using this data, we can identify risks, concerning trends and other indicators to successfully build a prevention plan.
Q: How is DOC24 using physical space to complement its telemedicine offer?
A: DOC24’s Diagnostica is a series of telemedicine stations installed at bus stations and in malls and corporate offices, among other high-traffic public spaces. People use a QR code to access the medical devices they need for an initial screen.
For homecare, we have a solution that provides follow-up for patients already undergoing medical treatment. We use AImedical assistants to offer personalized follow-ups depending on the patient’s medical condition. We also provide the necessary homecare devices so patients can receive precise monitoring and attention.
Through these services, we are closing the cycle of health, going from prevention to follow-up and becoming an ally to different types of health providers and companies that want to promote health. DOC24 is not just a telemedicine platform; the company is truly concerned about the patient’s wellbeing, especially at the early stages of treatment. We aim to seamlessly integrate our solutions into treatment to offer an integral service during the patient’s health journey.
A: The platform was developed as an intuitive solution for patients. Its products, such as the Wellness Test, provide a fun experience and promote engagement with the platform and health system by informing the patient of their health needs, leading them to look for care. Our follow-up services also retain users thanks to the use of WhatsApp, a well-established communication network. The corporate service asks partners to remain open to a monthly activity to educate users on the additional benefits of the platform, such as nutrition or mental health.
Everything changed after the pandemic, with patients and doctors increasingly adopting technology and they will not revert to the previous status quo.
 Pablo Utrera
Co-Founder and CEO | DOC24
Pablo Utrera
Co-Founder and CEO | DOC24
Q: What determined the company’s transition from customized patient files to a customer relationship management (CRM) system for hospitals?
A: TuoTempo and Docplanner aim to close care gaps within the health services at hospitals, expanding our service offering to respond to the needs of users within a health system. As we implemented our original solution, we identified the different needs of the market, industry and patients. We created a solution that made sense to patients in this ecosystem. Our logic is that if a service is useful for the patient, health institutions will eventually need it and this is what has happened with TuoTempo.
Q: How does TuoTempo strengthen Docplanner’s other services, such as Doctoralia?
A: TuoTempo scales up Doctoralia’s services, which focus on telemedicine and patient-doctor relationships. By focusing on the institution-patient relationship, TuoTempo provides Doctoralia with the quality care standard to provide its services to the patient. TuoTempo has about 14 modules that address different stages of the patient’s journey, which are necessary for doctors and institutions as they grow their business or make it more interconnected.
Q: How has TuoTempo adapted its solutions to respond to the demands of the different countries it works in?
A: Regulation varies by country but healthcare is very standardized. We focus on direct patient contact so we have had no issue adapting our services to different countries and running the solution at its full potential. In every country we work in, we build partnerships with local providers, including consulting, marketing and consulting firms. These companies allow us to focus on our services while they oversee the other aspects of the business.
We have to personalize our services for each institution in accordance with their particular characteristics, size, focus and sector, among other considerations. We adapt the platform so it can be integrated into any other existing technology at the hospital. Our technology does not have to replace existing hospital practices. Instead, we merge our services and theirs into a better solution.
Q: How has TuoTempo positioned its solutions in the Mexican market?

A: While we belong to a larger group, we had to open the market ourselves to look for the right clients. We targeted the innovation, operations, IT and infrastructure areas of hospitals, clinics and medical institutions. TuoTempo has received a positive response in the Mexican market because decision-makers see its ability to respond to a variety of unmet needs.
We provide hospitals and clinics with consultancy on patient interactions so they can understand the improvements TuoTempo can help them implement. TuoTempo is also in close contact with hospital professionals to ensure we integrate their feedback. TuoTempo is a living platform and we constantly improve it to benefit our clients and improve the relationship between the patient and institution, whether it is private or public.
Ricardo Ramírez Development Manager | TuoTempoQ: How is SocialDiabetes creating a solution that eases the journey for people with diabetes?
A: SocialDiabetes was created by a Type 1 diabetes patient, who after getting diagnosed realized the shortcomings in diabetes management. Diabetes is a disease of data. Correlating blood glucose with carbohydrates and treatment is essentially hacking how our body works.
A patient with diabetes has to make key decisions several times a day. Managing the disease requires much more than taking a pill; it forces them to transform their entire lifestyle and make micro-decisions every moment. The patient needs to understand how the body and diabetes work and needs to have personalized information on the status of vital signs. There is no public or private health system that can continuously support the diabetic patient. The only authority powerful enough to combat diabetes are the patients themselves.
SocialDiabetes has put digital therapy in the patient’s hands. It comprises a mobile application with a functional suite to support decision-making, helping patients control their diabetes. It measures sugar levels and other clinical indicators through universal integration with devices, while simultaneously allowing to have a normal and flexible life. Data management and artificial intelligence allow to provide patients with functionalities to take control of their health through highly personalized information, allowing them to lead a peaceful and healthy life.
Q: How did the technological boom that followed the pandemic change the reception of these types of tools?
A: During the pandemic, there was a boom in nonclinical technology, which was neither certified nor protected. During a crisis, the use of informal platforms is understandable but it is not a long-lasting solution. The most robust and experienced platforms, which have been validated and certified, and which have clinical evidence and real user satisfaction (patients and professionals) are the ones that are set to transform healthcare systems. When working in Mexico, we observed a great dissonance between what citizens expect and how their health systems are able to transform. Health systems are still reluctant to switch to the digital transformation, while citizens are willing and more than ready. From what we are observing, the patient is the one pushing public and private health systems to adopt these technologies.

Q: What is the purpose of the incoming SocialDiabetes Community?
A: This community, one of the services we are introducing in the short term, is the result of our upcoming project the Diabetes Academy. As a technology provider, we have accumulated a great deal of knowledge about patient behavior and needs and we have recognized that education is essential. Without education, patients are not capable of taking advantage of the available tools for their care, such as technology or pharmaceuticals. Sometimes patients fail to understand how diabetes impacts their health. Alongside the Diabetes Academy, we will provide patients with a 90-day course about the illness, teaching them about glucometers, SocialDiabetes, treatment management, carbohydrates, glycosylated hemoglobin, eating habits, physical activity, stress and more about diabetes day-to-day management.
María Jesús Salido CEO
All over the world, health tech startups are gaining more and more traction toward solving some of the main issues for patient experiences. However, last year, a handful of Mexican startups disappeared from the ecosystem in a matter of weeks. What could explain this disappearance, considering that the market is growing more than ever and more companies are willing to invest in new health solutions for their businesses?
What are Mexican companies doing differently than their counterparts in Latin America or Europe?
Truth be told, after working side by side with startups from different countries, I can ensure that there is no significant difference in the way they work; they all have a sense of purpose, great leadership and, in most cases, the right technology to support their business models for the private health market.
According to a survey conducted by McKinsey & Company in 2022, the ideal minimal patient journey for a digital health solution to provide is “consultation to pharmacy.” The patient will consider any other experience that is less than that as insufficient, with a significant risk of failure.
However, Mexico is a country with over 130 million people spread over close to 2 million square kilometers. In the last official census, INEGI reported over 12 million private health entities, including hospitals, pharmacies, laboratories and all other main health services. With such a wide variety of services, it is virtually impossible for a single company to fulfill all their patients’ needs.
Is there a solution in sight? Interoperability through health ecosystems. “Ecosystems create powerful forces that can reshape and disrupt industries,” according to McKinsey. In healthcare, ecosystems have a great potential to deliver a personalized and integrated experience to patients, enhance provider productivity, engage formal and informal caregivers, and improve outcomes and affordability.
These ecosystems combine the power of different startups and companies via a shared platform that integrates multiple services into seamless patient journeys. Such journeys include solutions for symptom checking, appointment booking, online consultation, e-prescription management, and service delivery.
The lack of government policies and a strategy for health information interoperability has opened the door for many companies to create joint efforts on massive health projects across the country using digital health ecosystems. The most recent example is Oxxo, with the ambitious goal to provide a private health service to its employees in more than 20,000 stores.
In May 2022, Medikit reported over 60 companies on its health ecosystem that served eight countries in Latin America, including Mexico. The idea is to help shape the coming trends and solve the populations’ necessities in terms of access to health services. If we make projections and carefully plan our work in the present, we will likely be addressing current issues while preventing future ones
The fast development and use of many health information technologies has enabled medical organizations to store, share and analyze a large amount of personal health and biomedical data, according to a study by BioMed Research International. With data generation growing every day, the possibilities, risks and challenges of using it in public health increase. However, its correct use is yet to be defined.
Big Data collection and analysis enable doctors and health administrators to make more informed decisions about treatment and services, according to Tulane University. In other areas of the healthcare industry, administrators can use key performance indicators and data analytics to make a number of funding and resource allocation decisions. At hospitals and other care facilities, big data can capture a comprehensive picture of the patient experience. “Big Data tools allow care teams to merge data that would otherwise be archived in separate clinics, hospitals and specialist offices and remain underutilized. Instead, big data holds the promise of consolidating patient information, allowing for rapid and accurate communication between patients and providers that draws from a patient’s entire health history,” the university says.
To get the most of this data and its benefits, its correct handling at each step is crucial. The Journal of Big Data (JBD) explains that this can only be achieved by using high-end computing solutions for big data analysis. This is why, to provide relevant solutions for improving public health, healthcare providers are required to be fully equipped with the appropriate infrastructure to generate and analyze big data systematically.
Access to data is being democratized, which means that more and more companies are becoming data-driven. “The goal must be to use this data to drive actions that lead to improved health outcomes – better clinical outcomes, more efficient care delivery or lower healthcare costs,” according to EY. With many players collecting this information, international and national regulatory frameworks are needed to oversee its correct use, respecting the privacy and true ownership of such information. HL7 is one of the most relevant and accepted standards to transfer and share data between various healthcare providers. These standards define and provide formats for messaging and data exchange, decision support, rules syntax and common health data definitions in clinical documents and EHR and personal health record (PHR) claims attachments, quality reporting, product labels for prescription medications and clinical genomics.
The importance of internationally accepted standards, such as HL7 arise from the lack of frameworks in some countries and the desire to unify the process of data sharing at a global level. In Mexico, the latest regulatory reference regarding interoperability and information exchange is NOM-024, issued in 2012. “This means that Mexico is almost 10 years behind in terms of regulation. NOM-024 is not fully compulsory as it does not establish the enforcement of interoperability standards. However, the norm mentions the use of standards such as HL7,” says Victor Medina, President, HL7 Mexico.
Accelerated digitalization in the health sector is an urgent need but it requires an increase in public health spending. While the initial expenditure might be high, digitalization could be a watershed for this industry, says PwC Partner José Alarcón.

Mexico ranks 51st on the Bloomberg Global Health Index, which measures specific health risks, such as tobacco use, high blood pressure, obesity, the availability of drinking water, average life expectancy and malnutrition, among other risks. In Mexico and the world, life expectancy has fallen by approximately four years due to the pandemic. “From this result, it is inferred that Mexico has a lot of work to do but digitization is essential to be able to address these problems in a cost-effective way,” says Alarcón.
Mexico is also facing an aging population and is getting closer to losing its demographic bonus. However, the country still has an active middle class comprising 50 million people, twice as many as the total population of Chile. The country, however, has a limited health budget.
“These trends, if addressed with the current care model, will require an excessively large number of personnel, infrastructure and health supplies, which is unsustainable for any government,” says Alarcón. Under the current model, the system would require an additional 3.5 million hospital beds, 3 million more doctors and 6 million more nurses. But there is another, more cost-effective model to achieve the desired care for patients: the digitalization of services. “We need to move toward homecare models in terms of therapy and recovery, mobile health (mHealth) and preventive health,” says Alarcón.
Technology is now being used to promote prevention and increase accessibility, even in the most marginalized areas since some medical care does not require a physical installation. Telemedicine is one of the strongest trends in the sector, with a growing number of new players entering every year. The public sector is also beginning to adopt digitization initiatives. For example, COFEPRIS has been offering workshops on the digitization of its practices and processes since last year. In addition, 84 percent of doctors in Mexico are connected to the internet and of these, 80 percent use it in their professional practice. PwC found that:
+
percent of doctors use the internet to read relevant content
+
percent use it to search for information for prescriptions
+
percent use it for electronic clinical records
percent use it for virtual consultations
WhatsApp is the most widely used medium for medical practice, reporting 90 percent use. It was followed by Facebook with 64 percent. Moreover, doctors have observed that when patients search the internet before their consultation, the dynamics of their conversation change, often allowing for a better diagnosis in 83 percent of cases, says Alarcón. In 42 percent of cases, the patient’s previous research influenced the prescription, demonstrating the shared responsibility between patients and doctors.
“Mexico needs to strongly increase investment in health in general to potentialize the use of digitization with a human approach so that the results are much greater,” Alarcón said.

Q: How will your alliance with Benzobas support t he launch of Grupo SOHIN’s Cuidarte clinics?

A: In January 2022, we sold a percentage of Cuidarte to gain the funds to open 14 clinics in the next 36 months. The first six clinics will be inaugurated in 2022. With this alliance, we will offer an alternative to ambulatory clinics to provide care to oncological and onco-hematological patients. These clinics will offer financing and quality services to treat the diseases that are challenging patients, their families and the public and private health sectors.
Cuidarte is focused on the many oncological diseases that represent a burden for the health sector. There are approximately four diseases that represent 60 percent of the public spending in health. By addressing these diseases, we support the entire system’s viability. We treat cancer and other diseases related to disordered cell growth. We also address hematological, autoimmune and rare diseases.
Q: How does Cuidarte measure its impact?
A: Right now, we only have a clinic in Mixcoac, Mexico City, which will demonstrate the service’s capabilities and measure its market reception. The results will be used for a second investment round. Grupo SOHIN’s main indicators have always been the number of patients and the impact of the clinics on their quality of life.
By evaluating these indicators, we can monitor the experiences of patients facing this complex disease. We also evaluate how attractive the service is to investors. During the clinic’s first two months, we attracted over 20 potential investors, which showed there is a real need in the market that can be met with our value proposition.
Q: Grupo SOHIN is positioning its Concierge service in the EU. What is the most relevant achievement of this service in Mexico and how will you replicate it in the EU?
A: Social entrepreneurs measure the impact of a project through the number of people they reach. We aim to offer our services to more patients and, for an entrepreneur, geographical barriers do not exist. Now that we have a partner in the EU, we aim to provide access to our services to that continent, starting with Spain.
Q: Before the pandemic, funding and investment for healthcare entrepreneurs were hard to get because results took a long time to materialize. How has this changed?
A: The enthusiasm for investing in the health sector was renewed thanks to the COVID-19 pandemic. However, investors do not understand the sector. Many see health as an attractive sector for investment but they lack experience in the industry.
Some health initiatives offer magical solutions with unrealistic premises. It is a shame that these projects are being financed because they take funds away from viable initiatives. If they fail, these enthusiastic investments could end up driving away investment in health entrepreneurship due to bad experiences.
Juana Ramírez CEO and Founder | Grupo SOHINQ: What are the key components of interoperability in a digital health ecosystem and how does Health Gorilla’s services offer the best solutions for this ecosystem?
A: Health Gorilla was founded in 2014 to build an API based on Fast Healthcare Interoperability Resources (FHIR) that addressed the realities of the laboratory industry, allowing it to receive results electronically in one single platform. The goal was to present a solution that could stand alone or be embedded. This solution would allow any doctor to request different tests from any laboratory, receive the results in a single platform and share those results with whomever has the right to access it, which depends on location. We follow the legislation of each of the countries we work with.
The innovative idea is not the connections because anyone can connect to anything. The difficulty is that different laboratories and doctors use different systems and structures. Health Gorilla is able to digest the information produced by all these different companies, normalize it, match the patient with their masterpatient-index, duplicate it and generate a single health record for each patient. The patient does not need to go to each individual laboratory to get results.
Q: What have been the challenges Health Gorilla has found in offering patient services through different mobile devices and different hospital infrastructures?
A: The issue is not the technology but the processes and resources. We connect to over 100 standard formats and we need to obtain the governance, data-usage agreements and the trust from each participant. Technology is not a big barrier as long as we are dealing with standards. HL7, an international standard for the transfer of clinical data, is a great example. While it is a standard, not every hospital or laboratory has the same internal resources and processes, so we need to determine where the data is and how to exchange it. Then the problem is the content and its quality. Many systems are different. For example, some recognize accents while others do not.
In Puerto Rico, we created a master patient index in the system used by one of our customers is the Department of Health and they are using Health Gorilla’s master patient index and will share with the entire ecosystem, giving patients a unique identifier to reduce errors or duplication.
Q: How do you handle the lack of information in patient health records? How is this information translated as the patient navigates different environments?
A: One of the reasons for our success is that we do not replace anything; we just add to it. Some of our customers then decide if they want to replace something, but that is their decision. Systems that do not use FHIR as their standard can do so gradually. Many clients do not want to deal with the cultural rejection of the new system, which is happening in Mexico. Some hospital systems are buying others but they should not rip out and replace the existing system because it takes time for users to learn the new one. Technology rejection can make a project fail. Having us in the middle frees that company from the need to replace a system. It can gradually substitute processes.
 Javier Jiménez
Vice President Latam and Government | Health Gorilla
Javier Jiménez
Vice President Latam and Government | Health Gorilla
Q: How has demand for DocTour’s regular and business services improved with the recovery of tourism?
A: Our most significant improvement is our new service platform. We also implemented some memberships for vacation rentals, which users and hosts have requested. Through the memberships, visitors are entitled to an ambulance and medical services. It also provides small coverage for expenses in case of an accident and discounts on medicine delivery. Benefits for property owners include cleaning assistance once a year, some furniture installation and legal assistance.
We also offer a product for businesses that provides their employees access to nutritionists, psychologists and telemedicine, along with webinars and health services campaigns. Through the program, employees can access unlimited consultations with our doctors and get checkups for eye health and chronic diseases. It also includes a small life insurance policy, reimburses medical expenses, and helps with funeral expenses at a reduced cost for companies.
Q: How has your recent partnership with Microsoft for Startups improved your service offering and performance?

A: We formalized our software licenses to improve our information security. We chose to protect our operational data with Microsoft. We started by using business licenses to set up an information security structure. Later, the software giant invited us to use Microsoft for Startups, allowing us to participate in mentoring events and gain Microsoft credits.
Several providers asked to use this platform, so we are offering it as a white label. We are building this tool in different environments so the client can implement it in their cloud.
Q: What are the regulatory or legal frameworks that DocTour must follow to prescribe?
A: Prescriptions issued in Mexico are only valid in the country. Mexican doctors can treat foreigners in Mexico without a problem but they cannot write prescriptions for Mexicans traveling abroad. In this case, they can only give advice or make a suggestion to doctors in the country where the patient is residing. If it is a minor problem, DocTour can recommend an over-the-counter (OTC) medicine.
Q: DocTour worked with Tecnológico de Monterrey to create rural telemedicine centers and provide healthcare to rural communities. How has that evolved?
A: We have several projects with Tecnológico de Monterrey. Within its “Tec 21” modality, we participate as a partner/ instructor for some programs, doing projects with students related to innovation and mapping the country’s health problems. We have two projects in this modality. The first relates to information security, and the second aims to provide medical care to Nuevo Leon’s rural areas alongside the Anacleto fund (FONDEAGG), which already brings education to rural communities by providing tablets with audiovisual content to families who have school-aged children.
Gabriel Garza Co-Founder and CEO | DocTour
Q: How does C Minds work toward a more inclusive and human-centric public policy while advancing the debate around ethical tech?
A: C Minds is a women-led think tank that collaborates with all sectors to generate public policy recommendations surrounding the responsible development and use of AI, carries out pilot projects to understand the opportunities and risks for society and the environment, and strengthens key actors’ knowledge with regards to frontier technology. We see ourselves as an innovation agency with very unique projects. C Minds does not create outof-the-box solutions but we collaborate with players that share common goals. We cover several topics besides AI, such as blockchain, open banking or open finance and the metaverse. It is all about foreseeing the future and proposing solutions.
Our goal is to contribute to guaranteeing that everyone, everywhere, has access to the same opportunities, which we work towards via technology, with a heavy focus on AI. In 2019, C Minds authored Mexico’s National AI Strategy together with the British Embassy in Mexico and Oxford Insights, with input from local experts and existing international best practices. Mexico was among the first 10 countries to create a national AI strategy.
Q: What are the main areas of opportunity in the adoption of AI in Latin America?
A: AI has been mainly adopted in the health industry. Bringing health services and personalized medicine to rural areas has always been a large challenge. I also see a lot of potential for the education sector, offering many personalized and extracurricular support opportunities, but these elements are less widespread, as they are in an earlier ideation phase. While AI comes with many promises, we can only achieve them with an ethical, responsible and human-centric approach. For instance, many companies offer health services in rural communities free of charge, which is a very noble endeavor, but does the business model align? Some of these companies are selling users’ data to third parties without their knowledge or consent for a profit.
Q: What role does regulation play in the ethical use of AI?
A: Having appropriate normative frameworks is crucial. Our experience has been that it can be difficult to make companies aware of the importance of guaranteeing an ethical use of AI. Companies tend to see this as an expense and usually have other priorities, especially during challenging times like these. What they do not always realize is that AI is highly complex and even when trying to use it for improving business processes, external issues can easily arise due to a lack of precaution, which may impact the sustainability of the company by reducing user trust.
Read
More
More
Appropriate frameworks are key to ensure the industry is working in a way that will not affect individual rights and freedoms. This will create more trust from the potential user base. Looking at existing proposed regulations, the EU AI Act suggests AI companies take specified precautions based on the level of risk their AI application poses to individuals and society, with the EU Commission defining the risk categories. While an excellent first approach to regulation, this document has received some criticism for two main reasons: the difficulty to anticipate risk and the prohibition of the use of black-box algorithms, as these do not offer any transparency.
Claudia Del Pozo Director | C Minds Eon Resilience LabSpirit: How to Succeed in the Health Market

0 9/02/2022
Cybersecurity Investment, Education:
for
0 9/01/2022
Telework and Mental Health:
of
J orge Merida Puga
General | Advisory Network for Well-Being
It’s
D iego Muradás
| Zenda.la
Reinventing
I bar Langle
| Elery.co
Supporting
Adriana Vallejo
J osé Luján
Manager,
C arina
N athan Shabot
Traditional care providers and facilities have experienced a speedy evolution as tech makes its way through health practices. Care providers are now moving beyond adopting tech to developing it, taking a much more prominent role in this transformation.

Digitization of medical practices is being prioritized at schools and introduced through continuous training for health professionals. Medical facilities have also demonstrated the will and readiness to transform their offering to meet the demand of a new, empowered and digital-savvy population.
Nevertheless, there are still fundamental challenges straining the industry from its formative stages. Mexico’s insecurity and corruption problems have been reflected in constant attacks against doctors in training that prevent them from continuing with their education at public and private health institutions, threatening the future of the sector.
This chapter explores how traditional care facilities are adapting to the digital transformation and how professionals are adopting and developing tech while facing barriers to exercising their practice.

Vanessa Lara Training Coordinator | Mexican Consortium of Hospitals
Guillaume Corpart Founder and CEO | Global Health Intelligence

Juan Manuel Fraga Director General | Cancer Center Tec 100
As populations around the world get older, technology advances and healthcare transforms following the COVID-19 pandemic, hospitals will evolve their operations, starting from their structural design. While the transformation will take time, the healthcare of the future will be very different compared to today, agree industry experts.
“The hospital plays an important role because it is the meeting point between doctors and patients. Despite the growth of telemedicine, hospitals remain important. However, hospitals will change dramatically in the future, leveraging all types of technology to improve healthcare and give patients control over their health,” says Guillaume Corpart, Founder and CEO, GHI.

Organizations must assess their current barriers to consumer satisfaction and deploy analytics and patientcentric technologies to improve the convenience, speed and transparency of care. In addition to the digitization and streamlining of appointments and processes, personalized care has become a top trend. The infrastructure and structural design of hospitals could be outdated soon, adds Juan Manuel Fraga, Director General, Cancer Center Tec 100. “Hospitals will become more versatile in the use of physical spaces, such as having flexible rooms with different purposes. In addition, homecare has allowed hospitals to use beds for smaller periods per patient. We must leverage these resources.”
While AI and automation are still penetrating the health industry, telemedicine took the spotlight during the pandemic and its impact is continuing. Telemedicine was born as an alternative to face-to-face consultation and, while the model still faces several challenges, it has grown significantly. However, it will not substitute in-person healthcare, says Corpart. “Telemedicine can be a capacity buffer in times of crisis, doubling our capacity to provide healthcare access.”
Quality and efficiency in most parts of the patient journey can be improved through data analytics, AI and automation. AI is having “an amazing impact on radiology, with solutions to reduce redundant tasks, eliminate bias-based reading errors, identify data patterns in images to predict risk and enhance workflow processes,” says Fraga. While the positive impact of these technologies is clear, a necessary step has yet to be taken: digitization and interoperability within healthcare institutions.
Q: How much are the domestic private and public sectors investing in telemedicine?
A: We have found that the hospitals that were more willing to invest in telemedicine were those that had already begun the transformation. Epidemiological trends are moving toward geriatrics, obesity and mental health, which are expected to impose a burden on investment. Despite this, many providers still have linear investment plans, lagging behind the existing healthcare trends. This shows that health investment is unlikely to follow these trends without scalability, which can be made possible through the use of technological tools that allow remote monitoring, telemedicine and ECR, among other solutions that will improve efficiency without large changes in physical infrastructure.

The pandemic accelerated the will to invest in these technologies and some actors experienced the benefits right away. For example, during the pandemic, the Hospital Italiano in Argentina went from seeing around 4,000 patients per year to seeing 4,000 patients per day through telemedicine. As it was already transitioning to digital practices, it only had to invest in bandwidth to expand its services. With the pandemic under control, the trend has now reversed and 80 percent of the hospital’s consultations are back to being in-person. Yet the fact remains that the Hospital Italiano has a major infrastructure advantage in being able to pivot back to online consultations via telehealth at a moment’s notice.
Q: How will telemedicine be included in GHI’s indicators when ranking hospitals?
A: At a regional level, telemedicine is present in about 12-14 percent of hospitals, with those in Puerto Rico being outstanding due to their alignment with US insurance services and the overall US health system. We also found that there are two types of telemedicine adopters in this regard: hub hospitals, where specialists are centered; and spokes, from which patients connect with the hub hospital. With this model, primary care facilities can connect to general hospitals and even specialized hospitals for a collaborative approach. This model can be fluid, so some centers can be spokes and hubs simultaneously.
In Mexico, private hospitals are significantly smaller than their public counterparts; private hospitals have about 16 beds per institution versus 95 in the public sector. This represents a large disparity compared to other countries in the region, where private hospitals will have 40 beds and public hospitals 50 beds. This gap becomes significant when we look at their investment capacity: public hospitals are far more capable of investing due to their size.
Private hospitals are also divided into large centers, such as Médica Sur and Hospital Español, and small institutions, the latter of which take up the largest percentage in the overall census. While large hospitals invest in modernizing their infrastructure to have a digital hospital, this is much more complicated from a financial standpoint for smaller facilities. Nevertheless, some private hospitals will practice telemedicine using free access sources like social media, which is not necessarily the best way to do so as they lack the electronic clinical record and other valuable health data that professional telemedicine services offer. Free access sources also limit telemedicine because they are not connected to PACS or RIS systems, so while they can be useful for certain specialties within telehealth, they are not applicable to all specialties.
Guillaume Copart Managing Director | Global Health Intelligence
One of the lessons learned from the COVID-19 pandemic has to do with the need to access data and generate evidence in record time. The necessity to quickly understand COVID19’s characteristics, accelerate research and development (R&D) processes and generate and assess new safe and effective vaccines and therapies in a swift manner has undoubtedly resulted in an increasing interest among life science companies to further embrace Real-World Evidence (RWE) studies.
RWE is defined as healthcare information that is obtained from data not collected in traditional clinical trials. Patient-level data from which RWE is generated are termed Real-Word Data (RWD); these comprise numerous sources, including information from electronic medical records, claims and billing data, clinical registries, surveys, pharmacy data, and data collected through wearables and health applications, among others. Typically, life science companies conduct RWE studies to inform the development of new therapies and medical devices, health outcomes research, safety surveillance, patient care, quality improvement, and effectiveness studies.
In Mexico, however, although RWE has been used in the development of patient registries by academic institutions and pharmacovigilance studies, not much else is known about the utilization of RWE in the country. There is some evidence that suggests that it is used in health technology assessments (HTAs) as a means “to support prioritization and rational use of health resources and to maintain sustainable healthcare budgets,” and to inform clinical decision-making in oncology. Furthermore, several post-authorization safety studies and pharmacovigilance studies have also been reported.
The lack of knowledge with regard to RWE and RWD, the lack of guidance from regulatory authorities, and the need for greater coordination and incentives to support RWE generation for use in the pharmaceutical, clinical and healthcare settings are among the most important challenges for the adoption of RWE in Mexico. Moreover, although Mexico’s regulatory agency (COFEPRIS) has implemented a registry for both clinical trials and observational studies, it is somewhat unreliable.
From the above, the need for a reliable registry of RWE studies is essential to monitor and evaluate the use of RWE in Mexico and to further enhance the development of RWE utilization. Mexico’s regulatory authorities should take advantage of current opportunities for the expansion of RWE use. Among them:
+ Health technology assessments (HTAs) are mandatory in Mexico and require the submission of evidence from randomized clinical trials (RCTs). The design and enactment of new guidelines supporting the use of RWE as a complement to evidence from RCTs is clearly an opportunity to support the adoption of RWE.
+ Current guidelines from COFEPRIS drive demand for post-marketing surveillance studies because they require that pharmaceutical companies submit active surveillance plans for all new products prior to receiving authorization. These guidelines encourage the use of pharmacovigilance and post-authorization observational studies.
+ Increased mobile adoption. This represents a digital health opportunity for RWE generation (e.g., the use of telemedicine).
+ Global increase in funding for RWE within the pharmaceutical industry.
 President and CEO | PharmAdvice
President and CEO | PharmAdvice
As with many other sectors, healthcare saw the COVID-19 pandemic amplify long-standing industry issues as well as create new ones, thus driving the need for accelerated innovation and technology. As a result, the pharma/ healthcare e-commerce space experienced massive pandemicinduced growth. The ease of operation, convenience, added digitalization, improved security, lower cost implications, and, of course, an increase in the number of patients are all drivers contributing to the expansion. The increase in the adoption of telehealth solutions, uptick in remote care, surge of online script filling and rise in mail-order services, clearly reveals that patients, physicians, and institutions are ready – or were forced to be ready – and are now willing to move a significant part of medical care to digital channels.
With the global healthcare e-commerce market estimated to reach US$435.8 billion in revenue by 2025, it is clear that there is both a want and a need for online health products and services among businesses and the general consumer population. This boom is poised to develop even further and align with the ever-changing patient and provider needs in this increasingly digital world and has in turn propelled the rise of innovative medical applications, such as telemedicine, online pharmacies (aka e-pharmacies), and remote medical consultation, among others to come.
In the last decade, the application of e-commerce has been evolving from a technology-driven to a more user driven-model, where e-commerce has become synonymous with communication, strategy, and business practices. Therefore, using e-commerce as an aid to exchange information and execute transactions among businesses and individuals will not be enough anymore. Supplementary traits, such as automation, personalization, customization, and customer experience, will be key success factors to gain a competitive edge.
The integration of telemedicine with digital commerce, for example, is enhancing the patient experience considerably, thus resulting in improved clinical and business outcomes. As competition for patients increases, patients may choose among providers based not only on clinical outcomes but also on their overall satisfaction and experience. Satisfaction can be affected by many factors, such as convenience, integrative product and health services portfolio(s), customer service, user friendliness, turnaround times, transparency, relational follow-through, feeling understood and cared for and how effectively they feel their provider communicates with them. E-commerce in the pharmaceutical industry has started a new age, both in terms of its uses and its applications, hence, carving out a differentiated place in the digital ecosystem will be vital for every pharma/ healthcare company.
It will be crucial, for pharma companies as well as healthcare providers, to prepare and collaborate by building strong partnerships and alliances that will enable them to keep up with, and successfully compete in, this fast-growing market which offers astounding opportunities, as witnessed by the increase of emerging markets and target audiences, the number of strategic alliances, new nontraditional incumbents, and the rising investment for the development of advanced technologies. Whether for branded or off-patent drugs, telehealth solutions, or remote care, building an end-to-end platform that puts the patient at the center
presents a huge opportunity for companies that execute and partner effectively.
In both, a business-to-business (B2B) and business-to-consumer (B2C) context, e-commerce can enable easy, efficient, and transparent prescription drug buying and other essential services, such as telehealth, inevitably leading to higher demand for such offerings across the board. However, despite the clear patient and physician appetite for and adoption of digital platforms outside of limited specialized offerings that mainly offer generic drugs, full end-to-end experiences are limited.
Today, most current solutions in pharma/healthcare are piecemeal: prescription services, telemedicine providers, e-commerce platforms and pharmacies are all separate entities, leading to an inefficient process and a subpar patient experience. Companies are leaving money on the table when they could bring the value chain together while offering their full value proposition and brand(s). There remains a significant opportunity to bring the entire value chain together for the benefit of the patient – and their own –partnering and aligning each element of the telehealth service, for example, to create an end-to-end e-commerce experience.
With full e-commerce integration, corporations can offer patients and providers an easy, efficient way to search for remote consultation and purchase the drugs they need, as a start. In a B2C context, this means patients can get diagnosed, purchase and receive their prescription drugs from the comfort of their own homes, avoiding hassle and additional costs. In a B2B context, comprehensive pharmaceutical e-commerce platforms can allow providers to compare all the different, constantly fluctuating factors involved in drug purchasing or in procuring medical services and solutions (i.e., preclinical) — including current availability and prices — to enable informed spending.
While few instances, the more successful e-commerce attempts have indeed created all-encompassing platforms – a one-stopshop approach. One example of a marketplace in the industry is AstraZeneca’s AIM (AstraZeneca Innovation Marketplace). The B2B platform has simplified buying preclinical services from external partners. AIM operates a research concierge that enables the company to choose suppliers that meet the prerequisites set by the company. AIM provides price quotes along with technical information. It is the primary route for AstraZeneca to do business with preclinical research suppliers.
It is clear, however, that with transparent purchasing capabilities, companies may be forced to become more competitive in their pricing. Knowing what everyone else is bidding, asking, and trading helps determine the true supply and demand for a drug or service – that is, its true value. When this information is spotty or unavailable, the market is less efficient. Therefore, enabling price transparency among individual pharma/healthcare organizations will encourage competition. Open e-commerce platforms can give these organizations an idea of current market pricing and provide them with more bargaining power when it comes to securing drugs or healthcare services at lower costs. Online drug purchasing should help hospitals and healthcare systems with securing the drugs they need at the best possible prices at a given time, potentially leading to significant organizational cost savings. Realtime price monitoring and spend tracking should create an easier, more efficient experience overall.
Q: What factors set elery apart from other telehealth platforms entering the Latin American market?
MC: elery is a platform that uses technology to provide a differentiated experience to patients. Through tech, we connect patients with surgeons or certified specialists and help them book an in-person appointment. Our services continue throughout the patient’s journey, whether this involves scheduling treatment, providing pre-operative or post-operative information, or helping with paperwork. We do not like to consider ourselves a telehealth platform because we are convinced that to properly provide care and transform the health system, care providers need to have an online and offline platform.
elery came to life after we realized, through our urology brand called Clinicasdelhombre.com (Men’s Clinics), that middle- to lower-income patients struggled with data connectivity and trust when offered a telemedicine appointment. They wanted in-person doctor appointments. This is our target patient and we are obsessed with offering a solution that suits them best.
As a patient-centric company, elery has three core principles: medical excellence, a differentiated online and offline experience, and accessible prices for our patients.
IL: elery is an online-to-offline (O2O) company that is reinventing specialty care for the middle class in Latin America. We attract patients online and treat them offline, while keeping every interaction connected to our platform. This model aligns with surgeons and specialists to form a true partnership.
Q: Does the platform have a fixed base of specialists? How can more doctors join the platform?
MC: We have a fixed base of doctors that we have intensively certified to make sure they align with our principles and mission. Nonetheless, we have a list of affiliated doctors whom patients can approach if their case is beyond our fixed capabilities. elery is reaching out to more surgeons to increase this fixed base.
Q: Where are elery’s physical clinics located and how do they shape your business model?

IL: We have a urology clinic and a spine clinic in Monterrey, two clinics in Mexico City, one in State of Mexico and another in Guadalajara. These clinics are highly equipped to carry out minimally invasive procedures with state-of-the-art devices.
MC: We are hoping to obtain a seed investment within the next two to three months. Tech has enabled this business to be real, sustainable and profitable for investors. Our objective is to have a total of 40 clinics focused on urology and spine specialties by 2023 in the largest cities in Mexico. In the near future, we are also planning to open a new medical specialty. We will decide which specialty based on market needs.
After these 40 clinics are well established, we are looking at Colombia and Brazil to replicate this model. Both markets share some similarities with Mexico and we are familiar with these systems.

While healthcare systems vary in their structure and available resources, doctors play a key role in their adaptation and performance. Their fundamental place in the system is an indicator of quality care provision. Still, doctors in Mexico struggle to have their contributions recognized.
According to OECD standards, effective health systems have a rate of 3.2 doctors per 1,000 inhabitants. By 2019, Mexico’s rate was 1.95 professionals per 1,000 inhabitants. As a result, before the COVID-19 pandemic, the country was estimated to have a deficit of more than 73,000 doctors. This has created cause for concern among policymakers and authorities, especially after the COVID-19 pandemic highlighted the weakness of Mexico’s health system.
In Mexico, 18,000 doctors graduate per year. Almost all of them look forward to entering a specialty by completing the National Exam of Candidates to Medical Residences (ENARM). Passing the ENARM test and then finding a job is the challenge, explains German Fajardo, Director, UNAM School of Health Sciences. Many of these doctors end up working at one of the 20,000 pharmacyadjacent offices in Mexico, as there is a lack of opportunities for general doctors to specialize or to enter the field they desire, which frequently leads candidates to start working in another area, according to Fajardo. As a result, many states have almost no specialists, which is a historical problem in Mexico and deprives people of proper access to healthcare. This, in broad terms, is part of what fuels the deficit of medical doctors. However, the problem goes as far as educational training.
To obtain a medical or nursing degree, students must contribute to the country’s health institutions as part of their social service or their specialization. These medical and nursing students are given responsibilities and obligations similar to those of an average employee. However, ONG Nosotrxs found that while serving as interns, most students face precarious conditions and abuse from authorities, including shifts longer than 8 hours with low and delayed pay, sexual abuse and harassment from authorities.
“This happens partly because universities are responsible de jure for students but medical care units are the ones in charge de facto. This leaves students in a vacuum facing possible violations to their rights,” states a report by Nosotrxs, which highlights that these situations affect employees’ personal and professional development as they face abuse and uncertainty from this very early stage.
There is a mismatch between education and employment opportunities, coupled with a lack of investment in education and training, which eventually leads to brain drain in the field.
Still, a recent study by IMCO found that medicine is the best paid professional career in Mexico, with an average monthly salary of MX$17,846 (US$886). While at the top of the list, Mexican medical professionals face low wages when compared to other countries.
A doctor with a postgraduate education earns about MX$25,000 (US$1,241.16) per month or MX$132 (US$6.55) per hour. A general nurse in the public sector earns around MX$10,000 (US$496.46) and a nursing specialist earns around MX$15,000 (US$744). However, in rural or remote areas of the country, medical professionals are paid between MX$300 (US$15.10) and MX$1,000 (US$50.32) less than in urban areas. Meanwhile, according to Medscape, in the US, primary care doctors earn US$20,250 per month, while specialists earn around US$28,833 per month. Nurses earn approximately US$6,108 per month and nursing specialists earn an average of US$8,853 per month.
Doctors have an average monthly salary of MX$17,846 (US$886) against the national wage average of MX$7,982 (US$393.87)
Around 72 percent of all doctors in Mexico work in the public sector. Meanwhile, specialists work largely in the private sector. Approximately 55 percent of these specialists are concentrated in Mexico City, State of Mexico, Jalisco, Nuevo Leon, Guanajuato and Puebla. In 2018, according to the National Institute for Public Health, Mexico had 1.1 medical specialists for every 1,000 people, most of them focused on family medicine, anesthesiology, pediatrics, gynecology, surgery and emergency medicine.
Men - MX$18,368 (US$906.36)
Women - MX$17,290 (US$853.17)
MenSource: Mexican Institute
More
The COVID-19 pandemic exacerbated the precarious conditions of health workers in Mexico, who have suffered public harassment, discrimination and even violence from society. They have also faced a lack of medical supplies to face the pandemic safely. In 2020, Mexico had the highest number of healthcare worker deaths from COVID-19. Amnesty International found that globally, more than 3,000 healthcare workers had died after contracting COVID-19. The countries with the highest mortality rates were Mexico (1,320), the US (1,077) and the UK (649). The Lancet launched a special study on the subject and reported that less than three weeks after Mexico recorded its first COVID-19 case, around 70 protests had taken place, with medical staff evidencing shortages of supplies and tests, as well as proper training.
Reversing the current scenario for doctors would improve their professional and personal development, while creating a positive impact on care provision and patient attention in the country. Solutions for some of these problems began to see the light in early 2019 when the government proposed salary raises for doctors in rural areas with the purpose of attracting doctors to areas in need.
Limited budgets at public institutions are part of the problem regarding the lack of general doctor vacancies, as well as the general dynamic of care provision at these facilities, according to Andrés Castañeda, Health and Wellness Coordinator, Nosotrxs. He explains that limited hiring by cash-strapped public health institutions leads to medical students filling in for general doctors. “This becomes a ‘cheap labor’ dynamic that affects both medical residents, who are not being paid for the job they are doing, and patients, who end up receiving care from a student and not a qualified doctor,” said Castañeda. Doctors’ associations are actively seeking better working conditions and training experiences for their members through initiatives like Médicos en Formación (Doctors in Training), which focuses on gathering complaints from medical doctors under trying circumstances to build a unified voice.
President | ACANEMED
Eliseo Ruiz
Founding Partner | Med Congress

Luis Alonso Herrera Director | INMEGEN
Gabriela Clavel
CEO | Abeile Med
Jorge Valdez GarcíaMany educational institutions are prioritizing training in new technologies in their academic programs for health professionals. The use of digital technologies in medicine can reduce access gaps, offer high-quality processes and boost preventive medicine. However, digital education plans have to be homologated across universities so technology can reach everyone despite their location, say experts.
“Technology needs to support the development of an easier way of learning and teaching in the health sector,” says Luis Alonso Herrera, Director, INMEGEN. Technology has been used to support medical education and facilitate the acquisition of basic knowledge, the improvement of decision-making, psychomotor skill and coordination, the enhancement of perceptual variation and to practice for critical events, among other skills.
To continue promoting the use of technology by medical students, they should be encouraged to get involved in innovation as early as possible. “We must shift to a competency-based education model, specifically regarding digital competencies among health professionals to help them move from passive to active users. The scenario is very challenging but full of great possibilities,” says Jorge Valdéz García, Dean of the School of Medicine and Health Sciences at TecSalud, Tecnológico de Monterrey.
The health sector will also need to rely on collaboration to successfully shift toward digitization. “Tech adoption is an interdisciplinary objective that requires efforts from all actors in the sector,” says Gabriela Clavel, CEO, Abeile Med. Likewise, teachers must continue to receive training on the emerging digital tools. “Health professionals have to be involved in this process to survive because there are specialties that are being threatened, such as radiology. AI is now part of imaging, which supports diagnosis. In the future, it will be possible for machines to provide a diagnosis. Adapting to technology is essential for survival,” says Agustín Zabulanes, Country Director, BSCI.
Technology is also helping to pave the path toward preventive medicine and leading to a strengthening of prevention of certain diseases, reducing mortality levels and hospital admissions, treatment of patients in a more personalized way and increasing adherence to treatments. Unfortunately, these advances are not reaching all the regions of the country equally. “Technological developments are being developed in the country’s largest cities, affecting primary care because they cannot reach every location,” says Eliseo Ruiz, Founder, Med Congress.

Dean of the School of Medicine and Health Sciences | Tec Salud, Tecnológico de Monterrey


Teaching medicine presents several challenges that make it a complex activity. Medical education requires effective planning to properly manage such a complex, didactic activity. Therefore, it is important to ensure a collaborative, constructive, and respectful link between academic activities, healthcare needs and tasks in providing care. The quality of training is inseparable from the quality of care and research.
Academic medicine requires multidisciplinary professionals capable of developing their medical work while researching/ publishing, teaching and training continuously. Currently, there are many professionals who combine all these tasks. An academic health center can associate the most advanced knowledge with problem-solving and develop transdisciplinary original and relevant research on complex problems, which is simultaneously endowed with social transcendence. In addition, the training processes are oriented not only to educate students in the ability to perform their professional functions but also in research, innovation, and continuous improvement of practice.
There will be no effective progress in academic medicine in Mexico if training and updating processes for academic staff are not established. The training processes for teachers must take place on two levels: The first, aimed at promoting an update to the disciplinary field. The second is to develop the pedagogical training of academics (favoring the development of teaching competencies), to use experiential learning, to design instructional environments, to encourage complex learning and to apply the development of collaborative learning, in addition to promoting the use of process-centered educational methods, such as experiential learning, self-directed learning and the ability to contend with complexity.
Since the Flexner report in the 20th century, the teaching and learning process has evolved through science learning, problembased learning, competency-based learning and perspective learning. This evolution provides a consensus that educators need to develop competencies in their students to prepare them for an uncertain future. Competency refers not only to core knowledge or instrumental skills but to interpersonal and systemic abilities required for lifelong learning. This transformation requires changes in both the educational model and faculty development programs.
The competency-based approach, although not without controversy, has been imposed in education, and particularly in medical education. It has not been easy to conceptualize it, but apparently a unified or, at least, more homogeneous vision of what this approach means has already been reached.
With the purpose to improve the quality of education in teachers, it is important to include an adequate faculty development program to educate them on the required competences according to the desired institutional academic excellence. The target of quality education can only be achieved once the quality of teachers is enhanced. This includes the development of competencies for teachers, since they are the primary agents for quality education.
Teaching in the clinical environment is a multifaceted endeavor that requires innovative approaches and must be recognized as a complex learning situation influenced by the learning content, the setting and the actions and interactions of the participants.

It is possible that we are exiting the COVID-19 pandemic and entering an endemic phase. Now would be the time for a “debriefing” to understand what we did well, and what we didn´t do so well, because surely and more frequently, we will be facing new threats involving the healthcare sector in the future.
In this context, we must apply that wise phrase attributed by some to the American poet and philosopher of Spanish origin Jorge Agustín Nicolás Ruiz de Santayana y Borrás and by others to the lawyer, journalist, politician, statesman and former President of Argentina Nicolás Avellaneda: “The people who do not know their history are condemned to repeat it.”
In that light, I would like to focus on the application of technology and other essential components in the healthcare industry whose development and adoption have been accelerated by five to 10 years as a result of facing a global threat and the confinement of large parts of the population. Beneficiaries of this acceleration include research technology and the development of vaccines, the manufacturing of medical equipment and supplies, hospital infrastructure, video consultations, teleradiology, the use of “wearables” and electronic prescriptions, among others. However, the same did not happen with legislation, regulations, telecommunications infrastructure, or the balance between pharmaceutical research and input manufacturers.
While the pandemic resulted in having vaccines in record time, monoclonal antibodies, and other drugs, it also led to shortages of other medicines due to dedicating resources and supplies to the pandemic, the overproduction of personal protective equipment due to lack of planning, and an anarchic use of technology amid a lack of an appropriate framework and parameters. The vulnerability of the healthcare systems, their lack of planning, and their fragmentation, highlighted by the lack of collaboration, were clearly and widely exposed. This is in addition to the social gap, which is dangerous and at great risk of evolving toward resentment and social unrest. It also highlights the lack of personnel. One example has been the shortage of nursing staff, who were seriously exposed to the COVID-19 disease and are an essential component of the healthcare system.
Let us remember that the pandemic is not over yet. It will be considered over when the WHO declares it. However, it is time to stop and reflect and analyze from a philosophical viewpoint in order to create precise definitions and actions that will allow us to face current and future threats more effectively than we did COVID-19. Global warming, monkeypox, the appearance of multiresistant bacteria, the mutation to a vaccine-resistant strain of COVID-19, wars, food shortages, among other threats, force us to learn and create knowledge to try to prevent or reduce risks in the most efficient and functional way possible.
In this context, it is important to meditate on the principle of socially conscious companies and industries, to be clear that, in order to create new alternatives, the first obstacle that we must overcome is the social gap, which means reducing it and in which an adequate healthcare system plays a vital role. It is important to mention two essential factors to consider: first, incompetent leadership is a serious threat to any social entity, and second, the window of time is limited and we must take advantage of it before reaching the point of no return, always remembering that the most precious non-renewable asset is time.
Q: What makes doHealth the right partner for companies in and entering the Mexican market?
A: doHealth develops innovative solutions for companies in and out of Mexico that want to expand their presence in the Mexican market. We develop information solutions to control the supply chain of medical devices and aim to generate a different scheme for purchasing and consuming, where the manufacturer, distributor and intermediaries can receive information in real time. This data can lead to savings and better research and transactions. While some large companies focus on the health economy and others on market commercialization, few focus on mixing both areas into a single business strategy.
Q: What type of companies are seeking to do business in Mexico and how does doHealth help them?
A: We work mainly with medical device manufacturers and are starting to work with pharmaceuticals, which have more robust logistics as many deliver directly. We also work with distributors and manufacturers, which require specialized solutions that we can provide based on our knowledge accrued after many years in the sector. We focus on productivity in the distribution chain. Foreign clients look for information about product demand and market size and behavior. Large companies tend to overestimate 30 percent of the market size, generating false expectations between the manufacturer and the distributor.
Q: What motivated doHealth’s international expansion and what services have been pivotal to this growth?
A: Our clients have private distributors, which get acquainted with our work and later decide to search for a market for additional products. We have grown through word of mouth but we are also building a new strategy for Latin America, where we will represent companies that have failed in their attempts to enter the region. Every region will be directed by a local leader who knows the market and can find the best distributor to develop a local strategy, allowing us to offer a strategic plan with specialized knowledge.
Q: What are Mexico’s most attractive areas of investment for healthcare?
A: The pharmaceutical industry is slowly adopting technology. Some segments are adding many digital tools but hospitals still have not recognized their value because they see it as an expense. The sector will see a domino effect if distributors start to see and implement technology: if distributors use it, suppliers will follow.

Q: What led to doHealth’s alliance with Elsevier?
A: We are looking for strategic alliances in which the objectives of both organizations overlap. This was the case with Elsevier, which has a global presence and a strong research backbone. We want to standardize digitalization to generate traceability in product consumption. Elsevier has a strong clinical vision, while we focus on logistics. We complement each other. We also have an alliance with a US radio aerials manufacturer because almost all of our solutions include technological components. We are also building alliances in Latin America with experienced professionals to enter the region, which generates value through access.
Javier Pinzón Director General | doHealthQ: How does nutriADN’s nutrition area play a pivotal role in the outcome the company expects to see in each patient?
A: Traditionally, nutrition had only been valued for its role in helping patients diet and lose weight but it can play an important role in various ailments. Through genetic and functional medicine testing, nutriADN applies precision medicine, creating personalized lifestyle treatments for each patient and creating true health for each one of them.
nutriADN’s prevention area uses an advanced genetic test to identify the lifestyle that would most benefit each individual.
This test identifies genes that determine which eating style is best for you, be it a low-carb or a balanced diet. Patients can learn which sports activities best align with their body’s natural preferences. We use this information to put together personalized recommendations to create a lifetime of optimal health.
Our clinical health area focuses on hormonal and digestive health issues. It relies on scientific evidence to determine the appropriate approach to take with each patient.
Q: As a specialist in women’s health, how has the hormonal balance test helped to treat specific diseases, such as polycystic ovary syndrome (PCOS)?

A: It is common for patients to resort to a hormonal test when they are already having some physical symptoms of PCOS, such as hair loss, acne or irregular periods. The hormone balance test gives us a complete map of the patient’s hormones, allowing us to identify what is causing the physical symptoms. This urine test result is more accurate than a blood test and gives us a precise, predictive and preventive diagnosis for future pathologies.
We promote this new model of medicine called the 4 Ps of medicine: personalized, predictive, preventive and participatory medicine. In this model, each patient enters a six-month program in which they have consultations every two or three weeks with our nutrition team.
During this process, patients make changes in their eating habits, sleeping patterns and physical activity, achieving hormonal balance again. It is crucial for us to empower our patients to see this lifestyle change as a long-term change, not just a 6-month diet approach.
Q: As awareness of health prevention expands, how are nutritionists influencing daily lifestyles?
A: We now know that nutrition plays a crucial role in the creation of health or disease. Food is not only calories; it has the power to reverse ailments and create vitality, energy and wellness. This new model of care and integration is known as functional nutrition and it is emerging all around the globe.
Functional nutrition is a model of medicine that focuses on identifying and addressing the root cause of disease and treating it through nutrition and lifestyle. This model of care is transforming what true health means to all of us and what successful treatment looks like.
Natalia Díaz CEO | Genethic Services by Sohin
CEO | Genethic Services by Sohin
Early-stage projects led by different scientific profiles, from healthcare providers to biotech companies, genomics, devices, informatics and so on, all have been struggling with a common factor: lack of funds.
Usually these startups come from labs in university settings where students and professors look for solutions to unsolved problems. They work with a strictly designed protocol and then they have to search for grants and scholarships that can support the development of the project. The ideas need to pass through academic filters, peer-review analysis and professors who dominate theory regarding the specific topic they work with. After rigorous methodological processes that involve the scientific method, and after many months — even years — of project development, they are ready for a thesis to be published. Almost 25,000 STEM (science, technology, engineering and mathematics) scientific papers are published in Mexico every year, placing us 28th globally, although we, as a country, invest only around 0.2 percent of GDP in science and technology. After the paper is published, however, there is not a clear idea of what the next steps are.
Tech startups, on the other hand are growing in Mexico faster than we could have imagined just five years ago. Currently, seven Mexican startups are valued more than US$1 billion each. Millions of US dollars flow to these startups, making the entrepreneurial arena a place where everyone wants to be. Fintech, cryptocurrencies, banking, AI and e-commerce are the main trends in developing high-impact companies. Even though these are high-risk investments, the payoff is worth it, since ROI is usually in double digits.
So, why is it so difficult to fund scientific-based startups? According to ASEM (Mexican Entrepreneur Association) only around 10 percent of their affiliated companies are STEM-based startups. In my experience analyzing these kinds of STEM startups, there are several common explanations:
1. S cience-based startups do not solve a real customer problem but a problem or hypothesis developed in the lab.
2. S cientists do not have the business and commercial skills necessary to build a real ready-to-sell solution from their technical knowledge.
3. S cholars do not have the wording and narrative, the pitch, to talk with finance and business people.
4. S cience is a long-term investment, whereas investors look for a short-term ROI.
There are several core values that comprise the scientific mindset and can give VCs a good reason to decrease their fear of STEM-based projects, including a strict and unwavering work ethic, as well as a profound social responsibility. Although there are some examples of fraudulent pseudoscientific companies, those are the exceptions. Investors: do not be afraid: get professional advice and go for them.
The knowledge-based economy should not be the sole responsibility of government policies but should be a common compromise of the private sector, through public-private alliances. Since the government should provide the laws and norms to push scientific development, the private sector could build the framework to support STEM startups, public universities and scientific entrepreneur communities.
Q: How much did the pandemic change consumer behavior regarding the consumption of health-related products?
A: There have been many changes. First, Mexicans increased their use of social networks to discuss healthy eating, exercise and motivation. Many medical professionals gained a social media following and used their platform to provide information regarding health issues, using trending formats to reach a larger audience. Second, many more people are requesting consultations through video calls, with recent studies showing that about 40 percent of patients have had at least one virtual consultation. This trend is here to stay. A recent study by the Latin American Institute of Responsible Self-Care states that 95 percent of Mexicans are satisfied with virtual consultations and 88 percent of them would use this format again. Third, having easy access to information has become the new normal. In Mexico, all health monitoring sites grew their traffic by 86 percent in 2021 when compared to 2020. Finally, the growth of e-commerce also reached electronic health devices, which grew in demand much more than any of us could have anticipated. While online sales of these devices are still limited, they are growing rapidly.

Q: How is the industry adapting to e-commerce and what challenges and opportunities have emerged from this practice?
A: E-commerce helps prevent some longstanding problems in the Mexican healthcare system, such as the lack of traceability, which is particularly common with prescription medicines. E-commerce helps to ensure that the patient buys what is prescribed, nothing more and nothing less. It also facilitates the search for highly specialized drugs, which can be difficult to find. This sales mode also provides the usual benefits of e-commerce: the ability to order 24/7 and without leaving home. It can also make recommendations based on historical purchases. It is estimated that approximately one-third of Mexicans in the last year purchased medicines through e-commerce, either at an online pharmacy, supermarket, marketplace or using a delivery app.
Q: What role should health professionals play in the shaping of marketing strategies?
A: Health professionals should be central to the process as they have the credentials to speak with authority. They also know how to explain health issues in the simplest terms possible. Health professionals also need to change their communication channels with patients and colleagues to keep informed about all aspects of public health policies. These professionals are willing to use social networks, websites and other gadgets not linked to the professional equipment used in hospitals and clinics.
Q: How have Mexican regulations adapted to the online sale of medicines and medical supplies?
A: The law is not clear regarding certain practices, including telemedicine, electronic medical records and the use of social networks to promote health services despite the growing popularity of these trends. These gray areas generate uncertainty among developers, which are taking a risk when introducing these technologies. When consumers start to adopt trends, public policies also start to move, albeit with a small delay. Even if these changes occur slowly, the changes in public health policies are taking place.
Enrique CulebroHealth Professionals Rely on
9/02/2022
Combating Misinformation
and
A Digital, Evidence-Based Community
ndrés
Ministry to Review
07/20/2022
Mexican Hospital Consortium Announces

07/19/2022
Investment in Organ Donation,
6/24/2022
CENATRA
Women Account for
6/23/2022
6 Percent
Elimination of Psychiatric Hospitals
6/16/2022
Getting Healthcare Through the Metaverse
6/16/2022
INCMNSZ to
6/07/2022
Universal healthcare is a priority for the sector. Efforts are aligned to meet that goal through timely diagnostic services and continuous treatment and care to avoid the serious progression of diseases. Providers are focusing their efforts on closing care gaps caused by the COVID-19 pandemic, which significantly delayed and paused treatment of serious chronic diseases.

At the same time, the sector is collaborating to boost prevention at all levels of care. Providers are seeking to strengthen diagnostic awareness and capabilities at care facilities to increase accessibility.
Innovation and tech are playing a prominent role in this process as support tools to aid the patient’s prevention journey. While younger generations have been the first to respond to a prevention approach to healthcare, there are many opportunities to permeate the rest of the population.

For over two years, the burden of the COVID-19 pandemic has increasingly disrupted traditional health priorities and altered the criteria for public health prioritization. This has proved harmful to the prevention, diagnosis and treatment of many diseases, which threatens long-term outcomes, warn experts.
The National Health Plan identifies chronic non-communicable diseases (CNCD), in particular cancer and cardio-metabolic diseases, such as cardiovascular disease, high blood pressure and Type 2 diabetes, as the main challenge for the health system in the country, both due to their magnitude, the great impact on premature mortality and quality of life and the costs of treatment for the disease and its complications. “One of the main risk factors that explain the increase in these chronic diseases is the accelerated growth that Mexico has presented in the prevalence of overweight and obesity,” says the National Health Plan.
A study by BMJ Global Health used health data from January 2019 to December 2020 from IMSS, which provides health services to 65 million Mexicans, to determine the disruption in essential health services in Mexico during COVID-19. The analysis included nine indicators of service use and three outcome indicators for reproductive, maternal and child health and non-communicable disease services. Results of the study found that across nine health services, an estimated 8.74 million patient visits were lost in Mexico. This included breast and cervical cancer screenings (79 percent and 68 percent, respectively) and over half of the diabetes, hypertension and prenatal care consultations. In terms of patient outcomes, the proportion of patients with diabetes and hypertension with controlled conditions declined by 22 percent and 17 percent, respectively.
“During the pandemic, the conversion of hospitals to 100 percent COVID-19 care was a mistake. There are many diseases that require continuous care and around 16 million Mexicans chose not to go to their medical appointments. In public health, risks must be communicated in an understandable, correct and brief way to patients. The stay-at-home policy confused many people. Staying home impacted the health decisions of many families,” explains Carolina Gómez, Public Health Consultant. Facing these issues calls for structural changes that would take years to achieve. “However, a technology-based strategy can help. For example, telemedicine would allow doctors to provide primary care without being next to the patient, making the provision of care more uniform,” explains David Kershenobich, Former Director General, INCMNSZ.
According to Kershenobich, this telemedicine-based strategy would foment the homogenization of health services in an equitable way, which requires a referral and counter-referral system where patients know when, where and how they are going to be treated. “These services can actively regularize the provision of care in Mexico and record information about the country’s epidemiology, fostering clinical and basic research,” he says.
Director Medical Affairs | Stendhal Pharma
Health Technologies Coordinator | Funsalud
Patrick Devlyn
President of the Health Commission | CCE
Fernanda González Lara
Head of the Clinical Microbiology Laboratory | INCMNSZ
Olga Martínez Montañez
Regulatory Coordinator and Direction of Economic and Social Benefits | IMSS

As economies overcome the acute phase of the COVID-19 outbreak, industry experts expect a wave of deaths associated with the discontinued treatment of these diseases. Continued synergy between public and private institutions, financial investment and technology applications is fundamental.
“COVID-19 arrived in Mexico at a time when the country had the worst health index indicators of all 38 OECD members. That is, Mexico is the country with the least investment in health per capita, highest mortality rate, greatest proclivity toward diabetes, obesity, low rate of practitioners and many more problems,” says Olga Martínez, Regulatory Coordinator and Direction of Economic and Social Benefits, IMSS.
“During COVID-19, there was a loss of roughly 20 percent of consultations related to diabetes and hypertension, resulting in the deterioration of patients’ health, according to data from IMSS. This trend was reflected in other detection and diagnosis consultations that will likely lead to a wave of CNCD cases in the coming years if we fail to address the gaps created,” says Fernanda González, Head of the Clinical Microbiology Laboratory, INCMNSZ.
After years of completely focusing on the pandemic, the sector and its players are finally beginning to pivot away from COVID-19, a necessary step in addressing care gaps. For example, FunSalud is working to “strengthen Mexico’s public-private partnership through its first ever agreement to address hospital reconversion, allowing people who are not suffering from symptoms related to COVID-19 to receive medical attention and, while woefully insufficient at a macro level, it is a step in the right direction,” says Santiago March, Health Technologies Coordinator, FunSalud.

The observed inter-collaboration of all public and private institutions during the COVID-19 pandemic outlined the productive capacity that can be achieved when these parties come together.
“To address this gap and increase efficiencies, public and private investment will be key to higher quality, cost-effective care,” says Patrick Devlyn, President of the Health Commission. CCE.
“Even before the COVID-19 pandemic struck, almost 1 billion people were spending more than 10 percent of their household budget on health,” says Juan Pablo Uribe, Global Director for Health, Nutrition and Population, World Bank. “This is not acceptable, especially since the poorest people are hit the hardest. Within a constrained fiscal space, governments will have to make tough choices to protect and increase health budgets,” he adds.
Q: How do INCMNSZ’s alliances support medical practice improvements?
A: The relationships the institute establishes with other entities, such as governments, academia or research institutions, are fundamental. INCMNSZ actively participates in international projects that became even more important during the COVID-19 pandemic. We have close relationships with many other actors that allow us to generate better results in medical care, education and research.
Q: How will medical institutions benefit from tech integration?
A: Advances in medicine resemble advances in technology. The institute has focused on incorporating new technologies to keep up to date and fulfill our responsibilities as a national institute. In the past two years and despite the pandemic, the institute was recognized as one of the best highly specialized hospitals in the world by the media and the data platform Statista. This is thanks to the incorporation of technology.

The institute worked for five years to develop a functional ECR adapted to its own needs, which required weekly meetings with the medical, paramedical, nursing, radiology and laboratory staff to build a responsive record. The ECR is now fully functional and the institute avoided having to buy an external ECR that would not necessarily have adapted to its needs. Our ECR allows us to generate databases for medical practice, teaching and research and allows patients to schedule appointments, consult lab results and access telemedicine sessions. The institute is developing its own telemedicine platform with full data security and making it accessible to the general population. Telemedicine brings many opportunities but does not replace the doctor-patient relationship. It cannot be used for a first-time consultation and can only be used by selected patients.
During the COVID-19 pandemic, we used these two tools to have the same number of patients online and in person, considerably reducing the saturation of our services. Our tools are available to other institutions and we have created care models that can be applied elsewhere.
Q: The institute developed a ventilator in record time to address the COVID-19 pandemic. How is the institute encouraging these types of R&D projects?
A: Innovation is essential to keep us up to date as a medical center and education and research institution, so we adopt innovative trends that emerge worldwide and also conduct innovation in-house. For that reason, we have created an intellectual property unit. This unit does not aim to generate economic resources but to protect the institute’s research and development.
During the COVID-19 pandemic, we realized that our biomedical engineering department, which is responsible for maintaining over 1,200 pieces of equipment installed in the institution, had the capacity to develop a ventilator. This ventilator was named after Dr. Salvador Zubirán and the year in which it was developed: VSZ-20. The institute is also able to develop many other medical devices, such as laryngoscopes and 3D equipment, alongside universities like UNAM and IPN.
David Kershenobich Former Director Director General | INGER
Director General | INGER
Truth be told, healthcare does not create health. It repairs or mitigates the effects of damage coming either from the environment or, less frequently, from within. No one can deny that this is essential and gallant work but largely reactive. The true causes of health and illness, and of inequities in health, are clear and have been documented over a long period. Yet, the current situation places nearly all investment into the “repair shop” of healthcare.
Rarely taken into consideration, the financial costs of this unfair investment are massive and the toll on human healthy aging is even more concerning. Although some of the variations in people’s health are genetic (25 percent), most is due to people’s physical and social environments, including their homes, neighborhoods and communities, as well as their personal characteristics, such as their sex, ethnicity or socioeconomic status. The environments that people live in combined with their personal characteristics have long-term effects on how they age.
The healthcare system’s contribution to health is important, hard fought and currently achieved by a dedicated clinical workforce. But 40 percent or more of the variation in health status (two times healthcare’s share) derives from social determinants of health. Michael Marmot summarized these in five categories: early childhood experiences, education, workplace conditions, supports for aging and community resources, such as food and housing security, recreational opportunities, transportation, environmental protection and approaches to preventing and managing violence. Marmot suggests there is a sixth critical factor that he calls “fairness,” implicating attitudes toward solidarity and equity, including ageism and racism.
Most healthcare leaders assume that running the healthcare system is already a big enough task without having to address health determinants as well. But the healthcare industry is not an innocent bystander in the world’s underinvestment in determinants of health; it is a cause. On this issue, 2020 was a turning point. The pandemic put a spotlight on existing societal issues, accelerated the pace of change in others and created some new ones, too. Concerns about inequalities in health became more apparent to a larger number of people during these last two years. The speed and openness of the societal conversation, beyond the direct effects of COVID-19, create an opportunity and a motivation to reassess our understanding of health. Even more important, it is an opportunity to reduce inequities related to who has access, who uses and who benefits from the resources that promote health and well-being.
To this end, several questions could guide thinking about health and health inequities from now on, broadening the meaning of health to include the capability to adapt and be resilient and leading to questions, like what are the policies to be developed to support and promote health?, who has the power to shape these policies? and whose interests do current structures and policies serve?
To catalyze changes, healthcare organizations with the means to do so should establish and support actions that are focused on the social influences on health in the region served by the organization, which could include the following: interventions to improve health coverage, educational support or acting on highly relevant issues, such as older adults and loneliness.

For months, the topic of a potential recession has been all over the news. The most recent sharp economic downturn of 2008-2009 as well as the 2020 COVID-19 recession provide some examples of what specific impacts we can expect in the field of healthcare.
One relatively “positive” outcome is that for many healthcare and medical specialties, the shortage of qualified staff may be reduced. Industry experts predict severe shortages of healthcare practitioners and support staff in the coming years. The use of temporary providers has been one solution to this problem. However, during an economic downturn, the use of temporary healthcare professionals will likely not be in as high demand. This is because demand for some medical treatments would drop.
During economic periods when financial margins are constrained, some consumers will defer healthcare to save money as patients are forced to prioritize spending on other necessities and reduce spending on healthcare services.
People will still need to seek treatment for more serious diseases, but they will attempt to skip treatments for minor, non-lifethreatening conditions. A similar trend is visible when examining data on hospital admissions related to elective surgeries. People will delay elective surgical procedures. In turn, these actions create substantial financial problems for surgical centers, hospitals, and health systems. However, this situation also created opportunities, as healthcare spending decreased and there was an increase in the movement to expand outpatient care options.
In open market economies, the interactions between employment, health coverage, medical costs and access to quality care can be complex. A variety of details, both seen and unseen, can change the outcomes and costs of healthcare. Factors such as the demand or access to healthcare may coincide or conflict with a healthcare organization or medical practitioner’s financial incentives. When a recession occurs, the private healthcare industry can experience reduced demand for non-urgent or elective care, which decreases overall revenue. On the other hand, government-owned systems like IMSS in Mexico experience an increase of demand for their services, putting more strain on an already overstretched infrastructure.
All these factors can greatly increase the write-offs and delinquent accounts, forcing hospitals and practitioners to adapt to severely reduced cash flows. Many physicians and other healthcare professionals are establishing new financial arrangements to help stabilize their income. One example is to use the equipment they already own as a source of cash flow.
Another consequence is that we may see delays in the decision to acquire large-ticket medical equipment as hospitals and clinics struggle to obtain the cash flow needed for their operation. This may also increase the demand for used and secondary market equipment as some clinics can’t delay replacing or buying equipment that is essential for their operation, such as imageology.

Human development is associated with quality of life and community access to healthcare services, including state-managed healthcare and private services at hospitals, drugstores, outpatient services and specialized care. For this reason, a high-quality, free and affordable healthcare service is essential for a better quality of life.
In 1966, the UN General Assembly recognized the right to universal health coverage and in 1976, that right was enacted in 160 countries. It highlights that every person should enjoy the highest possible level of physical, mental, and social health, which should be managed by the government, with the aid of private institutions, to provide affordable healthcare to all individuals.
According to the 2020 National Survey on Health and Nutrition, ENSANUT, the country has a healthcare gap, with socioeconomic and geographic components, which is more prevalent when complicated procedures, higher number of visits or large amounts of money are required, especially when a user must pay for about 47 percent of the total amount of their treatment. Another factor regarding medical attention is time, including time spent commuting, waiting times for a visit or a procedure, time off from work or school and the limited leeway with regard to service times and calendars, all of which leads many patients to disregard followup, resulting in the worsening of their condition.
For 30 years, Farmacias del Ahorro has been committed to offering Mexican families health-related relief, care and savings. We have been working to strengthen the health of Mexicans through technological progress and innovation in well-being to bolster the number of people who can count on high-quality, low-cost healthcare services and commodities. As a healthcare company, our actions, strategies, and programs are focused on being an ally for both the public sector and individuals. One of our core commitments is to be close to any person who needs us. With our 1,700 doctors in more than 1,500 branches in 28 states and over 320 cities, we can offer healthcare solutions to all Mexicans.
Information and Communication Technologies (ICT) have shown a positive impact on individual and public health. These support and improve information collection, analytics, management, and exchanges in all health-related areas, improving diagnostic, prevention and treatment tools. As a result, in 2020, we were able to widen our free medical advisory solution by going virtual, and we continue to offer healthcare solutions remotely.
Following up with our commitment to care for the health of the Mexican people, we have focused our efforts on becoming a healthcare ally that can answer questions and meet healthcare needs both in the drugstore and in the palm of their hands. That is why in 2021, we added the Salud en Línea (Online Health) service through our mobile app, our webpage, and via WhatsApp. It is a service that includes appointment management, healthcare advice, and medication purchases so that all Mexicans know they have a healthcare ally at all times.
Considering the outlook in Mexico, and the challenge of providing universal health coverage, both the private and public sectors must walk hand in hand toward the same objective: a healthcare system that will reverse inequality and ensure equal access to quality preventive and curative healthcare.

We often get asked if Sofía is an insurtech and our is often “well … yes, sort of.” We do not really like the moniker of being an insurtech company because, yes, we operate an insurance company and yes, we use and love technology but that denomination does not capture what we are really building. I would like to lay out what that is.
Our mission, improving the way millions take care of their health, tells us that we exist to make a change in healthcare. Then why bother becoming an insurance company? It sure seems like a lot of work to do something that is not your end goal. The answer is that to positively affect in a meaningful way someone’s health, we need to be able to have long-term relationships with our users. This belief stands on two pillars. First, most of the time, people are relatively healthy. The second pillar is that even though we are for the most part not ill, it is also true that we often do not have the healthiest habits in some area or another of our lives.
The need to form long-term relationships with our users leads us to our business model as an insurance company. Most business models in healthcare are focused on points in time at which individuals seek care, with health insurance. However, we engage prior to these moments (which allows us to underwrite the risk of potential future illness) and after such episodes (which allows us to accompany our users in the aftermath of the illness, both financially and in terms of care). So, we created a health insurance company.
In the industry lingo, health insurance companies are payers but our aspiration is to improve healthcare, not only healthcare financing. Our first hire was a physician and this was not random. We recognize that for us to be able to deliver on the promise of developing long-term relationships with our users, both financial and health-centric, it is not enough to cover the bills. We have a dedicated medical team that is tasked with developing and implementing care protocols that we deploy through our network of partners, SofíaMed, which, crucially, also directly provides care. Today, this happens in the form of the Dr. de cabecera, which we assign to each one of our users and which provides a consistent point of contact for any care need. Over time, we will add new types of care that we will deliver directly by Sofía, both remotely through different forms of telemedicine, and also in-person care. We are encouraged by examples of how these models work at scale in other countries, like Kaiser Permanente (KP) in the US.
KP was created in the first half of the 20th century, a point in time at which computers were far from commonplace and the internet would not be invented for a couple more decades. If KP were to start today, the end result would look very different. You would make different decisions at an innumerable set of junctures. If you were to synthesize this process into one central difference, it would be that you would not arrange the whole system around a physical location, like a hospital. Instead, you would organize the whole system around information. To put it another way, the main access point for the system would not be the hospital building but the cellphone that everyone carries in their pocket.
So, if we were to pick a buzzword description for Sofía, it would not be “health insurtech” or “the Uber of health insurance.” Rather, it would be something along the lines of “The Kaiser Permanente of Latin America, if it had started in the 2020s instead of 1940s.”
Chronic diseases are imposing a high burden on global health systems and individuals. The well-being, productivity and financial stability of countries are being affected by death tolls dominated by cardiovascular diseases, cancer and diabetes. If preventive action is not taken, a fatal scenario will be inevitable, experts say.
Chronic diseases lead to costly medical expenses. The Medical Expenditure for Chronic Diseases in Mexico: The Case of Selected Diagnoses Treated by the Largest Care Providers study by PLOS One, found that the most expensive chronic disease for Mexico’s Ministry of Health (SSA) and IMSS was CKD, with an annual unit cost per patient of US$8,966 for SSA and US$9,091 for IMSS. CKD, hypertension, Type 2 diabetes and chronic ischemic heart disease accounted for 88 percent of the total chronic disease burden (US$1.42 billion) of SSA and 85 percent (US$3.96 billion) of IMSS.
In Mexico, the rates of diagnosis and treatment of chronic diseases are considerably low. WHO estimates that Mexico has around 8.7 million people suffering from diabetes but there might even be 12 million people living with the disease without a diagnosis. The latter not only increases risks for people with the disease but it also raises costs and impacts the country’s productivity. This low tendency to seek a diagnosis has driven care providers to develop novel solutions that make access easier and that help detect any anomalies prior to advanced stages of the disease. Experts call this approach unconventional medicine. “This approach focuses on addressing the root cause of the disease. Each symptom or diagnosis may be one of many contributing to an individual’s illness,” says Gustavo Rodríguez, Founder and CEO, nutriADN.
Technology advancements, such as mobile health, which is healthcare supported by mobile systems and devices, have made real-time detection of health changes a reality. This is essential in chronic illness management to improve health outcomes, quality of life and cost-effective healthcare. For in-hospital or facilities solutions, tech is also revolutionizing diagnostic solutions by creating more patient-friendly devices. IMSS is also investing in novel Protocols of Integral Attention (PAI) for Chronic Diseases, which focus on promoting early detection and diagnosis of these diseases. “The PAI will provide primary attention. Medical and nonmedical professionals will be enrolled in preventive activities: diagnosis, treatment and integral rehabilitation,” says Gabriela Borrayo, Coordinator, IMSS. The PAI was created after years of scientific research to offer quality medical attention to patients affiliated with the institute.
Nevertheless, patient associations, through the Network for Comprehensive Attention to Chronic Diseases, are still demanding the government guarantee universal access to health through early diagnosis, management and comprehensive care of these diseases. To make this a reality, it is essential to migrate from specialized to primary healthcare. “This way, we can foster the concept of earlier detection and implementation of preventive medicine at different stages of the disease,” says David Kershenobich, Former Director, INCMNSZ.

Biotechnology has a global technological, economic and social impact and the Bio International Convention is its mecca. Every year, this event gathers more than 15,000 pharmaceutical and biotechnology leaders from over 65 countries, who, for four days, have the opportunity to link organizations from diverse backgrounds, including those related to technological supply and demand.
At a global level, Latin America and the Caribbean provide important resources to the biotechnology sector at the input level as 40 percent of the world’s biodiversity is found there. Contributions are also observed at a scientific and technological level. In the last 15 years the region has doubled its production of biotechnology publications in health, mainly due to a push from organizations and individuals from Brazil and Mexico. The region has also increased its numbers of patents thanks to the efforts of universities from Brazil, Mexico, Argentina and Chile.
Mexico offers opportunities and strategic advantages to the global life sciences industry: it is the 11th-most populous country in the world with over 130 million inhabitants; the population mix is young, with nearly 27 percent under the age of 15 and only 7 percent in the group of 65 years and older; and the leading causes of death include diabetes and ischemic heart disease.
The pharmaceutical industry has a strong presence in Mexico, with about 400 laboratories that manufacture pharmaceuticals and employ around 65,000 people. Twenty of the 25 largest pharmaceutical companies in the world have operations in Mexico. The industry is concentrated mainly in Baja California, Jalisco, Mexico, Mexico City, Morelos, and Puebla. A wide range of products, including antibiotics, cancer treatment products, OTC medicines and vaccines are manufactured in the country.
Regarding foreign direct investment in Mexico, from 2015 to 2020, the pharmaceutical and medicine manufacturing sector observed a compound annual growth rate of 95.84 percent, whereas the medical equipment and supplies manufacturing segment experienced an annualized growth rate of 17.38 percent.
In the last few years, Mexico has been consolidating its value chain at different levels, offering opportunities to exploit potential competitive advantages supported by:
1. E xtensive capabilities and infrastructure for research, technological development, and technology transfer.
2. Diverse public and private institutions that offer clinical research with international recognition.
3. A globally competitive and well-positioned industry for manufacturing and innovation in life sciences.
4. Strategic allies that collaborate to strengthen the health innovation ecosystem.
5. Government organizations in the healthcare sector that focus on simplifying the approval processes for registrations and public purchases.
For this Bio International Convention 2022, a group of 18 organizations from Mexico that participate in different links within the value chain will share their global knowledge and experience in the life sciences industry. This is a great opportunity to show not only the potential that Mexico can offer in technology manufacturing but also in research and development, clinical research, and innovation.
Q: How can collaboration between private entities and academic institutions boost R&D and, consequently, innovation?
A: Academia should lead innovation but the organic statutes of universities have not been updated. Despite the existence of a science and technology law that allows the creation of clusters between private entities and universities to launch innovations to the market, universities´s organic statues still do nor facilitate the development of innovation. Researchers and scientists must be supported and motivated to profit from more than just the publication of articles. In Mexico, the science community has always been awarded for publishing scientific papers. The generation of technology is not a priority for scientists because the field of innovation and technology has never been relevant in the country. A new generation of scientists, with a different perspective of innovation is coming but it will take about 30 years for this to become a reality.
Q: What is the benefit of Breakthrough IP partnering with the Jalisco state government?

A: This partnership proves that networking is essential for innovation. The government of Jalisco has a budget for innovation and IP. As of today, Jalisco is the only state to set aside a budget specifically for generating, protecting, and taking innovation to the market though different public programs, which are used to support anyone who needs IP consultancy in technological fields. Jalisco is the only state with programs of this kind, which is allowing it to become a leader in technological development. We operate across the entire country and a similar project in other estates would make innovation blossom.
Sometimes, we also work pro bono to support interesting or high-potential projects that do not have the resources to access a consultancy regarding IP because we are committed to promoting innovation and development.
Q: The USMCA aims to help Mexico modernize its legal framework regarding IP. What has been the impact of this treaty to date?
A: Although the new Federal Law for the protection of IP law has very good improvements, it did not align Mexico with the legislations that exists in other countries. It is hard for Legislators understand the correct balance between different players in the system. For example, the current administration is not correctly balancing the interests of pharmaceuticals, which are those who innovate, with the access to. The interests of all actors have to be heard and addressed equally.
Additionally, the current law has a lot of typographic mistakes, and it is somehow surprising that legislators did not pay attention to that. We all know it is difficult or practically impossible for legislators in Mexico to understand the impact that their actions can have as they occupy legislative positions because they were chosen not because of their knowledge but because of their popularity; and this not wrong, the problem is, that they do not take the time to hear the different positions of the different actors in a certain ecosystem.
 CEO | HempMeds
CEO | HempMeds
Icould say that the last 15 years have been the best years of my life; these years have also been the most challenging. During these years, I started my family and had the chance to be part of a paradigm shift that settled the ground to create the cannabis industry in Mexico and around the globe.
My daughter, Graciela, was born 15 years ago. From the beginning, my wife, Mayela, and I had to experience the suffering that thousands of families have when they see that a loved one suffers from a rare medical condition. These events have a huge emotional, social and economic impact on people’s lives. Still, I must say that the most challenging part is the inability to find a proper solution to improve the life quality of the ones we love.
In 2015 and due to Grace’s medical condition, I decided to take advantage of my experience as a lawyer. Along with a legal firm, we processed the first injunction that would allow us to import a product derived from cannabis. It was the same product that previously had become a solution to the medical condition of a girl in the US and we were able to help reduce the more than 400 epileptic crises that Grace had every day. Because of that decision, my life and the life of millions of people with neurodegenerative diseases changed. After that first legal battle, I was able to help hundreds of families, making their legal journey easier and allowing them to access nonpsychoactive cannabis-derived products legally. This also became part of a journey that led me to participate in national and international debates and forums about the uses and benefits of cannabis to improve people’s health. We laid the foundations for the change in Mexico’s General Health Law in June 2017. This change in the law became a turning point for an entire industry. It was also in 2017 when I was invited to the World Health Organization’s Committee of Experts on Drug Addiction and became part of an analysis regarding the classification and characteristics of cannabidiol, or CBD, that concluded that it is not a psychoactive substance and recognized its therapeutic potential.
In recent years, I’ve been part of the political and social changes that allowed the development of the cannabis industry, starting with the promulgation of the Cannabis Act in Canada and the signing of the Farm Bill in the United States —changes that made growing and processing hemp legal throughout North America. These two moments in international politics became the cornerstone that opened an industry that, in 2022, could reach sales of US$33 billion just in the US.
In addition to the regulatory changes, the cannabis industry is experiencing social changes. People are not looking for a plant to smoke for recreational purposes; they are looking for products that help them feel better, fight stress, rest, or enjoy general wellbeing. And that is the main achievement of products with isolated cannabinoids, to the point that sales of cosmetic products with CBD totaled US$3.07 billion in 2021.
Because of all these changes, these last few years have become my life’s best and most challenging. My wife and I found a solution to our daughter’s medical condition and I have been closely involved with the changes in the cannabis industry, seeing how it has become what some analysts consider the industry of the future. Countries rush to adopt laws that allow its use for industrial or recreational purposes, seeking the tax revenue that it entails, as in the case of the US, where the recreational marijuana market garnered around US$3.7 billion in taxes in 2021.
 Vice President and Market Head Latam North | Ecolab
Vice President and Market Head Latam North | Ecolab
In all food-related industries, maintaining and ensuring food safety is vital to the business, since the reputation of companies that produce, prepare, serve, package or market food, as well as those that offer medical or health services, depends on it. Poor food handling or sanitary control can lead to losses that could represent economic costs or damage to patients’ health.
Why is it important to disinfect surfaces? Cleaning and disinfection help to eliminate pathogens or considerably reduce their concentration in contaminated areas. To achieve the highest level of disinfection, methods, detergents and soaps and disinfectants suitable for the task are indispensable, otherwise site and food safety might be compromised.
According to WHO, one out of every 10 people fall ill from eating contaminated food and more than 200 diseases are caused by the ingestion of bacteria, viruses, parasites or chemical substances that may be in food. In Mexico, according to the Ministry of Health, there are 6 million food or water-borne illnesses each year.
There are several determining risk points that can trigger cases or outbreaks of illnesses caused by food pathogens that are directly related to surfaces: inadequate sanitary infrastructure, deficient hygiene protocols in water used for cleaning, lack of monitoring of the environments with which food comes into contact, existence and proximity of pathogen carriers, ineffective surveillance system and deficient personnel training. Food safety starts with hygiene protocols that include best practices for employee cleaning, disinfection of equipment used to process, prepare or serve food, as well as the use of detergents and cleaners to disinfect a wide variety of surfaces.
At this point it is important to remember that cleaning and disinfection of surfaces is not limited to food. In the healthcare sector, it is also of vital importance. In medical facilities, for example, a multipronged approach, including protocols, monitoring, training and auditing, is required.
It is worth mentioning some practical examples to emphasize the need of protocols, manuals and constant training for those who perform cleaning and disinfection tasks. According to WHO, in its Manual on Cleaning and Disinfection of Surfaces, “cleaning should proceed from the least dirty areas to the dirtiest, and from top to bottom so that debris may fall to the floor and is cleaned at the end; one must proceed in a systematic way so as not to skip any area. During the cleaning process, detergent or disinfectant solutions used in the process become contaminated and gradually lose their effectiveness when there is a lot of organic matter. This is the fundamental reason to use and dispose of used detergents or disinfectants according to the manufacturer’s recommendations.
When selecting soaps, detergents and disinfectants to be used, the type of surface, its function, the type of materials or pathogens to which it is exposed, the indications for its handling and the compatibility between each of the products to be used must be taken into consideration. In addition, the personnel performing the cleaning and disinfection tasks must wear Personal Protective Equipment (PPE) due to the concentrations of active ingredients in the solutions used.
 CEO | Clínica Responsable Operativa, S.C.
CEO | Clínica Responsable Operativa, S.C.
During the pandemic, how did the pharmaceutical industry optimize its employees in such a critical situation? The essential foundation for getting your employees to take ownership of their roles is to give them a game worth playing. Was the homebased office a game everyone wanted to play? There was a need to create an environment where people want to give their personal best to support the team effort. How do you create an environment at home?
In some instances, most business owners had not put enough care or attention into establishing the rules of their game. This was a new game. The result was that both employers and their employees ultimately had to make up their own rules as they went along. There was a need to establish clear agreements. In this new scenario, managers and employees had to establish transparent undertakings about what work was to be done and how and when it was to be done – a timeline for deliverables. People were sent home and expected to work just as they were in the office. Did they work the same? Did they work less or more? Were not the hours on their computers endless? Video-calls seemed to go on forever. If we did not clearly express the exact results, work accountabilities, and standards that employees were expected to maintain, then managers were/are essentially managing by abdication.
The goal was to establish an environment that operated under what is referred to as management by agreement and this could only be achieved if expectations, accountabilities and standards were comprehensively communicated and formally acknowledged, resulting in mutual agreement. Clear communication was/ is essential – as it has always has been. However, we were not “together” anymore. We were distant – not in the same office where we could sit down and work shoulder to shoulder, when discussing an objective over a cup of coffee could lead to intense and productive brainstorming. Any changes in the nature or scope of the work (either specific projects or overall levels of accountability) had to occur only after there was mutual agreement between the manager and the employee.
Just as agreements were made about the work that was to be done, an agreement had to be reached on anything that might deviate from the expected results, work, standards, environment, etc. Were these changes taken into consideration? How have we worked from home with spouses and children in the same room? It was a difficult and very disruptive situation to say the least. During this time, a number of issues arose. Among them – and because we had no clue as to what was happening – exceptions had to be reported immediately. The employee and the manager were accountable for notifying each other immediately about any changes or exceptions to established agreements. So many changes for all.
No matter how well you establish the rules of your game in the beginning, you must always have a way to keep track and confirm that everything is going according to plan. When you have so many video calls, webinars, courses, can you keep up with periodic check-ins? There are no exceptions. Some employees are very dedicated and really online, while others are online but just “around” and not really engaged. Even in this situation, failure to notify each other of changes, exceptions or missed due dates is unacceptable. Period.
Leveraging Tech to Improve Chronic
Diagnosis,
0 8/31/2022
How P4 Medicine Will Transform
and Societ y, Part
G ustavo Rodríguez Leal
and CEO | nutriADN
Let’s Break the Myths and Make a
S ergio Medrano
Director | Be The Match® Latin America
Noncommunicable Diseases
of Lives Per
0 8/17/2022
IMSS Introduces New Public Health Program: PREVENIMSS+
0 8/12/2022
New Clinics to Treat Stomas,

07/19/2022
Infusion
Labor Law Reform to Include More Occupational
07/05/2022
López Obrador to ‘Rescue’
0 6/28/2022
AI-Based Medical Devices Need Clear
0 6/22/2022
Gender
0 6/20/2022
One of the first determinants of access to new health solutions is financing. In this chapter, pharmaceutical companies introduce the concept of pharmacoeconomics, the branch of economics that uses cost-benefit, costeffectiveness, cost-minimization, cost-ofillness and cost-utility analyses to compare pharmaceutical products and treatment strategies.
Meanwhile, medical devices companies are exploring value-based models for the development and market introduction of their solutions. Providers in this segment are also moving away from merely transactional products to truly practical and contextualized research to enhance the use of their devices.
Providers are also asking authorities for a speedy approval process for innovations, as well as an updated framework that will enhance market access for novel solutions.

Pharmacoeconomics:
Pharmacoeconomics:
Fernández
Vice
Fogarin | Managing Director
and General Manager Mexico | Teva Pharmaceuticals
| Organon
Yessika
| Medical Affairs Director, Pfizer Mexico | Pfizer
Carlos López Patán |
Laura Tamayo |
Patient Centricity
of
Márquez
Zabulanes
Galindo
Informatics
Sustainability
BSCI
Public Affairs Lead |
Masimo
Alejandro Preinfalk | President and CEO and SVP Digital Industries Siemens Mexico, Central America and the Caribbean | Siemens AG
Thomas Gibson | CEO | MedGlobal
Soto | Chief Marketing Officer | MedGlobal Group
Garduño |
CEO |
Mexico is still battling with treatment shortages that have only worsened due to the dwindling budget assigned to the healthcare sector. A thorough analysis of innovative therapies and their long-term impact on patients, beyond their initial cost, could prove a boon for the burdened health system, however. Pharmacoeconomics can be defined as the branch of economics that uses cost-benefit, cost-effectiveness, cost-minimization, cost-of-illness and cost-utility analyses to compare pharmaceutical products and treatment strategies. “What a healthcare system saves in unnecessary treatments can be used in more medications, medical devices or diagnostic tests for more patients,” explains Herman Soto, Founder, HS Estudios Farmacoeconómicos.
The first key component when carrying out a pharmacoeconomic evaluation is the identification of the various costs involved, which are usually direct medical, direct nonmedical, indirect and intangible costs, according to Pharmacy Practice. The second component of this economic analysis is the outcome to be measured or the expected benefits from an intervention. This analysis looks to integrate all the different impacts on a patient’s life as a result of the intervention. “The defined benefits can be measured in natural units and utility units. For instance, natural units can mean years of life gained or events prevented, such as strokes, surgeries, among others,” explains Pharmacy Practice. Utility units are frequently informed by some measurement of “quality of life” in different disease states. These, Pharmacy Practice explains, can be physical, social and emotional aspects of the patient’s well-being, which may not be directly measurable in clinical terms.
Time also plays a fundamental role in these studies. “The choice of time horizon is an important decision for economic modeling and depends on the nature of the disease and intervention under consideration and the objectives of the analysis,” says Pharmacy Practice. The time to begin the studies usually is during the clinical development stage of a drug, including some post marketing research. “Once a drug is marketed, epidemiological studies to understand the natural progression of the disease comorbidities and treatment would enable estimation of the variables that might have pharmacoeconomic implications with regard to cost of illness and quality of life,” says Lyle Bootman, author of the Introduction to Pharmacoeconomics essay.
There is still little data on pharmacoeconomics in Mexico; however, the Professional Society for Health Economics and Outcomes Research (ISPOR) studied Mexico’s evaluation scheme of treatments for people in terminal phases and found that the Basic Table and Catalog of Health Sector Supplies (CBCISS) is considered an essential instrument in the regulation for the introduction of health technologies. Meanwhile, the General Health Council (CSG), as a national health authority, complements, converges and aligns the efforts that the different health institutions make to update the CBCISS, using mechanisms based on scientific evidence, standardized criteria and transparent processes, focused on the health needs of the Mexican population.
Juan Luis Serrano
Partner Life Sciences | Sanchez Devanny

Rafael Gual
Director General | CANIFARMA
Mauricio Rodríguez-Leal

Commercial Director | Apotex
David de Pinho General Manager | Sanofi
Cristian Von Schulz-Hausmann
Managing Director and General Manager | Merck
Sandra Sánchez-Oldenhage President and CEO | PharmAdvice
Agrowing number of entities are embracing pharmacoeconomic studies to determine if the cost of a medication or medical device is justified in comparison with the benefits it brings. Despite the benefits, the lack of communication between healthcare providers and companies is limiting the adoption of new medicines, say experts. “The pharmaceutical industry is increasingly performing pharmacoeconomic analysis prior to presenting a product to the market,” says Rafael Gual, Director General, CANIFARMA. “With pharmacoeconomics, we can know how many lives a product can save and how long it can prolong the patient’s life.”
In the past few years, pharmacoeconomic have become more common in Mexico due to the pressure the health sector faces from limited budgets and changing reimbursement incentives, explains Sandra Sánchez-Oldenhage, President and CEO, PharmAdvice. “The main objective of pharmacoeconomics is not to provide less expensive products and services but to improve health at a lower cost,” says Sánchez-Oldenhage. However, decision-makers are sometimes discouraged by the fact that pharmacoeconomic analysis is mostly focused on the long term, while the need to save costs can be urgent. “The development of pharmacoeconomics in Latin America is incipient. This topic has been discussed during the past 20 years but more technical training is necessary to make decisions,” says Cristian Von Schulz-Hausmann, Managing Director and General Manager, Merck.
“Pharmacoeconomics should drive the conversation between countries to facilitate healthcare access and increase investment,” says Mauricio Rodríguez, Commercial Director, Apotex. Collaboration between countries should also be encouraged to improve and accelerate access to treatments, as it normally takes between 10 and 15 years to launch a new medication. “The Constitution tells us about the right to health framed in laws that define the distribution of resources, funds and budgets that must be allocated for the provision of health services,” says Juan Luis Serrano, Partner Life Sciences, Sánchez Devanny.
Moreover, the fragmentation of the Mexican health system and the lack of efficient regulatory processes are hampering the capabilities of pharmaceutical companies to accelerate access to the latest treatments. Although the system is not perfect, David De Pinho, Country Lead, Sanofi, says that there is no such thing as an ideal health system and that collaboration should be the focus of the industry. “We have to change our demanding tone to a more constructive one,” he says.

Q: How did API production strengthen Teva’s operations during the COVID-19 pandemic?
A: The API unit is a highly sophisticated part of the organization that provides us with flexibility by producing active products to be elaborated into medicines in manufacturing sites, both of Teva and of other pharma companies. The proximity to a large market like the US also gives us numerous advantages.
Teva explored multiple ways to supply patients, hospitals, governments with products they needed during the pandemic. In Mexico, during the COVID-19 pandemic, Teva was able to offer a variety of products, such as anesthetics for patients who needed to be intubated because of COVID-19 complications. Teva was an important partner during the health crisis thanks to our integrated approach to API manufacturing, logistics and commercial abilities in the region.
Q: Regarding biopharmaceuticals, what are your plans for the Mexican and the international markets?
A: Teva aims to have a strong presence in the generics market, but also prioritize other areas and develop new products. The company has invested over US$1 billion in R&D globally to develop products like Copaxone, which treats multiple sclerosis, and Austedo, a treatment for Huntington’s disease. We are launching the latter product in Latin America later this year and in the US it launched about 2 years ago.
We also launched Ajovy in the US, Israel, China and more recently in Latin America to treat chronic migraine, a disease that makes people suffer severe symptoms for multiple days, leading them to withdraw from normal life. We will launch this medicine in the next couple of years in Mexico. Teva is also planning to enter the biosimilars industry, which provides more alternatives for patients and healthcare systems to manage costs and reduce budgets.
Q: What barriers hinder the use of biosimilars in Mexico?
A: Some countries in Latin America have been using biosimilars for some years, such as Colombia and Brazil. In Mexico, review processes need to be clearer so the industry can understand the criteria it must follow to get these medicines approved. In late 2021, COFEPRIS joined the International Council for Harmonization of Technical Requirements for Pharmaceuticals for Human Use (ICH), which will lead to the simplification of these processes and allow the field to progress. Private and public institutions have also helped establish a path forward for their inclusion into healthcare systems. Teva aims to collaborate with patient associations and key stakeholders across the country for a better understanding of the patient´s journey.
Q: How did the digitalization boom that occurred during the COVID-19 pandemic influence Teva’s operations?
A: The key question now is how to preserve some of the practices and learnings implemented during the pandemic. We need to make digitalization part of our lives while also maintaining human interaction within the organization. We also need to balance face-to-face and virtual meetings with customers. Finally, we need to take advantage of telemedicine to offer patients more access to healthcare.
Rodrigo Fernández Senior Vice President Latam and General Manager Mexico | Teva PharmaceuticalsQ: Organon is a spinoff of Merck (MSD). Why did this separation to focus on women’s health make sense?
A: There were two important factors that determined this decision. First, MSD has diverse therapeutic areas with clearly forecasted market needs. Among those, in the past four to five years, MSD decided to focus on categories such as nutrition science and vaccines. Everything else inside the portfolio of MSD primary care was not a priority because it was not patented. Second, women’s health products required a completely different focus from MSD because they present different growth opportunities. For those reasons, the portfolios separated.
Inside a global business worth US$6.5 billion, women’s health products represent US$1.7 billion. The decision was made because MSD had a significant portfolio of women’s products and saw an opportunity for growth as there was no other company of that size. We are the only company present in over 140 world markets that specifically dedicates itself to developing products that improve women’s health.
Q: What potential do you see in the Mexican market for products for women’s health and other specialties?
A: We see great potential in the Mexican market. We have a contraceptive product used by younger women that prevents pregnancy for three years. Mexico has the highest number of teenage pregnancies in the OECD. We need to facilitate access to contraceptive products so each woman can find the contraceptive method that is right for her. This product is effective in preventing pregnancy among teenagers.
The Mexican market is important for this product due to the private market’s interest in women’s health and the Mexican government’s decision to address teenage pregnancy. There are many opportunities for the health sector to maximize access to contraceptive products to prevent pregnancies. There are also opportunities to work across companies, organizations and the public and private health sectors to reduce the pregnancy rate of women between 13 and 18 years old. Teenage pregnancies increase risk factors and women who had a teenage pregnancy often lead a different economic life than they would have had if they had had children later in life.
Q: In terms of R&D, how are you incorporating Mexico into these efforts?
A: Our strategy is to develop products for women’s health wherever we find an unmet health need. As a result, R&D in the country focuses on market monitoring. In the next two years, the company might be able to develop clinical trials in the country to introduce international technologies.
Q: What is the role of biosimilars in your strategy for Mexico?
A: We offer biosimilar products globally due to an agreement with a biosimilar company. In Mexico, we do not yet have them in our portfolio but we are looking into it. We need certain regulatory flexibility, which Mexico currently lacks, to launch these products into the market.
 Fernando Fogarin
Managing Director Mexico | Organon
Fernando Fogarin
Managing Director Mexico | Organon

For the last couple of years, healthcare systems around the world have faced unprecedented stress. Both private and public stakeholders entered into “fight or flight” mode to address the challenge with innovation, agility and resilience. In many ways, we delivered while figuring out the uncertainty. Now, this transformed reality requires us to think and act simultaneously in solving what the short term requires and thinking about solutions for the long term around the pending assignments.
There are opportunities hidden in every crisis; this is no exception. The fact that health has been on the public agenda generates new possibilities to talk about accessibility and how we need to rethink the role that society, private and public organizations have in pursuing universal healthcare access. According to WHO, Universal Healthcare Coverage means that all people have access to the health services they need, when and where they need them, without financial hardship. It includes the full range of essential health services, from health promotion to prevention, treatment, rehabilitation and palliative care. The latest data from INEGI and CONEVAL reveals that 71.8 percent of the population has access to either public or private health services. While this means a considerable improvement from the results of 2010, we are talking about a universe of 33 million Mexicans that need to be included in the system one way or another.
Fostering accountability from a multidimensional perspective is extremely relevant. Stakeholders in the private sector have committed to replicating the “lightspeed mode” generated since 2020 to develop research and innovative therapies for a broader range of medical conditions. Governments need to think about current and future public policies that respond to this new environment, how to increase the availability of treatments by simplifying strategic processes and reinforce the social security institutions while understanding the different needs of rural and urban communities. All of the above is crucial; however, the impact of our roles requires a social component: the involvement of the patient, even before he becomes one.
The National Survey of Health and Nutrition (ENSANUT, 2020), shows that only 13 percent of the healthcare services required by the surveyed were preventive, versus 38 percent that corresponded to acute diseases and 25 percent for chronic diseases. We might consider that those results are in line with the decline of preventive health during the pandemic as a side effect throughout the world. However, when looking at the data of ENSANUT 2018-19, we see that 25.6 percent of the ambulatory consultations corresponded to respiratory diseases and 16.4 percent to chronic diseases, with no significant data for preventive consultations. This means that most of the efforts end up concentrated in the treatment and palliative care part of the definition of Universal Healthcare Coverage.
Every element of the system needs to consider how we can ensure accessibility from the earlier stages, as well as how we can avoid complications, mortality, and hospitalizations by consulting a doctor when identifying a possible symptom. It is time to prioritize health from a systemic perspective, asking from the individual to the organizational level: Which role should I play and how can we all meet halfway to pursue a common objective?

alent” is a common concept for companies and it is increasingly replacing the known terms “human resources” and “capital.”
Talent management and optimization for the generation of better outcomes pose major challenges. There is a great number of articles dealing with this topic and they, undoubtedly, arrive at the same conclusion: talented people are necessary for a company to properly operate and be successful. Having highly-talented people means companies must focus on what makes people special; that is, their knowledge and their capabilities; this focus does not regard people as replaceable resources.
When we talk about talent, it may be understood as an innate and potential element. This means we can turn talent into strength by developing skills and enhancing knowledge, both of which can be acquired; however, if they are not talent-based they risk falling into a bottomless hole. As for the concept of strength, it implies developing potential, which is consciously boosting talent.
According to Marcus Buckingham and Donald O. Clifton, most companies are built on two flawed assumptions about people:
+ E ach person can learn to be competent in almost anything.
+ E ach person’s greatest room for growth is in his or her areas of greatest weakness.
However, many people’s success stories tell us that the greatest potential for a person to grow is in his or her greatest strengths and only about 17 percent of us leverage our talents most of the time. There is no question this poses a challenge that demands business leaders to identify the capacities, skills and both personal and professional interests of employees. This knowledge will contribute to the fulfillment of the goals of the companies we work for. We must now be aware of the fact that companies need people with specific competencies targeted to meet the requirements of the companies they work for, allowing them not only to face the everyday challenges but also to inspire people moving in their working environment. Our priority must be changing the way we manage staff by supporting consistent development, boosting their strengths, and providing them with opportunities to enhance the talent they already have instead of their areas of improvement.
According to Peter Druker, the father of modern management, people are at the core of companies’ quality and productivity; therefore, they cannot be reduced to a number expressed as a cost. Talented people are the main component of successful businesses. This idea was highly revolutionary at the time. Today, more and more companies embrace this type of management.
Talent should also be managed by the right leaders, otherwise, we risk losing precious talent. A leader’s mission must be to align the strengths of a company in a way that weaknesses become irrelevant. Adopting a vision that enhances employees’ strengths will make leaders focus on the development of the innate skills of a person. This vision is much more effective to encourage people to learn and enjoy their careers to the fullest.

In addition to the COVID-19 pandemic and the social conflicts afflicting the world, farmers are also facing a major challenge from climate change globally: droughts, fires, floods, pests, desertification and dwindling water reserves, among others. In addition, food self-sufficiency is a pending need that only science and innovation can solve.
Data from the Food and Agriculture Organization of the United Nations (FAO) indicates that in 2050 there will be 10 billion people and the demand for food will grow by 70 percent. In the face of these challenges, small farmers emerge as key players in meeting the challenges of climate change and ensuring food security for a growing world population. FAO also indicates that in Latin America and the Caribbean alone, 80 percent of production belongs to family farming, which includes more than 60 million people, making it the main source of agricultural and rural employment.
It is important to learn from their diversified agricultural activities for the conservation of the environment and at the same time, help them to take advantage of the most modern practices, which will allow more equitable access to digitization and innovation. Information, education and training are essential to this sector through public policies, as well as private initiatives, strategies and programs.
Without the support of the latest technologies, innovative practices and capacity building, the livelihoods of smallholder farmers and those who depend on them will remain fragile. Instead, modernization will boost economic growth, not only for farmers and their families, but also for their communities and the world as a whole, as more productive fields produce more and better-quality food, generate more employment opportunities, and lay the foundation for rural communities to thrive.
To improve production, farmers need to have better access to:
+ Training: Most smallholders in developing countries practice their activity as they have learned it from parents and grandparents. However, agriculture has advanced and the latest methods of crop protection and management, irrigation and soil fertilization have enabled them to develop more productive fields. In turn, these farmers can share this strategic information with others in their local community.
+ Resources: They also need access to essential resources in the fields. These include better seeds, more effective crop protection solutions and fertilizers, modern farm machinery, irrigation systems and improved crop storage.
+ Physical and digital markets: This includes access to transparent prices and certifications, as well as avenues for collaboration with food chain partners.
To achieve a world without hunger and to contribute to feeding the population, it is necessary to provide access to innovative, customized solutions and best practices to expand the productivity of the fields, using modern techniques.
We all face the food challenge, not only farmers, and it is therefore necessary to provide them with tools and solutions to help them face the great paradox of how to produce more with fewer natural resources. Improving their conditions is imperative and, in this scenario, we must encourage the participation of the public and private sectors to work together, join forces and provide more equitable support to ensure access to information, education and technology to address the challenges of climate change that are occurring in the world.
Patient centricity has become a buzz phrase among healthcare and life sciences companies. However, its true implementation remains underwhelming as practices remain fairly traditional. Further adoption of novel standards and an overall change in mindset are necessary for patient centricity to take hold, agree experts.
Patient-centered care is built around listening to, informing and involving patients in their own care. The Institute of Medicine (IOM) defines patient-centered care as “providing care that is respectful of, and responsive to, individual patient preferences, needs and values.” Many life sciences companies can claim they are patient-centric given that they are making and marketing products for patients. However, “the patient’s perspective has traditionally been viewed through the lens of the physician, the regulator or the health plan,” according to Deloitte. To move past this, medical devices organizations should consider adopting novel practices when selling to medical providers and their patients.
The first of these novel practices is identifying the benefits, risks and other patient-centered considerations for treatments of a given disease. To do so, companies can conduct studies to see patient responses directly from the patient or they can partner with patient advocacy groups. Companies would then be able to redefine their strategies around a valuebased patient experience. “Putting the patient at the center of our work guarantees quality, efficiency, innovation and cost-effectiveness in the development and manufacturing of medical devices,” explains Ana Riquelme, Executive Director, Mexican Association of Innovative Medical Devices Industries (AMID).
Medical devices are sometimes not accessible to all segments of the population. Value-based healthcare models are another novel practice to break this barrier and provide patients with access to innovative solutions, according to Riquelme. Valuebased medical devices allow patients to spend less money to achieve better health. Patients with chronic diseases like cancer, diabetes, high blood pressure, chronic obstructive pulmonary disease and obesity report a quicker recovery or a better management of the disease when using these devices. As a result, patients require fewer doctor’s visits, medical tests and procedures, spending less on prescription medication as both near-term and long-term health improve.
The third practice involves the prioritization of patient experience once goals for a certain treatment are defined. This, Deloitte explains, tests the product’s design, transparency and engagement, among other factors. “Maintaining a patient-centric model demands that the industry rethink success measures based on new metrics,” says Alexander Group. These would depend on the disease being addressed but an example can be estimating total days for therapy, total lives saved, hospitalization days or life-saving treatments administered.

Jaime Castro Palma
Director General | QbD
Managing Director | Siemens Healthineers
Country Director | Boston Scientific de Mexico
Market Access Leader | Masimo
Although the shift toward patient-centric business models aims to increase access to health services, regulations and lack of information is hampering this approach, say industry experts.
Manufacturers of medical devices have acknowledged their responsibility to boost the patient-centric approach across the sector and have committed to educating the multiple actors that help shape the health industry. “We have a responsibility to educate the whole sector on this matter, not only doctors,” says Agustín Zabulanes, Country Director, Boston Scientific de Mexico (BSCI).

Authorities, health professionals and, most importantly, patients have a right and obligation to access information that will allow them to make better decisions regarding healthcare. Authorities need to understand how this approach improves healthcare through the provision of services based on value, which can reduce costs and improve efficiency. Meanwhile, health professionals should be educated in the new technological trends, such as AI and machine learning, say experts like Jaime Castro Palma, General Director, QbD, who adds that technology is no longer an option.
“Health professionals have to understand the differentiation among concepts. Although they have to be involved in conceptualization, they do not have to become experts,” says Montserrat Galindo, Market Access Leader, Masimo.
Digitalization and technology facilitate the job of health professionals and reduce human error but technology is not expected to replace doctors. “Machines are not going to replace doctors. The only health professionals that are going to disappear are those who do not acquire technology and waste the invaluable support that technology offers them by helping them gain time and have more precision,” says Alejandro Paolini, Managing Director, Siemens Healthineers.
Although the patient-centric approach is increasing in popularity, there are many challenges ahead. In the public health sector, regulations are slowing down the introduction of new technologies, limiting access. In this sector, innovations arrive four years after they are introduced to the market due to the obstacles that regulations impose. Meanwhile, in the private sector, the promotion of health insurance needs to be prioritized to increase access to health services and innovation, experts say. Mexico has the lowest rate of medical insurance penetration in Latin America.
Q: How does the development of an EMR align with Philips healthcare innovation ideals?
A: In recent years, Philips grew from a diversified conglomerate to a leader of health technology. In this transformative journey, Philips chose to focus on health as it is a great social challenge where innovation can bring change and have a substantial impact, especially in regions like Latin America where 30 percent of people do not have access to quality medical care.
We believe that innovation and medical care play an important role in helping healthcare reach different places in the region, especially remote populations. At Philips, we want to be a key player in this transformation. As a leading technology company, our purpose is to improve people’s health and well-being through these innovations.
Q: How does the Tasy EMR contribute to your already leading market position in the healthcare industry?

A: It is part of our ultimate goal to improve 2.5 billion lives per year by 2030, including 400 million underserved communities. At Philips, we are committed to helping healthcare professionals and improving patient care. Recently the Tasy EMR solution won the Best in KLAS 2022 award for intensive care in Latinamerica. This award recognizes software and services companies that excel at helping healthcare professionals improve patient care. All of these rankings are the direct result of feedback from thousands of health professionals over the last year. For the healthcare IT industry, a Best in Klass award reflects the commitment that main providers must offer and that the solution contributes to the improvement of medical care.
Q: What are the fundamental elements that make Philips’ EMR a responsive solution for providers, management and patients?
A: Philips has professionals and consultants who have an in-depth understanding of hospital processes worldwide. This knowledge was transformed into a computer tool. One of the main characteristics of our tool is that it is extremely configurable and can be adapted to different scenarios or types of organizations, whether they are private or public, highlymature hospital processes or just starting a project. This set of elements has made it possible for our tool to adapt to the situations that exist today in each hospital worldwide. This system can be adapted to a Mayo Clinic-type hospital or to a small clinic in a remote rural community.
Q: What security standards are used by Philips’ EMR?
A: We started this from a legal viewpoint, ensuring patients have ownership of their information regardless of where it is generated. Regarding security, Phillips has international certificates that help our platforms to assess the current state of data security in computer systems. In addition, we are constantly developing effective security standards and constantly monitoring them to ensure that the information generated in the system is never compromised. Our security consultants provide risk and vulnerability assessments of medical systems and provide advice on implementing organizational processes that seamlessly integrate security response and recovery workflows across all suppliers.
Ricardo MárquezQ: How have innovations impacted the industry and the next generation of Mexican doctors?

A: During the past couple of years, we have been able to accelerate training and education fourfold thanks to our digital innovation capabilities, which also helped us connect with customers. We are now seeing the results of the investments made in the last few years, such as in remote solutions for training and assisting different medical procedures that are difficult to fully perform in person. Using medtech, we understand the patient’s journey better and we are working on solutions to connect with them in earlier stages, especially those patients with comorbidities.
Healthcare has fallen behind in the adoption of technologies and data analytics. Companies are beginning to prioritize customers, understanding the patient’s journey and the digital transformation. These will be the main concerns for the next five to 10 years in the industry. Most companies are also focusing on digital innovation and creating better customer experiences. AI also brings value, improves processes and makes them more accessible. Well-trained AIs will be real game changers in diagnostics and treatment.
Q: How are solutions like Clinical Eye impacting the medical field and Mexico’s healthcare development?
A: These technologies have allowed hospitals and doctors to avoid postponing procedures requiring external support and proctoring during this pandemic when travel and safety reasons affected the traditional in person support. In areas with good internet access, remote solutions like Clinical Eye can assist in medical procedures and expand educational capabilities including real immersion in virtual mode to create a more powerful learning experience. Late last year, we had a hybrid event in which 30 physicians received real-time training using virtual reality through Clinical Eye and the learning experience was incredible. A poor internet connection has limited our ability to livestream virtual reality in some cases but no doubt that 5G availability will change everything in the near future.
Q: How can Mexico best contribute to the development of innovative technologies for healthcare?
A: One of the key issues we have been experiencing when innovating in medtech is the regulatory approval process issued by COFEPRIS, which is very complex. Despite Mexico being one of the Top 10 producers and exporters worldwide of medical technologies, there are many issues throughout this approval process; there is no visibility, which creates uncertainty that may affect investments decisions. Many companies are assembling medical devices here but there is still a big room of improvement in regulations to unlock R&D and clinical investments.
Q: In Mexico, how does Boston Scientific increase healthcare accessibility for patients across urban and rural areas?
A: The first barrier to access is education: creating training capabilities to enable correct indication and safe and effective use of our medical solutions. Another big barrier is the lack of reimbursement that in many cases limits the possibility of treatment. To overcome these barriers, we launched a platform (Leap+) where the patient has access to different financial options to cover the cost of the products, but also hospital expenses and physicians’ fees; creating value for all the stakeholders.

Q: What has driven Masimo’s leading position in monitoring technologies around the world?
A: Masimo works for value-based healthcare and is committed to patients and technological innovation. Our mission focuses on improving non-invasive monitoring technologies while also offering cost-effective solutions to institutions and patients. The company was created with the mission to put the patient at the center to improve healthcare, which has been a constant over the years. Our mission represents it all: Improving Patient Outcomes and Reducing Cost of Care.
Q: What has the company learned from working in this market and how have you implemented your business model in the country?
A: Masimo arrived in Mexico five years ago. The market is new but we already have important representatives and commercial partners who have fallen in love with the brand. They have helped us position the brand in Mexico. We are learning and adapting to the changes in the Mexican laws regarding acquisitions in the private sector.
Q: What strategies has Masimo implemented so the patient can access this technology?
A: We are working closely with hospitals. Instead of offering a single product, we provide them with comprehensive solutions in accordance with their needs and support them throughout the installation process. We are present in 70 percent of the most important hospitals in the US and we know that we can have the same level of success in Mexico.
Q: How has Masimo positioned its solutions in the Mexican market?
A: We have joined local associations and chambers. Mexican regulations still require the differentiation of medical devices from pharmaceuticals because they are very different. To be able to offer integral services and solutions, the government must facilitate the acquisition of and promote access to new medical devices.
It takes an average of four years from the launch of a medical device until the patient can access it. By the time a customer can use it, most of its components have changed.
Q: How does the Digital Health Law help medical tech regularization and what can be done in the industry?
A: Many medical devices receive constant software updates but there is not much clarity on how these updates will be regulated. The Federal Customs is not aligned with COFEPRIS, sometimes we are asked to comply with regulations for the sale of computer or stationery equipment. But these processes are not linked to sanitary registration because authorities have not determined how to properly register this type of equipment.
The industry must work together because the well-being of the patient is our common objective. Only through collaboration will we have an impact.
Montserrat Galindo Head of Market Access | MasimoPresident and CEO and SVP Digital Industries Siemens Mexico, Central America and the Caribbean | Siemens AG

We are at a critical point in the face of the challenges that climate change imposes on us. The new normality in big cities is bringing back the pollution levels that existed before the pandemic and time is running out to reverse global warming. Industry, specifically manufacturing, is one of the protagonists of this scenario, due to the nature of its processes and the composition of its production chains.
This sector, according to the United Nations Environment Program (UNEP), is responsible for generating more than 20 percent of CO2 emissions globally and demands more than a quarter of primary resource extraction. In the social environment, more than 17 percent of diseases are attributed to air pollution. That is why a transformation is necessary, so that production remains sustainable.
As the consulting firm Deloitte observes, the manufacturing sector is not related to the best environmental practices; however, in the face of an environmental emergency, manufacturers around the world are already generating economic benefits from sustainable production. Deloitte’s report, “Sustainable Manufacturing, From Vision to Action,” highlights five impact areas where sustainable practices can drive improvements in the manufacturing value chain: engineering, sourcing, production, transportation and aftermarket.
In Mexico, according to data from the Ministry of Energy, the main source of emissions at the national level is power generation and the industrial sector is among its largest consumers, which demonstrates the urgency of a transformation. Only 31 percent of companies from all sectors have a budget allocated for sustainability and only 25 percent issue a report on this matter, according to KPMG’s “Sustainable Development in Mexico 2020” study. Fortunately, Mexico is already taking action, as it was the first country in Latin America and the second country internationally to introduce a climate change law. The nation has established specific commitments and goals to reduce greenhouse gas emissions and other pollutants, with more than a dozen related initiatives. But this is only the beginning.
At Siemens, we work to promote the transformation of industries toward sustainable growth. From our perspective, the solution is to digitalize manufacturing to make it more efficient, productive, and cleaner. At the same time, we must make it flexible so that it responds to the personalized needs of the market. We define five fields of innovation on the way to a more sustainable green factory and the questions that will define our actions:
1. D esign. What aspects of this phase could have the greatest impact on the recyclability of my product?
2. S ourcing. How can we improve the resilience of our supply chain while enabling sustainability?
3. P roduction. How can we accurately forecast auxiliary material usage?
4. E nergy efficiency. How can we avoid energy consumption peaks at factories?
5. C ircular economy. How can we quickly evaluate the remaining life of products and machines?
Q: What makes MedGlobal the most technologically advanced online marketplace for the medical industry?

TG: We started in 2009 as a medical equipment distributor in Mexico and observed that Latin America had many unleveraged capabilities in healthcare caused by the lack of technology and infrastructure. These gaps were present at all levels: from the physician’s office to major hospitals. We wanted to solve a problem and support growth in the Latin American marketplace, so we created the first nonmonetized platform to connect manufacturers and distributors interested in the Latin American market with buyers and other leads. The healthcare industry in Latin America is one of the largest in the world, having four of the top 10 emerging markets.
As we expanded, we used the feedback from focus groups and client interviews to create what is now MedGlobal Group: an international platform that offers multiple languages, currencies and shipping options. MedGlobal Group’s platform was launched in May 2022 and has reached over 100 countries.
We also launched Insights, our fully interactive digital magazine, to generate awareness and share information about the healthcare industry. Besides the operators of our platform, we are a technology company and we design and build our platforms and use technology to create new ways to promote the healthcare industry.
Q: With the industry experiencing a boom in medical device development and commercialization, how does MedGlobal select the products it offers?

PS: We participate in expos to observe the latest trends and get acquainted with vendors we research to determine if they are reliable distributors and manufacturers. In Mexico, for example, we meet many clients at Expomed and MedicalExpo. We also do due diligence on those who advertise on our website and have different tools to weed out those who are selling illegal or unreliable equipment. We have a Verified Vendor-free tool. Distributors must submit tax and legal documentation, plus letters of recommendation from clients; all documentation gets reviewed, and each firm must commit to our standard of operation. Our MGG Score tool uses an algorithm to measure the performance of our users and provides a score to demonstrate their positive use of the platform. The buyer can use this score to choose a vendor.
The health industry is well connected, so everyone knows each other. Thus, we want to provide the best service to maintain our good reputation in the industry.
TG: We are creating opportunities and synergies for healthcare systems that have been challenged financially, such as Mexico. We are planning to develop a tool on MedGlobalGroup for group purchasing if multiple hospitals want to ally to buy equipment from a single distributor allowing for economies of scale. Some economies have a large market surplus that could end up unused; however, in good condition, so we are trying to ensure that medical equipment and products get used throughout their entire life cycle and provide access to parts. We also ensure that our companies follow socially responsible standards and practices.
Q: How does Art-Técnica improve quality control in medical equipment and diagnostic imaging?
A: Our robust offer is made up of high-quality medical metrology equipment. We also service biomedical and medical equipment. The sector of care provision is tied to high-quality standards. Improving the quality-of-care provision facilities relies primarily on biomedical engineers, so Art-Técnica employs a large number of them and invests in their continuous training and education. As a result, we have been looking to partner with universities or educational institutes to train professionals in this area on the use of medical equipment technology. Art-Técnica also offers equipment to universities to promote the training of students so they are familiar with the processes and devices they will encounter. We have worked alongside Universidad del Valle de Mexico (UVM), Tec Milenio, Instituto Politécnico de Mérida, Instituto Politécnico de San Luis Potosí and Instituto Politécnico de Guanajuato. The Mexican southeast is a hub for tourism and medical tourism so we are focusing on that region.
Q: Aside from your core business, what are your most recent technological innovations?
A: Technology is developing at a fast pace but there are basic metrology standards that remain constant, such as gas flow, liquid flow and electrical measurements. However, the mechanisms and tools to measure them have evolved. Art-Técnica links these new developments to the training of biomedical engineers. The introduction of new technologies impacts the performance of existing tech, opening a market opportunity for us to improve overall biomedical processes. This area is growing alongside the responsibilities of biomedical engineers for equipment maintenance. To improve processes for these engineers and increase our service portfolio, we partnered with software developer TINC CMMS, which has benefited our business and professionals.
Q: How has the COVID-19 pandemic changed Mexico’s limited awareness of the importance of continuously maintaining medical devices?
A: The pandemic led hospitals to pay more attention to their biomedical areas, which are vital for the optimal performance of their services. If these areas run smoothly, the hospitals will become more cost-efficient and grow. There is a market opportunity in maturing these processes and promoting biomedical engineers to directorships. Art-Técnica can help care facilities improve the performance of their metrology equipment and achieve the full and correct utilization of their medical equipment. Hospital directors can approach us for a personalized approach and we will build them the right solution for their specific goals.
Q: How has Art-Técnica mapped the manufacturing market to expand its coverage?
A: We approached many manufacturers during the pandemic because there was a development boom for biomedical devices. Our quality and experience can also support manufacturing of medical devices. All of our quality processes are based on international regulations and standards and adhere to Mexican regulations when applicable.
 Luis Garduño
Partner
Luis Garduño
Partner
Public-Private

From delays caused by the pandemic to the war in Ukraine, the disruption of global supply chains has severely affected all industries, introducing an opportunity to reshore or nearshore company activities.

The healthcare industry has overcome global difficulties and demonstrated its capacity to operate not only locally but regionally. But to be successful, attention and support from other actors is a must. Strengthening supply chains requires a great deal of investment to seize opportunities that can help the Mexican healthcare sector achieve long-term success.
The chapter looks at the logistics and distribution efforts of leading companies in healthcare supply chains. These players are early tech adopters, demonstrating that digitalization has few barriers to enhancing and spurring the potential of all health-related processes.

Rethinking
Reinventing
Rafael Figueroa |
Ron Volpe | Senior Vice President
Ranjeet Banerjee | CEO
Rubén Hernández
Juan
Geert Verstraeten
Kremer |
Altamirano
D’Incerti
Markets | PSQR
T5DC
COVID-19 exposed vulnerabilities in production strategies and supply chains across the world. Temporary trade restrictions and shortages of pharmaceuticals, critical medical supplies and other products have highlighted these weaknesses. Nearshoring and automation of manufacturing operations can, however, bring efficiency back to supply chains, say experts.
“It will take some time for the world to truly overcome the pandemic. Supply chains have been affected. The pandemic will completely change the future of business, specifically amid the nearshoring and reshoring of the supply chain,” says Gabriel Parrodi, Country Manager, Rainmaker Global Market Access.
Not all countries are attractive candidates for nearshoring activities. However, Mexico has several elements that make it a reliable partner for these operations. First, the country has a specialized, skilled and cost-effective workforce. The country’s proximity to the US has also been boosted by close trade relations and the creation of USMCA, which, according to Oscar Silva, Partner Leader, KPMG’s Strategy Group, will make Mexico a “trustworthy partner in the coming years,” especially after the China and US trade fallout.
The medical devices industry is among the main seekers of supplier alternatives and according to an article by Prodensa, Mexico is one the most attractive destinations for these types of companies. Pharma is another sector with the potential to take advantage of Mexico’s position regarding nearshoring, says Leticia Zermeño, Director, Grupo CPQ. “The country should be prepared and not rely completely on foreign suppliers.” According to Zermeño, the government should create a program to encourage and support a strong national pharma industry to face health challenges, “fostering local production of active pharmaceutical ingredients, aside from the already well-developed medicines market.”
Being able to forecast future disruptions is a significant value for companies in the healthcare industry and this has opened up a new way of thinking about how technology can leave the industry better equipped in the future. While automation is already a part of most supply chain models, these systems still require human intervention despite having complex algorithms predicting demand and aiding in forecasting. With AI and other tools like machine learning becoming more accessible, the opportunities to have a completely automated system arise. AI is one of the tools able to spur more benefits. For instance, it can facilitate better planning for the types of services and products needed to support patient care, while ensuring products are available where required. This helps to prevent potential backorders or shortages while also avoiding overstocking products that are at risk of expiring before use.
Overall, Mexico’s opportunities to revamp its manufacturing capabilities are enough to improve the country’s position in different fields, such as the pharmaceutical industry. This could also foster supply chain improvements in other segments of care, such as hospitals. Still, collaboration will be needed to foster this transformation.


CEO and Co-Founder | Breakthrough IP Intelligence
Rodrigo Fernández
Director General and Latam Head
| Teva Pharmaceuticals
Miguel Lombera
President | CANIFARMA
Juan De Villafranca
President | AMELAF
While the most acute phase of the pandemic has seemingly passed, new challenges have arisen, rendering Mexico’s supply chain model obsolete. In light of this reality, industry leaders are looking toward the public sector to build a balanced, certified and sustainable purchase and distribution model. “Domestic companies are already discussing it and we congruently agree that it should begin with a state of the sector diagnosis, with special attention to logistical discrepancies and essential medicines,” says Rodrigo Fernández, Director General and Latin America Head, Teva Pharmaceuticals.
Initially, inconsistent drug deliveries were followed by changes to the Acquisition Law for Medicines and Medical Supplies. By intentionally cutting out distribution companies, public institutions and state entities were left to compute their own orders. The federal government anticipated that the new acquisition system would generate savings and help combat corruption but a year after going into effect, it had failed demonstrably: by October 2021, INSABI had only delivered 9.5 percent of all drugs requested by states. However, as evidenced by the rollout of this regulatory amendment, “this is not a problem that can be solved unilaterally, from either the private, public or civil sector; it requires interaction on behalf of all three to generate ideas free of as many blind spots as possible,” says Miguel Lombera, President, CANIFARMA.
Before even attempting to formulate a new supply chain model, industry experts agree that they need more data to identify pitfalls, risks and opportunities. Immediate concerns include how to augment domestic production, how to balance global and local supply chains and the need to differentiate medications through standards or certifications. “Other considerations involve the expected wave of nearshoring and the start of a new political cycle,” says Juan De Villafranca, President, Mexican Association of Pharmaceutical Laboratories (AMELAF). In light of this, he recommends that the challenge be approached in multiple stages so that the constructed system, regulatory standards and stakeholders can adapt to the evolving reality produced by changing domestic and global conditions.
“Regulators also play a key role in ensuring access to medications. In the case of generics, the authorities need to work faster so generic drugs can reach the population on time,” says Américo García, Vice President and General Manager for Latin America, Apotex. By accelerating this process, regulators will further promote a framework that will propel quick access to new medications and supplies, he says.
Q: What differentiates NTA’s services from others in the market?
A: NTA is a third-party logistics (3PL) supplier for the Mexican and Latin American market, offering warehousing and distribution services for almost 90 laboratories. Our services and attention have allowed us to work with multinational companies in Mexico, including nine of the Top 10 pharmaceuticals in the country.
O ur quality services have been our largest differentiator. The company strictly complies with national industry regulations for product storage and distribution and with the specific requirements of every single one of our customers. Our last-mile delivery service is another differentiator and its high efficiency has turned it into our flagship product and one of the most competitive in Latin America. Additionally, we are close with our clients and provide them customized solutions based on our expertise, specialization and compliance.
NTA is developing a Standard of Procedure (SOP) with logistic entities from Asia, the US and Latin America to offer an international pharmaceutical logistics’ process that complies with general distribution requirements of the Mexican and Latin American markets.
Q: What strategies have you implemented to become a true ally and partner to your clients’ development strategy?
A: We are a flexible and agile company, characteristics that allow us to innovate and adapt to rapidly changing market conditions. During the COVID-19 pandemic, for example, lockdowns disrupted the delivery of medical samples from patients to doctors. Within a month, NTA had developed a specialized service to address this problem and made about 3,000 last-mile deliveries per month.
Q: What role does traceability play in this process and what opportunities exist in improving the service and information you provide?
A: We are one of the few companies using passive systems for temperature control, a service made possible thanks to a partnership with a US company. All of our fleet is equipped with temperature control, so everything moved in our units follows temperature control standards. We have also installed a passive system box in every unit to monitor temperature in real-time. This data is then sent to our systems and shared with customers.
Q: What are the unique logistics challenges in Mexico?
A: Mexico is a challenging market due to its diverse weather, geography, road infrastructure and social networks. Accessing all parts of the country is not always possible due to road closures and poor infrastructure. Understanding this market, NTA has built flexible transport solutions, such as air fleets to circumvent inaccessible roads.
While we usually use our own fleets, we have partnerships with other suppliers for exceptional cases. NTA also has 26 distribution centers around the country and six in Mexico City’s metropolitan area.
 Rafael Figueroa
Director | NTA
Rafael Figueroa
Director | NTA

Q: What are the main differences among the services that you offer?
A : SAGA is our flagship product, enabling our customers to track any product at any level of granularity based on the digital capture of key event data across the value chain. At its core, SAGA is a Supply Chain Event repository that is able to handle mass amounts of data, at very high speeds in very complex settings and presently handles over 25 billion items annually. SAGA solutions are completely customizable based on a unique build, following the requirements of each particular customer and their relevant supply chain.
Our product EPCIS (Electronic Product Code Information Services) is key enabling trading partners to share information about the physical movement and status of products as they travel throughout the supply chain, from business to business and ultimately to consumers. It helps answer the “what, where, when and why” questions to meet operational, consumer and regulatory demands for accurate and detailed product information. A key advantage of EPCIS is that it allows diverse applications to create and share visibility event data, both within and across enterprises, something blockchain-based solutions often struggle to do.
Inveni is a tailored solution for the EU tobacco industry based on the parameters set by its governmental bodies. Our experience in tobacco, in the EU and globally, is extensive and transferable to any tobacco business globally.
For seafood, we are building a solution based on Global Dialogue on Seafood Traceability (GDST) standards, which include a critical tracking event (CTE) and a key data element (KDE). GDST follows six large CTEs within that supply chain and between 10 to 20 KDEs for each CTE.
Q: How can traceability add value to the health sector?
A: Globally, the proliferation of falsified medications is very significant and can only be solved through serialized, end-toend traceability. While Africa has the direst situation with an estimated 70 percent of medications considered to be fake, the Americas is second in prevalence of falsified medications. Lack of regulation restricts traceability and affects society. An analysis by the London School of Hygiene and Tropical Medicine for the WHO estimates that over 122,000 children under the age of five died each year because of sub-standard anti-malarial drugs in sub-Saharan Africa.
Pharmaceutical companies, in the absence of comprehensive legislation, perform the traceability that they feel is necessary but they do not do it consistently. To revert this, the US is expected to pass the Drug Supply Chain Security Act (DSCSA) legislation in the next couple of years, which will change the game. The EU has passed similar legislation.
Illicit medical devices and even medical supplies abound as well. The right answer in healthcare in the long run is an integrated approach that includes medicines, medical devices and medical supplies, and one that goes from manufacturer to the patient. PSQR is working on this vision in both the EU and the US presently.
Ron Volpe SeniorQ: How does technology help CCT offer better products and services?
A: Technology is core to our product offering. CCT’s digital platform is already operational and in the next few months we will launch new features and functionalities. Currently, the platform enables us to track the location of the drug, vaccine or biologic, issue an alert if it has been delayed and inform customers when the delivery is near its destination so they can prepare.
We are able to see the product’s location and its condition inside the package. This is a key aspect of patient safety; we know the condition of the product before it reaches the patient. We will soon launch AI capabilities for even better forecasting. This technology will allow us to precisely predict outcomes and act accordingly, providing more assurance.
I am also happy to share that Cold Chain Technologies has completed the acquisition of Packaging Technology Group (PTG), expanding our commitment and leadership in the Sustainable Thermal Packaging space. Packaging Technology Group (PTG) designs, engineers, and manufactures sustainable, thermal shipping, and packaging solutions for the biopharmaceutical and life sciences sector. Established in 2005, PTG is Headquartered in Fall River, Massachusetts. PTG is a pioneer in developing sustainable thermal packaging solutions that meet the strict requirements of its global blue-chip pharmaceutical clients.

Q : How does CCT continue to innovate within its processes?
A: CCT has really good phase change material (PCM) technology that performs well and is easy to use. Innovation is happening in multiple ways at CCT. We use good technology in our raw materials and have the ability to design our products and test them in-house. In addition, we use a high-quality, automated process that ensures consistency in the quality of the products.
Q: How is CCT helping its partners and clients amid the supply chain crisis across the world?
A: Our motto is to be true partners for our customers. This relationship is built on a close partnership, whether they are distributors, pharmaceuticals, clinical trial customers or any other company. CCT makes sure to understand our clients’ needs and plan proactively according to those requirements.
CCT keeps a strategic inventory of key raw materials. We work with good planning, both with customers and internally. The supply chain crisis is ongoing and it is not static, so our ability to respond to different situations thanks to our size and global presence is greatly helpful.
Q: How do your products adapt to the diverse needs of different life science players?
A: Although we offer off-the-shelf products, typically we work with customers to understand what they are looking for regarding temperature, specific transport conditions or size. Then we optimize the solution. Our goal is to be a partner to our customers, providing them with our technology, design and thermal engineering knowledge to create the best product for their needs.
Ranjeet Banerjee CEO | Cold Chain Technologies
Proper cleaning during remanufacturing and overhaul is also critical. Cleaning mechanical parts will reveal defects, which may lead to a decision to scrap some of them. Cleaning also contributes to worker safety, as much of the contamination will be removed from components before they are dismantled and overhauled. There are four factors that affect the cleaning process: chemistry, temperature, mechanical action and time. These factors are generally synergistic. For example, in most cases, adding a little heat makes the cleaning solution more effective.
Most chemical agents used in aqueous cleaning fit into one of three categories according to pH. Neutral cleaners, the kindest of cleaners, are preferred for light soils. Depending on local codes and the composition of the soils that become part of the mix during use, spent cleaning solutions can sometimes be disposed of without further treatment. Alkaline cleaners are the most used for removing oils, grease and general soils. Acidic cleaners are primarily used to remove tarnish and oxides and to brighten nonferrous metals.
Generally, the hotter the cleaning solution is, the faster cleaning occurs. This is because the higher temperature softens, or preconditions, the contamination and allows the chemistry to work more efficiently. There are other considerations concerning temperature. In a buffing compound removal application with brass parts, using 82°C could cause the parts to tarnish as soon as they are removed from the cleaning solution. For this application, there is more than one right answer. You can back off on the temperature and accept a longer cleaning cycle. Alternatively, you can add another wash step (and rinse) using an acidic chemical step to remove the tarnish.
Mechanical action is sometimes described in more technical articles as “impingement,” which refers to the application of mechanical force. A simple method of applying mechanical action is agitation. The most common type of part agitation machine uses vertical agitation. The repeated up and down motion is effective in cleaning simple parts, such as parts without blind holes and/ or deep grooves. Another type of part agitation machine uses a rotating basket, typically for small parts that tumble through the cleaning solution as the basket rotates. There is also part-onpart contact with a rotating basket that adds some mechanical scrubbing into the process.
For industrial parts cleaning, there is practical equipment that uses liquid agitation. Methods for moving the liquid include impellers, eductors and air agitators. Liquid agitation can also be an effective way of cleaning simple parts without blind holes and deep grooves. It is not unusual to add liquid agitation to other types of equipment to increase effectiveness.
Ultrasonic cleaning depends on a phenomenon called “cavitation.” With this, a sound wave is created in water in a manner similar to the way an audio speaker creates sound in air by vibrating a diaphragm. As the sound wave passes through the water, alternating areas of high and low pressure are created. As the frequency of the sound becomes higher, the sound waves are closer together. When the frequency approaches the limit of
human hearing and beyond, the alternating high- and low-pressure areas occur fast enough that cavitation can occur on a microscopic scale if the intensity (amplitude) of the sound wave is high enough. The mechanical energy in ultrasonic cleaning occurs when the cavitation bubble implodes (collapses rapidly). Water rushes in at high velocity, although not exactly evenly, to fill the space formerly occupied by the vapor bubble. The result is “micro-jetting” that provides the mechanical energy for cleaning. Cavitation occurs everywhere throughout the liquid, including deep grooves and blind holes, or any area that the liquid can reach, and is effective on parts that are not cleanable by other methods.
The fourth factor, time, is an important consideration in cleaning applications. For a given set of process conditions, longer exposure generally results in cleaner parts.
No discussion of aqueous cleaning is complete without mention of the importance of adequate rinsing. Rinsing can be especially important with parts made from more than one metal as chemical residue between the different metals can act like a battery and promote long-term corrosion.
Nowadays, the residue-free cleaning of surfaces plays a vital role in virtually every industrial manufacturing process. Perfect cleaning enhances the quality of your products. The introduction of quality management systems and increasingly stringent environmental legislation has led to more and more attention being focused on aqueous cleaning techniques. This technology is now firmly established in many fields.
In the precision metal industry, the requirements that have to be met for the aqueous cleaning of parts are enormous. Besides factors such as material compatibility and the contaminants themselves, the success of aqueous cleaning processes depends above all on taking the customer’s existing cleaning system fully into account in the cleaning proposal.
Decoating is the process of removing the old coating on the workpiece before the coating. The workpiece can be repaired after the initial coating is used and the coating can be used again. It can also be repaired and repeated several times. However, the continuous accumulation of multiple coatings will have a negative impact on the service life of the workpiece and the accuracy of the workpiece, so there is a need for repainting.
The decoating process is mainly divided into chemical decoating and electrolytic decoating. Both processes utilize the chemical reaction between the decoating solution and the coating to oxidize and decompose the coating. Decoating may also damage the substrate while oxidizing and dissolving the coating as some steel contains the same alloy components as the coating. In addition, cobalt is used as a bonding agent in cemented carbide and cobalt is easily lost in a chemical solution. After cobalt loss, the cemented carbide composition around it loses its binding force, making it easy to fall off, destroying the surface of the workpiece. Therefore, be fully prepared before decoating and understand the characteristics of the workpiece substrate material. In addition, after the workpiece is decoated, apply some necessary posttreatment, such as sandblasting or polishing, to reprocess and repair the workpiece surface.


Nobody thought that the COVID-19 health crisis would define retail business models. However, since it is an endemic disease, both companies and consumers will have to learn to live with it. Safety, well-being, convenience, authenticity, novelty, and creativity are attributes that customers will demand proactively in their shopping experience, either at a physical point of sale or in cyberspace.
Innovative retailers have placed technology as a cornerstone in the design of new and satisfactory shopping experiences, as well as to increase consumer brand loyalty, despite emerging contingencies. Exponential technologies, such as artificial intelligence (AI), Internet of Things (IoT), robotics, analytics, big data and immersive experiences are becoming the foundations of stores. In addition, e-commerce, social media and mobile applications continue to digitize the way consumers shop and interact.
According to the consulting firm Deloitte, one of the most notable changes that consumers have undergone is the shift from almost compulsive or emotional consumerism to one that is much more rational and informed. Beyond customization or price-based exclusivity, consumers have started to value craftsmanship (handmade) and “tailor-made” items more than those that are mass-produced, as well as other attributes, such as diversity, fair trade, and eco-friendly brands.
It should be noted that retail trends are investing in strengthening e-commerce, omnichannel sales and intensive internet use to avoid the influx of people in physical stores. They are also seeking to provide customers with several options to pick up their purchases, such as in-store pickup, drive-through, click and collect and the innovative smart store kiosk, a kind of artificially intelligent machine with a variety of products where customers create an account linked to their bank details, receive a password and pay for the item they choose through an app, without human intervention.
GS1 Mexico, together with Psyma Latina, conducted the fourth Edition of the GS1 Barometer: SME Manufacturers in the Consumer Industry, which states that small and medium manufacturing enterprises attributed their success in 2021 to their commitment to customer service, as well as to the high quality of their products, which generated specialized merchandise strategies in categories where competition is not so fierce, allowing them to stand out. Companies with a greater number of employees have chosen an approach focused on permanence, where the brand retains its essence and purpose while adopting new success factors into the equation, such as online sales and digital campaigns.
Concerning sales dynamics, 35 percent of the manufacturers surveyed mentioned that in 2021 they grew a lot or slightly, 18 percent added that they maintained the same levels as 2020, while 31 percent reported that sales declined this year. In terms of customer growth, 43 percent of the companies declared the number of their customers increased, 31 percent reported the number remained stable, and 26 percent reported a decrease. The sales-customer relationship is essential for the development and sustainable growth of retail supply companies. Therefore, elements such as product quality and customization, the omnichannel environment, focus on customers and premium services, in addition to providing relevant shopping experiences, will make the difference when it comes to winning over consumers and expanding their market.
Q: What are Sievers Analytical Instruments’ latest solutions implemented in Mexico for water monitoring?
DK: In Mexico, the company focuses mainly on our Life Sciences vertical. Today, water in pharmaceuticals is about efficiency, so companies in that sector are looking at process analytical technology (PAT), Pharma 4.0 and lean manufacturing. Pharmaceuticals are always looking to decrease costs and increase profitability. To do that, you need to look at all areas to increase efficiency and quality. We work with our analytical instruments on water systems to ensure they meet quality specifications before the water is used for any production requirements.
Ensuring that companies have a more efficient process will decrease costs and create overall higher quality pharmaceuticals and at a lower cost to customers. This is where we provide our instrumentation to meet four compendial requirements for the production of water for pharmaceutical purposes: TOC, conductivity, endotoxin and bioburden. Our analyzers display any contamination in water systems and in cleaned bioreactors used for production. This is what the company is focusing on from an instrumentation standpoint. On the software side, pharmaceutical companies want data that is accurate and actionable and they want it immediately, so Sievers’ biggest commitment has been the release of a new software product data aimed at obtaining information from all of our worldwide systems in one location so that pharmaceutical manufacturers can see real-time pharmaceutical water quality across parameters we measure, making data immediately accessible and actionable. If there is an issue with the water system, our customers will know immediately, ensuring the issue is solved promptly and that the impact on that batch is minimal, helping to decrease costs.
Q: How can water treatment and reuse become more economically viable and attractive for companies?
DK: Once technology development progresses, water use and reclamation will become cheaper. For example, desalination has not been popular because of its extreme cost, yet as technology continually improves, there is more and more innovation. For instance, we are witnessing that desalination is now affordable in large implementations, not only in California but in Singapore as well. At Sievers Analytical Instruments, we are continually innovating. We consider ourselves a high-tech company that invests in innovation, research and development. For instance, our first TOC unit was built for the international space station. One cannot pipe water into space, so it is self-contained at the international space station, meaning all water is reused. What one flushes down the toilet is what one eventually drinks because that is the only water available and that can be done safely by having very clean and direct purification methods.
In regard to pharmaceutical water reuse, the key is having attached wastewater treatment plants that will reuse water over time, instead of just dumping it back into the river. The pharmaceutical industry is generally more conservative and very slow to change, so we are going to start seeing more reuse in the next 10 years. The key today is to measure water quality and minimize waste.
GV: We help our clients find a simple solution so they can obtain an accurate analytical result and obtain higher quality and faster throughput.



Q: What is Atfil’s value proposition and how does the company stand out in the market?
A: With 10 years in the market, we manufacture low, medium and high-efficiency filters used by pharmaceuticals, medical devices manufacturers, hospitals and other life sciences companies in need of clean rooms. Our hight efficiency HEPA filters offer 99.97 percent in 0.3 micron minimum efficiency, which is among the highest rates for these products. Our manufacturing processes give us the flexibility to produce any type of air filter in the market, in accordance with the needs of our clients, this is the most valuable differentiator we have as company, in addition to these strengths, all our products are high-capacity, durable solutions, reducing the energetic cost of the air filtration systems. This provides further control of the manufacturing process in industries such as pharmaceuticals, which have several filters running continuously.
Atfil identified that local pharmaceutical companies needed high-efficiency filters, in different sizes, critical for their process, and the previous suppliers did not have the tech to manufacture Hight efficiency HEPA filter, which are an expensive part of the manufacturing process. We developed the machinery that now allows us to manufacture our own products for some of Mexico’s most important care providers. To date, we have around 60 specialized, tech-embedded original filtering products, all of them certified by an international lab, also we have a lab where we certified the products one by one, necessary by the criticality of the product itself.
Q: During the COVID-19 pandemic, Atfil supported Mexico City by producing N95 masks. What motivated this work and what were the results?
A: Alongside UNAM, we were able to participate and win this tender due to our engineering and experience in develop Hight efficiency filters. Once we won the project, we were able to build production lines for mass mask manufacturing in five weeks, meeting all of COFEPRIS’ requirements. This was a large investment risk for the company but we were able to tackle it successfully and balance our regular production with the masks project.
Early in the pandemic, Mexico had a N95 mask shortage caused by global supply shortages. Atfil was the only high efficiency filtration expert able to overcome this shortage thanks to our solid supplier base, which allowed us to source the necessary raw materials.
Q: What product and services changes did Atfil introduce as a result of the pandemic?
A: Our clients in the hospital and pharmaceutical segments require strict filtering control in their room management and during the COVID-19 pandemic this filtering process suffered many changes that altered the supply chains of filtering materials, which are 100 percent imported. Supply remained stable during the first year of the pandemic but during the second year, manufacturing components started to become scarce as global companies began prioritizing other materials. The latter allowed us to diversify our suppliers and avoid shortages for our clients, which, coupled with preventive measures to avoid running out of supplies, helped us and our clients maintain smooth operations.
José Antonio Altamirano CEO | Atfil
Consider these four tips to increase your ability to make a decision and stick to it, which is the cornerstone of good leadership. McKinsey research shows that executives on average spend almost 30 percent of their time making decisions. This means that they must be efficient and effective in order to make the most of their time while managing the business.
1. Evaluate the benefits your decision will bring to the business I recommend you make a list that includes the benefits, risks, advantages, disadvantages, and criteria that you must take into consideration when making the decision. The pandemic has worn people out, leaving many feeling tired and overwhelmed in the grips of decision fatigue, so I suggest you make these evaluations in a quiet environment. Evaluate the company, its values and objectives; once you have completed this, you will get your answer.
In The 7 Habits of Highly Effective People, Stephen Covey’s sixth habit is to, “Seek First to Understand, Then to Be Understood.” The human factor plays an important role in decision-making. Listen to others, listen with an open heart and mind to the different opinions and perspectives of the people you trust most on your team. Not only will this guide you to make the best decision but it will also help you see the situation from different angles. Also, have empathy when listening to another person’s point of view and actively engage with them during the discussion. By doing so, we can find common ground and build solutions that are mutually beneficial. As Dr. Maya Angelou once said, “People will forget what you said. People will forget what you did. But people will never forget how you made them feel.”
I’m sure that businesspeople or entrepreneurs have asked for your opinion before doing something. When faced with a tough choice, ask yourself, “What would I say to a friend or colleague who had this problem?” Surely, it will be easier for you to make a decision. That happens when you offer wisdom to another person; you are more objective and less negative.
Developing kinder self-talk takes practice but when you make self-compassion a daily habit, your decision-making skills will improve. A good leader needs to be able to make hard decisions and stand by them. We must ensure that the choices made are the best ones for our company and that they enable the organization to move in the right direction. Effective decisions save time and propel work projects forward, increasing employee productivity.
When you are a leader, making difficult decisions is part of the job. What I’ve noticed throughout my career is that the best leaders tend to “own” their decisions. That is, they stand behind them and let people know that they are the one who made the call, and they will take the heat from those who may not like it. Taking ownership of a decision means sticking with it once it’s made.
These four tips have allowed me to lead with kindness by taking everyone’s viewpoint into account, digest what they have put forward, balance emotion with reason, and then behave like a true leader and make the final decision. The result is increased trust and loyalty from my team.


From the chemical sector to the pharmaceutical industry, Powder Transfer Systems guarantee compliance with the highest sanitary standards of raw material manipulation throughout the manufacturing processes of final products for both human use and consumption. From accurately transferring and dosing powder from milligrams to tons, grinding materials from microns to millimeters or mastering high-mixing requirements, Dec provides trend-setting solutions for contained, sterile and safe manufacturing conditions to a number of industries, from chemicals and pharmaceuticals to cosmetics and those that apply special materials in areas such as battery manufacturing processes or in the nuclear industry.
As a specialist in powder handling, Dec’s registered technology, PTS Powder Transfer System®, provides innovative solutions for automated transfer, dosing and packaging of powders by means of vacuum and pressure. With its unique filtration concept, PTS is the only vacuum dense-phase system that functions at optimum levels when handling ultrafine, sticky and adhesive powders. Dec’s PTS technology enables active powder management for safe reactor loading and efficient powder handling. It is also considered a dust-free system that is easy to clean and safe when handling toxic, explosive or very low MIE dust. As such, it can also transfer large varieties of powders, from a few kilos to tons, while maintaining a containment level of <1 μg/m3. This system can be used during any stage of production throughout the plant to handle raw materials, intermediates or final products. Moreover, powder can be transferred over long distances, allowing greater flexibility in plant design.

One of the major advantages of PTS technology is that it separates air from powder, keeping the receiving vessel inert during the charging operation. Therefore, it is possible to safely charge powder into a reactor that contains solvents or that is pressurized without the risk of explosions. Other notable benefits are its dustfree filling and discharging, packaging and dosing. In addition, there is neither product retention nor particle damage, it is easy to clean (CIP device) and it has a mobile unit available. The CIP device allows for a complete cleaning of the powder line and PTS through a speed cleaning time of up to two minutes. It also has automatic drying of between 15 and 20 minutes with the possibility of sterilization. The system is fitted with a liquid separator component that sucks liquids into the system and a float located in the main cover prevents the liquid from entering the vacuum line. The PTS body and the powder transfer hose are cleaned at the same time, which is a considerable advantage compared to using a spray nozzle.
Dec also offers the Mobile PTS, including all the features of the static system but with the additional benefit of being portable. The system can be dismantled and relocated anywhere in the production unit. The control panel and vacuum pump remain permanently mounted on the trolley while the PTS can be installed on the process equipment to be charged.
Dec’s PTS offers full processing flexibility, tailored to customer needs. At the core of Dec’s Powder Handling Excellence, the PTS encompasses a broad range of applications:
+ Standard and high containment filling and discharging. In combination with Dec’s Drum Containment System, the PTS provides a safe solution for filling or emptying big bags and drums.
+ Small quantity dosing. Accurate and repetitive volumetric dosing of small quantities of powder ranging from 1mg to 100g.
+ Single and multiple reactor charging. Safe and reliable vessel charging; the oxygen is removed from the powder before entering into the process.
+ Blending. PTS Batchmixer for fully contained homogeneous powder blending.
+ Filling and packaging facilities. Continuous Liner System for optimized GMP compliant packaging solutions enabling high containment levels (< 1μg/ m3). In combination with the PTS and the Dosivalve, this system allows for any equipment discharging and precise dosing into drums/containers.
To correctly achieve powder system management, Dec supports its PTS with the MC Jetmill® system, Dec’s fourth-generation jet mills, which have been re-designed from the ground up using “Smoothflow Jet Technology” to develop and build new micronizing equipment that can deal with the most difficult products, from sticky to hard and from brittle to soft, while minimizing blowback and product build-up, which includes the use of alternative materials. This range is supplied in accordance with the cosmetic Good Manufacturing Practices (GMP) guidelines based on ISO 22716:2007. Dec’s jet mills can be fabricated with different materials depending on the physical properties of the product to be micronized (stickiness, hardness, Mohs scale > 6, etc.).
The MC Jetmill micronization allows for a Narrow Particle Size Distribution (PSD), has simple and rapid assembly/disassembly, a limited number of components and high yields with a low energy consumption and sterile manufacturing.

3PLs T hird Party Logistics
AHM M exican Healthtech Association
AMELAF M exican Association of Pharmaceutical Laboratories
AMID M exican Association of Innovative Industries of Medical Devices
AMIIF M exican Association of Pharmaceutical Research Industries
ANAFAM N ational Association of Drug Manufacturers
API Ac tive Pharmaceutical Ingredient
ASEM M exican Entrepreneur Association
AWS Ama zon Web Services
BMJ B ritish Medical Journal
BSCI B oston Scientific
B2B B usiness to Business
B2C B usiness to Consumer
CANIFARMA N ational Chamber of the Pharmaceutical Industry
CBD C annabidiol
CBCISS B asic Table and Catalog of Health Sector Supplies
CKD C hronic Kidney Disease
CINVESTAV C enter for Research and Advanced Studies of the National Polytechnic Institute
CIEP C enter for Economic and Budget Research
COFECE F ederal Commission of Economic Competition
COFEPRIS F ederal Commission for Protection Against Sanitary Risks
COLMEX C olegio de México
CONACYT N ational Council for Science and Technology
CONEVAL N ational Council for the Evaluation of Social Development Policy
CSG G eneral Health Council
CRO C linical Research Organization
CTE C ritical Tracking Event
DRP
DTP
irect From Patient
irect to Patient
DSCSA D rug Supply Chain Security Act
ECR E lectronic Clinical Record
EMA E uropean Medicines Agency
EMR E lectronic Medical Record
ENARM E xam of Candidates to Medical Residences
ENSANUT N ational Survey of Health and Nutrition
EPCIS E lectronic Product Code Information Services
EPOC Ch ronic Obstructive Pulmonary Disease
Eu ropean Union
EY
rnst & Young
FDA F ood and Drug Administration
FIFARMA L atin American Federation of the Pharmaceutical Industry
FONDEAGG Ana cleto Guerrero Guajardo Educational Fund
Funsalud M exican Health Fundation
GDST G lobal Dialogue on Seafood Traceability
GMP G ood Manufacturing Practices
GHI G lobal Health Intelligence
HIV H uman Immunodeficiency Virus
HTA H ealth Technology Assessments
HL7 H ealth Level 7
HEPA H igh Efficiency Particulate Air
IBM I nternational Business Machines Corporation
ICU I ntensive Care Unit
ICH I nternational Council for Harmonization of Technical Requirements for Pharmaceuticals for Human Use
IFPMA I nternational Federation of Pharmaceutical Manufacturers & Associations
IMPI M exican Institute of Industrial Property
IMSS M exican Institute of Social Security
INCIDE I nnovation and Science for Business Development
INCMNSZ T he National Institute of Medical Sciences and Nutrition Salvador Zubirán
INDRE E pidemiologic Diagnostics and Reference Institute
INEGI N ational Institute of Statistic and Geography
INGER N ational Institute of Geriatrics
INMEGEN N ational Institute of Genomic Medicine
INSP N ational Institute of Public Health
INSABI H ealth Institute for Welfare
IP I ntellectual Property
IPN N ational Polytechnic Institute
ISSSTE I nstitute of Safety and Social Services for Federal Workers
ISPOR P rofessional Society for Health Economics and Outcomes Research
LAASSP T he Public Sector Acquisitions, Leases and Services Law
LLYC L lorente y Cuenca
JBD J ournal of Big Data
KDE Key Data Element
MBN M exico Business News
MSD M erck Sharp & Dohme
NAFTA N orth American Free Trade Agreement
CNCD Ch ronic Non-Communicable Diseases
NCD N on-Communicable Disease
NOM M exican Official Norms
NSF N ational Safety in Food
OECD O rganization for Economic Cooperation and Development
OR O perating Room
OTC O ver the Counter
PAI P rotocols of Integral Attention
PAT P rocess Analytical Technology
PTG P ackaging Technology Group
PAHO Pa n-American Health Organization
PAMO P harmacy-Adjacent Medical Offices
PACS P icture Archiving and Communication System
PCR P olymerase Chain Reaction
PEMEX P etróleos Mexicanos
PPP P ublic-Private Partnership
RIS R adiology Information System
RWE R eal World Evidence
RWD R eal World Data
R&D R esearch and Development
SCT M inistry of Communications and Transportation
SEDENA M inistry of National Defense
SEDESA M inistry of Health of Mexico City
SEMAR M inistry of the Navy
SME S mall-Medium Enterprise
SMEO M exican Society of Oncology
SMSP M exican Society of Public Health
SSA M inistry of Health
STEM Sc ience, Technology, Engineering and Mathematics
SOP S tandard of Procedure
TD Tetanus and Diphtheria
UNAM N ational Autonomous University of Mexico
UNEMES M edical Specialties Units
UNEP U nited Nations Environment Program
UNICEF U nited Nations Children’s Fund
UNOPS T he United Nations Office for Project Services
UNDP U nited Nations Development Program
USMCA U nited States-MexicoCanada Agreement
WHO World Health Organization
WIPO World Intellectual Property Organization
AMIIF 13, 116
Breakthrough IP 71, 116
CANIFARMA 12, 116
Central Media 57, 116
CIEP 15, 21, 116
Closing the CNCD Care Gap Exacerbated by COVID-19 63
CMinds 38
CRO Mexicana 74
Deloitte 19, 116
Digitalization Must Be at the Center of Healthcare 34
DOC24 29, 116
DocTour 37, 116
DoHealth 54
Ecolab 73, 116 elery 48, 116
Event Highlight: Financing Care: Role of Public Coverage in Health Expenditure 16
Farmacias del Ahorro 67, 116
Funsalud 9, 116
Genetic Services by SOHIN 56
Global Health Intelligence 44, 116
Grupo SOHIN 35, 116
Mexico
Olivares
Healthtech
Mexico
Health Gorilla 36, 116
HempMeds 72, 116 INCMNSZ 64, 116 IQVIA 45, 116 LLYC 18, 116 Medikit 32, 116 Nosotrxs 20, 116 nutriADN 55, 116 PharmaAdvice 46 Pragmatec 70, 116 Salúd Fácil 66, 116 SEDESA 11, 116 SocialDiabetes 23, 31, 116 Sociedad Mexicana de Salud Pública 10 Sofía 68, 116, 117 Tecnológico de Monterrey 53 Tech, Patient Experience to Shape the Hospital of the Future 43
Technology Improves Medical Education but Can Create Gaps 51 TecSalud 52, 116 TuoTempo 30, 116 WeeCompany 28, 116
Mexico Health Review 60 Siemens 77 Eolis 96
Pharmaceuticals
ayer
exico Business
oston
de Mexico
Masimo
Siemens AG
M edGlobal Group
M edGlobal Group
Art-Técnica
G obierno de Mexico
exico Business
old Chain Technologies
obierno
Mexico
Senior Journalist & Industry Analyst: Miriam Bello
Journalist & Industry Analyst: Antonio Gozain Journalist & Industry Analyst: Sofía Garduño
Editor: Alicia Arizpe
Editor: José Escobedo
Senior Editor: Mario Di Simine Managing Editor: Alejandro Salas
Industry Lead: Brenda Ramírez
Commercial Manager: Mirjam Schipper Content Partnership Coordinator: Mariana Rodríguez Content Partnership Manager: Miguel García
Junior Graphic Designer: Valeria Villanueva
Junior Graphic Designer: Paulina Quiroz
Senior Graphic Designer: Marcela Muñoz
Design Manager: Mónica López
Design Director: Marcos González Web Development: Omar Sánchez
Collaborator: Rodrigo Andrade
Director General: Jeroen Posma
© Mexico Business Publications S.A. de C.V., 2022. This annual publication contains material protected under International, US and Mexican Laws, as well as international treaties. Any unauthorized reprint or use of this material is prohibited. No part of this book may be reproduced or transmitted in any form or by any means, electronic or mechanical, including photocopying, recording or by any information storage and retrieval system without express written permission from Mexico Business Publications S.A. de C.V. Mexico Health Review is a registered trademark.
The publisher has made all reasonable efforts to provide accurate information and the information contained in this publication is derived from sources believed to be true and accurate. However, the information in this publication should not be considered to be complete or definitive and may contain inaccuracies or typographical errors. The publisher accepts no responsibility regarding the accuracy of information and use of such information is at your own risk. The publisher will not be liable to any party for any direct, indirect, special or other consequential damages arising from any use of information in this publication. The publisher provides no representations or warranties, express or implied, including any implied warranties of fitness for a particular purpose, merchantability or otherwise in relation to any information provided by the publisher in this publication.
